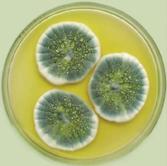

БЕРЕЗЕНЬ 2023

2023, березень
ЄРЬОМЕНКО Римма Фуатівна — доктор біологічних наук, професор, завідувачка кафедри клінічної лабораторної діагностики Національного фармацевтичного університету
2023 / березень
ЗМІСТ ПУЛЬС ЧАСУ
04 Лікарі на власні очі побачили, як виготовляються українські ліки: «Таке враження, що я побував десь у Японії, а не в Україні»
07 Acino виступила партнером проєкту «Мобільні госпіталі для перемоги»
08 Історія незламності і служіння людям: «Аптека Центральна №1» у м. Харків знову працює!
10 Вивчити світ фармрітейлу і пізнати реальні бізнес-кейси: чому молодь обирає початок кар’єри із Подорожник START
12 Психоделіки для лікування тяжких психічних станів: від «магії» до реальності
14 Всесвітній тиждень знань про мозок
16 Новий тест для визначення респіраторних інфекцій
18 «Фармак» представив свої ліки на Європейському конгресі радіології у Відні
19 «Фармак» визнано компанією із найкращою репутацією серед фармвиробників та імпортерів України
20 Ліки від ревматоїдного артриту знижують ризик
виникнення серцево-судинних захворювань
30 Перші дні, тижні і місяці війни: історії фармацевтів-героїв Харкова

36 Декасан® — інгаляційна протидія вірусам та бактеріям

42 Аваналав на варті відновлення сексуального здоров’я
46 Алергія на амброзію: агресивність пилку визначається місцем його походження та навколишнім середовищем
АРСЕНАЛ ЗНАНЬ



49 Доппельгерц — надійний спосіб врятувати гаджетомана
53 МОЗ розширює електронний рецепт на всі рецептурні препарати


54 На допомогу фахівцю: Як ефективно лікувати кашель
60 Хвороби королів чи прокляття династій? Історичні нариси
64 Як пережити передменструальний дисфоричний розлад?
66 Очні краплі «Хіло-комод» — незамінний помічник в
лікуванні синдрому сухого ока
72 Вдома краще: Як впоратися з непростими почуттями
У ФАРВАТЕРІ 75 Лікування безпліддя: з досвіту ніжинського міського пологового будинку 87 В чому користь фіолетових овочів та фруктів? 88 Обмеження калорій уповільнює темпи старіння
06 Доповнено державну фармакопею України
23 Кардіопротекція в сучасній кардіології та раціональний підхід до вибору препарату ГАЛУЗІ У СВІТІ МЕДИЦИНИ 82 Донорство крові: чому це важливо 78 Вчені, що розпочали нову еру репродуктивних технологій
c.04
ЧАСУ:
Лікарі на власні очі побачили, як виготовляються українські ліки
c.06
Доповнено державну фармакопею України
c.07
Acino виступила партнером проєкту «Мобільні госпіталі для перемоги»
c.08
Історія незламності і служіння людям: «Аптека Центральна №1» у Харкові знову працює!
c.10
Вивчити світ фармрітейлу і пізнати реальні бізнес-кейси: чому молодь обирає початок
кар’єри із Подорожник START
c.12

Психоделіки для лікування тяжких психічних станів: від «магії» до реальності





c.16
Новий тест для визначення респіраторних інфекцій

c.18
«Фармак» представив свої ліки на Європейському конгресі радіології у Відні Nil volenti difficile est



Немає нічого важкого, якщо є бажання

ПУЛЬС
НОВИНИ І ПОДІЇ ПУЛЬС ЧАСУ: НОВИНИ І ПОДІЇ
як
виготовляються українські ліки:
«Таке враження, що я
побував десь у Японії,
На фото: цех із виробництва асептичних лікарських засобів у ампулах і флаконах
Повномасштабне вторгнення росії докорінно змінило світогляд українського суспільства.
Нав’язані пострадянською ментальністю тези меншовартості та «недорозвинутості» відступили перед прагненням українців дізнаватися якомога більше про власну країну, її сильні сторони та потенціал.
Так, фармацевтична компанія «ФАРМАК» руйнує закоренілі міфи про українську фармацевтику зсередини, демонструючи лікарям процеси створення сучасних ліків на новітньому обладнанні.



«Таке враження, що я побував десь у Японії, а не у нас в Україні», — розповідає Євген Люлька, кардіохірург Полтавського обласного кардіоваскулярного центру.
Фото: дільниця із виробництва біотехнологічних активних фармацевтичних інгредієнтів
Фото: група лікарів на дільниці пакування твердих лікарських засобів (таблетки, капсули, драже, саше)
Від початку року понад 100 лікарів із Чернігова, Полтави, Сум, Конотопу, Пирятина, Кременчука, Броварів та Києва відвідали виробництво і лабораторії контролю якості заводу «ФАРМАК», та на власні очі побачили процеси створення готових лікарських засобів у різних формах.
Під час екскурсії лікарі дізналися, що «ФАРМАК» як найбільше фармацевтичне підприємство України за рік проходить близько 10 українських та міжнародних перевірок, а також має сертифікати відпо-
Лікарі на власні очі побачили,
а
не в Україні»
4 Журнал «Сучасна фармація» • modern-pharmacy.com.ua • 2023 / березень • Пульс часу • Пульс часу
відності виробництва та лабораторій всім вимогам Євросоюзу – GMP ЄС (Good Manufacturing Practice, Належна виробнича практика).


Компанія купує сировину у перевірених постачальників із США, Японії, Італії, Німеччині, Іспанії, Індії, Китаю тощо. Кожна партія сировини проходить суворий вхідний контроль якості. Також кожна партія готових лікарських засобів проходить мінімум 5 етапів контролю та відправляється одразу в декілька лабораторій, де її якість перевіряють за чітко визначеним переліком показників. У цілому лабораторії заводу «ФАРМАК» володіють 135 різними методами випробувань, що затверджені провідними фармакопеями світу – Європейською, Британською та Фармакопеєю США.
«Я приємно здивований масштабністю
та сучасністю виробництва
«Фармак», суворими стандартами
якості і пишаюся, що такі компанії
є у нас в Україні», – зазначає
Юрій Гольованьов, сімейний лікар
Консультативно-діагностичного
центру №1 м. Бориспіль.
Усі процеси на виробництві максимально автоматизовані на діджиталізовані. До виготовлення і контролю якості лікарських засобів залучено високотехнологічне обладнання, що виготовляється у ЄС.
Загалом на підприємстві функціонують 25 виробничих дільниць, одну з яких — для виготовлення ліків у небулах — відкрили вже під час повномасштабного
вторгнення ворога.
Кожного року «ФАРМАК » інвестує приблизно 100 млн гривень у забезпечення контролю якості продукції: закупівлю реактивів та матеріалів для проведення досліджень. А також реінвестує понад 90% від прибутку у посилення власних виробничих потужностей. Війна не стала приводом зупинити інвестиції. Так, у 2022 році у дослідження та розробку нових ліків компанією вкладено понад 400 млн гривень.
Сьогодні «ФАРМАК» є лідером фармацевтичного ринку України за обсягами продажу лікарських засобів*. На заводах у Києві та Шостці Сумської області компанія виробляє близько 400 найменувань протизастудних, ендокринологічних, гастроентерологічних, кардіологічних, неврологічних та інших лікарських засобів. Ці ліки експортуються до понад 50 країн світу, в тому числі Швейцарії, Великої Британії, Данії, Польщі і Франції.
Компанія продовжує запрошувати лікарів на екскурсію підприємством на постійні основі. Записатися можна через електронну пошту info@farmak.ua
Он-лайн екскурсію виробництвом «ФАРМАК» можна відвідати на сайті компанії.
* - за даними Proxima Research станом на березень 2023 року
Фото: група лікарів спостерігає за процесом виробництва рідких асептичних лікарських засобів
Журнал
фармація» •
• 2023 / березень • Пульс часу • Пульс часу 5
«Сучасна
modern-pharmacy.com.ua
Нове, шосте, доповнення до другого
видання Державної Фармакопеї України (ДФУ) затверджено наказом Міністерства
охорони здоровʼя України від 17.02.2023
р. № 313, яке вводиться в дію з 1 березня 2023 року.
У ДФУ 2.6 продовжено основні напрями розвитку, викладені в попередніх виданнях. Це введення нових текстів й актуалізація вже наявних, згідно з розділами ДФУ.
До розділу 2.6 «Біологічні випробування» введено 3 нових статті і 7 статей актуалізовано. Ці статті було узгоджено з поточною редакцією Європейської Фармакопеї.
У ДФУ 2.6 введено додаткові реактиви, які підтримують нові монографії, розділи «Інтегральний тест для перевірки аналітичної системи і кваліфікації персоналу для методу спектрофотометрії» та «Потужність статистичного критерію» з прикладами їх застосування.
Значних змін зазнали тексти на біологічні лікарські засоби — зокрема, стаття 5.2.5 «Управління сторонніми агентами в імунобіологічних лікарських засобах для застосування у ветеринарній медицині» та стаття 5.14 «Лікарські засоби, переносники генів для застосування людиною».
Додано загальні національні монографії «Косметична продукція», «Мезенхімальні стовбурові клітини для застосування людиною» та «Мезенхімальні стовбурові клітини для застосування у ветеринарній медицині», які дозволяють забезпечити стандарт підготовки та контролю мезенхімальних стовбурових клітин людини та тварин для використання в клітинній терапії.


За напрямом «Лікарська рослинна сировина та лікарські рослинні препарати» до ДФУ 2.6 введено 16 нових монографій (серед яких 9 національних)
і 23 актуалізовано. Загальна кількість монографій за цим напрямом у ДФУ становить понад 387 найменувань, з яких понад 70 — національні. Такий потужний банк монографій дозволяє надійно проводити стандартизацію цих об’єктів згідно вимогам Європейської Фармакопеї з урахуванням національної специфіки.
До розділу «Фармацевтичні препарати, виготовлені в аптеках» ДФУ 2.6 було введено загальну монографію «Екстракти водні, виготовлені в аптеках», яка розроблена Фармакопейним центром за участю колективу провідних фахівців Національного фармацевтичного університету.

ДФУ гармонізована з Європейською Фармакопеєю, що відповідає курсу України на інтеграцію до Європейського Союзу. Тому загальні статті та монографії ДФУ складаються із двох взаємозалежних частин — європейської, ідентичної відповідній статті Європейської Фармакопеї, і національної, що враховує специфіку сучасного стану фармацевтичного виробництва України.

НА ЗАМІТКУ!!!
Державна Фармакопея України — це правовий документ, що містить загальні вимоги до ліків, монографії, а також методики контролю їх якості (Закон України «Про лікарські засоби», стаття 2). ДФУ має законодавчий характер. Її вимоги, що висуваються до ліків, є обов’язковими для всіх підприємств та установ України незалежно від їх форми власності, які виготовляють, зберігають, контролюють і застосовують лікарські препарати.
За матеріалами офіційного сайту Державної служби України з лікарських засобів та контролю за наркотиками https://www.dls.gov.ua
6 Журнал «Сучасна фармація» • modern-pharmacy.com.ua • 2023 / березень • Пульс часу • Новини
ДОПОВНЕНО ДЕРЖАВНУ ФАРМАКОПЕЮ УКРАЇНИ
Acino виступила партнером проєкту
Швейцарська фармацевтична компанія Acino
стала партнером проєкту з забезпечення
прифронтової зони та зруйнованих лікарень в областях надсучасними мобільними
госпіталями для надання невідкладної
допомоги пораненим.
ACINO відвантажила у пілотний медичний комплекс на колесах 1600 упаковок лікарських засобів власного продуктового портфелю на загальну суму 150 тисяч гривень. Зокрема, це препарати, що використовуються у неврології, психіатрії, кардіології та терапії.
Проєкт започатковано благодійною
організацією «Благодійний фонд реконструкції і розвитку України», в межах якого заплановано придбання 52-х мобільних госпіталів. Вартість одного такого медичного комплексу на колесах складає 240 тис євро. Всього до проєкту долучилися 14 організацій як в Україні, так і за кордоном.

Компанія планує забезпечувати лікарськими засобами і наступні мобільні госпіталі у межах даного проєкту. Про це заявив Євген Заїка, генеральний директор ACINO в Україні, голова наглядової ради «Фарма Старт», під час презентації проєкту, що відбулася наприкінці 2022 року в КВЦ «Парковий», Київ.


МОБІЛЬНИЙ ГОСПІТАЛЬ — це спеціалізована розробка, що являє собою повноцінну лікарню на колесах, яка оснащена найсучаснішим медичним обладнанням:
приймальня — гідравлічна оглядова кушетка, акумуляторні оглядові лампи на коліщатах, офтальмоскоп, інструментальний стіл, урни;
лабораторія — автоклав, центрифуга для крові, центрифуга для сечі, морозильна камера, оглядова кушетка, оглядова лампа, глюкометр електронний, гематологічний аналізатор, гемоглобінометр, термозварювач для стерилізації пакетів, мікроскоп, холодильник комерційний;
рентген кабінет — рентгенівський стіл, рентгенівський та ультразвуковий апарати, засоби захисту, коробки рентгенівського перегляду; операційна кімната — дефібрилятор стаціонарний, апарат для діатермії, портативні інфузійні насоси, інструментальні столи, ларингоскоп, операційний стіл, лампи для безтіньового світла з акумуляторами, аспіраційний насос, анестезіологічний апарат, відра для сміття, табурет регульований зі стінкою, реанімаційний візок; технічна кімната, туалет та душ.
Мобільний госпіталь має підвищену прохідність та власний генератор, що дозволяє йому працювати абсолютно автономно. Одночасно в мобільному госпіталі може працювати дві команди медиків з можливістю рятувати до 100 життів в день, виходячи із принципу «золотої години». За необхідності і за умови достатньої забезпеченості медиками госпіталь може надавати допомогу і більшій кількості пацієнтів.
Нагадаємо, ACINO від перших днів повномасштабної війни підтримує населення та державу. Від 24 лютого компанія спрямувала на гуманітарні цілі вже понад 67 млн грн. Це понад 200 тис. упаковок лікарських засобів у лікарні й шпиталі та більше 8 млн гривень на підтримку ЗСУ, МОЗ України та благодійних організацій. На початку 2023 року ACINO було відзначено подякою Президента України за підтримку України та українського народу у вирішальну мить.

Журнал «Сучасна фармація» • modern-pharmacy.com.ua • 2023 / березень • Пульс часу • Події 7
«Мобільні госпіталі для перемоги»
23 грудня 2022 року символ Аптечної мережі
9-1-1 — «АПТЕКА ЦЕНТРАЛЬНА №1» відсвяткувала
свій другий день народження. Її 23-річна історія без-
доганної роботи могла завершитись 2 березня 2022
року, коли в Палац праці у Харкові влучила ворожа ракета. Однак аптеку відбудували і вона знову обслуговує харків’ян і гостей міста.
Палац праці на Майдані Конституції вперше
відкрив свої двері у 1916 році і став справжньою
окрасою міста. Цей архітектурний шедевр створив Іполіт Претро всього за два роки. Палац пережив період радянщини і Другу світову війну. Навіть у німецьких фашистів не піднялася рука знищити історичну пам’ятку. А росіяни випустили на сьомий день війни ракету, яка перетворила Палац на руїни. Аптечна мережа 9-1-1 планувала зробити в цій аптеці музей історії вітчизняної фармації. Однак ніхто не міг уявити, що в цій історії будуть криваві сторінки.
РОБОЧИЙ ДЕНЬ, ЯКИЙ ЛЕДВЕ НЕ СТАВ ОСТАННІМ
«Аптека Центральна №1» з 1999 року обслуговувала харків’ян. Вона стала візитівкою Аптечної мережі
9-1-1 завдяки своїй бездоганній репутації. Коли розпочалося повномасштабне вторгнення, аптека не зачинилася попри те, що працівники роз’їхалися.
Керівництво мережі звернулося до фармацевтів
компанії і попросило вийти на роботу в «Аптеку Центральна №1», бо пацієнти йшли сюди за ліками з усього Харкова.
2 березня був звичайний робочий день. Навкруги лунали вибухи, але фармацевти обслуговували пацієнтів і приймали товар.
«Волонтери доставили нас в «Аптеку Центральну №1». Ми переодягнулися, познайомилися з людьми, які там вже приймали товар, і стали до роботи, — згадує ті страшні події Яна Стрілець, завідувачка однієї з харківських «Аптек оптових цін», яка того дня серед інших долучилася до допомоги колегам в «Аптеці Центральній № 1» і стала свідком атаки. — Десь за годину почався справжній жах. Аптеку завалило, стеля впала,
все засипало уламками, пилом, упаковками з ліками. Вибило вікна та двері. Я приймала товар за другою касою і в одну мить опинилася на підлозі. Другої каси, комп’ютера, ящика для грошей взагалі не було, прилавок з касою вибило і на мене почали падати ящики з ампулами.
Коли прийшла до тями, спробувала вилізти з-під прилавка та уламків ампул. Помітила, що з голови хлинула кров. Я закрила рану рукою і закричала. У той момент я благала Бога, щоб усі були живі! Я розшукала свого чоловіка і ми, перелізаючи через завали, побігли в дитячий зал. Там на нас чекала найстрашніша у моєму житті картина: на підлозі лежали наші колеги Людмила Потабрик та Ніна Жук! Їх завалило дверима та вибитою стіною зі стелею. Разом з іншими колегами ми підняли ті двері, щоб допомогти жінкам. Потім викликали «швидку»…»
Усі троє наших фармацевтів, які опинилися в той день в «Аптеці Центральній №1» залишилася живими, але ще певний час лікувалися і відновлювали здоров’я.

ІСТОРІЯ НЕЗЛАМНОСТІ І СЛУЖІННЯ ЛЮДЯМ:
8 Журнал «Сучасна фармація» • modern-pharmacy.com.ua • 2023 / березень • Пульс часу • Пульс часу
«Аптека Центральна №1» у м. Харків знову працює!
Довелося лікувати і аптеку, яка на початку березня перетворилася на поле бою. Тут зробили капітальний ремонт, встановили нові меблі, техніку. Але найголовніше – аптека дійсно стала музеєм. Музеєм незламності мережі «9-1-1». На стінах розвісили фотографії, щоб відвідувачі бачили, що довелося пережити нашим фармацевтам 2 березня.




«Ми зайшли в повністю порожній аптечний зал 14 грудня, розповідає нова завідувачка «Аптеки Центральної №1» Надія Ковальова. — Ще продовжувався дрібний ремонт, але вже завозили меблі і товар. Ми безперестанку прибирали, приймали і розставляли препарати на поличках… Справ було безліч».
У відновленій аптеці працюють разом
з завідувачкою шестеро людей. Вони
не побоялися вийти в аптеку, яка вже одного

разу постраждала від ворожого обстрілу.

Вони розуміли, що аптека має працювати
попри небезпеку — харків’янам потрібні ліки!
«Люди, які проходили повз аптеку, коли ми готували її до відкриття, махали нам руками, вітали і дякували. Навіть представники фармацевтичних компаній оцінили нашу сміливість, адже обстріли Харкова продовжуються і може в будь-який момент прилетіти. Боятися і сидіти у схованці — не наш формат! Я весь час в Харкові і працюю щодня. Ніколи не забуду, як в мою аптеку «Дешево» у 602 мікрорайоні прийшли «російські брати» з автоматами. От тоді я перелякалася не на жарт. А потім аптеку обстріляли. У той день ми не встигли вийти на роботу, і це врятувало нам життя, все сталося о дев’ятій ранку.
У березні я перейшла працювати в «Аптеку оптових цін» в районі залізничного вокзалу. Аптеку пограбували, у ній оселилися безхатьки. Довелося все прибирати і відновлювати роботу. Фармацевти боялися виходити на роботу в цю аптеку. Компанію мені склала Марія Денисенкова, яка переїхала з Чугуєва до Харкова, і ми всю війну працюємо разом.
Я щоранку їздила з передмістя від батьків на роботу. Працювали з моєю сміливою колегою, збирали з підлоги і розставляли на поличках ліки, які зносило вибуховими хвилями. Але не кидали людей напризволяще! Згодом поряд з залізничним вокзалом відкрили ще одну аптеку, а 20 липня мене попросили відкрити аптеку в селищі Жуковського. Там усі аптеки стояли зачиненими, район сильно обстрілювали, і харків’янам доводилося скрутно. Не всі мали змогу за станом здоров’я ходити містом у пошуках необхідних ліків. Не всім по кишені було винайняти таксі, тому наша аптека стала справжнім порятунком. Люди навіть плакали від щастя, дякували за те, що ми не побоялися вийти на роботу.


Коли мені запропонували стати завідувачкою в «Аптеці Центральній №1», я не вагалась ні хвилини. Сюди ж зі мною прийшла і Марія Денисенкова, перевірений боєць фармацевтичного фронту. Працювати в героїчній аптеці на Площі Конституції, 1 для нас була велика честь!»
Відкриття відновленої аптеки стало святом і для містян, і для працівників. Відвідувачі заходили, роздивлялися фотографії, дехто навіть витирав сльози. І щиро дякували фармацевтам, що їхня улюблена аптека знову працює.
ДРУГЕ ЖИТТЯ «АПТЕКИ ЦЕНТРАЛЬНОЇ №1» ТАК БУЛА ВІДКРИТА НОВА СТОРІНКА ІСТОРІЇ «АПТЕКИ ЦЕНТРАЛЬНОЇ №1» — ІСТОРІЇ НЕЗЛАМНОСТІ І СЛУЖІННЯ ЛЮДЯМ. Журнал «Сучасна фармація» • modern-pharmacy.com.ua • 2023 / березень • Пульс часу • Пульс часу 9
Вивчити світ фармрітейлу і
пізнати реальні
бізнес-кейси:
чому молодь обирає
початок кар’єри із
Подорожник START
Платформа можливостей для молоді «Подорожник
START» від найбільшої мережі аптек «Подорожник»
відкриває для студентів нові перспективи та початок кар’єрного росту. Це перша програма, що об’єднала
студентів різних спеціальностей у фармацевтичній
сфері. Зокрема, юристів, фінансових аналітиків, бухгалтерів, маркетологів, дизайнерів та інших.
ПОНАД
700
СТУДЕНТІВ
Понад 700 студентів по всій Україні вже покращили свої знання і отримали новий досвід. А близько 300 учасників програми знайшли роботу в компанії.
Підтримуючи амбітну молодь, мережа аптек «ПОДОРОЖНИК» започаткувала спільноту фармацевтів майбутнього, щоб разом з ними розвивати галузь. Керівниця платформи Марія Скринник розповіла, що ПОДОРОЖНИК START – це завжди про можливості та розвиток.
«Ми надаємо змогу студентам реалізовувати себе ще під час навчання. Вони бачать світ інакше, готові працювати та досягати нових вершин. За молоддю майбутнє нашої компанії. Адже ми створюємо можливості, а студенти
їх беруть. Як каже наш СЕО Тарас Коляда, все можливо! Тому саме у нас може себе реалізувати кожен, хто цього прагне», –розповіла Марія Скринник.
Керівниця платформи Марія Скринник
За її словами, головна мета платформи – надання можливості студентам застосувати теоретичні знання на практиці в найбільшій мережі аптек України. Адже ПОДОРОЖНИК зацікавлений у кваліфікованих спеціалістах.

В межах ПОДОРОЖНИК START молодь може зростати за горизонтальним або вертикальним типом кар’єри. Усе залежить від вибору та уподобань кожного учасника. Якщо обрати горизонтальний тип, то після практики чи стажування в одному відділі є можливості переходити в інші. За вертикаллю учасники обирають практику чи стажування в одному відділі компанії і саме в його межах рухаються кар’єрними сходами.
Один із стажерів Юрій Фіалка пройшов шлях у ПОДОРОЖНИКУ від студента до фінансового контролера. Він розповів, що свого часу для нього це стало унікальною можливістю.
10 Журнал «Сучасна фармація» • modern-pharmacy.com.ua • 2023 / березень • Пульс часу • Іновації
«Компанія дала мені значно більше, ніж я міг собі навіть уявити. Це безцінний досвід, можливість професійно розвиватися, вдосконалюватися, навчатися. Також це неймовірно крута команда розумних та надзвичайно талановитих людей.
Я можу впевнено сказати, що Подорожник став
для мене саме тим омріяним початком моєї
кар’єри», – сказав Юрій.
Історію свого успішного старту в ПОДОРОЖНИКУ розповів ще один учасник платформи Остап Моленда. Він почав стажування на посаді дефектаря.
«До моїх теоретичних знань, які я здобув в університеті, додались практичні навички під час стажування в найбільшій мережі аптек України «Подорожник». Саме це дало мені змогу рухатись далі й розвиватися у професії. За
власним досвідом, можу сміливо стверджувати, що Подорожник дає можливість студенту

здобути кваліфіковані знання та рухатись
тільки вперед. Ця компанія дійсно є лідером можливостей», – сказав Остап.
Власним досвідом стажування поділилась ще одна учасниця ПОДОРОЖНИК START – Маргарита . Перевагами участі в програмі вона назвала те, що у компанії працюють справжні професіонали, які надихають до розвитку та самовдосконалення.
«Вони готові ділитися своїм досвідом та
навчати, долати будь-які твої труднощі разом.
У Подорожнику не соромно й не страшно сказати «я не знаю», або «допоможіть, будь ласка», коли ти не знаєш, як вирішити те чи інше питання.
Під час стажування тобі дають можливість пізнати світ рітейлу, познайомитися із реальними бізнес-кейсами, брати участь в бізнес-процесах. Це мотивує і дуже заохочує», –розповіла Маргарита.
За її словами, мережу АПТЕК «ПОДОРОЖНИК» вона обрала для свого кар’єрного розвитку не просто так. Адже її особисті цінності повністю відповідають цінностям компанії. Маргарита рекомендує студентам, які шукають себе і можливості для реалізації, вдосконалюватися і наполегливо працювати.

Юрій Фіалка
Іновації
Маргарита
Остап Моленда
Платформа можливостей «ПОДОРОЖНИК START» співпрацює з понад 40 закладами вищої освіти України, щоб залучати студентів.

Пульс часу
•
2023 / березень
•
modern-pharmacy.com.ua

•
Журнал «Сучасна фармація»
• 11
ПОНАД 40 ЗАКЛАДІВ ВИЩОЇ ОСВІТИ
ДОЛУЧИТИСЬ ДО ПЛАТФОРМИ СТУДЕНТ МОЖЕ, ЗАПОВНИШИ ФОРМУ РЕЄСТРАЦІЇ. ТАКОЖ Є МОЖЛИВІСТЬ ПРИЙМАТИ УЧАСТЬ В ЗАХОДАХ, ЯКІ ОРГАНІЗОВУЮТЬ В МЕЖАХ ПРОГРАМИ: ВЕБІНАРИ, ТРЕНІНГИ, ОБІД З СЕО. ЩЕ ОДИН ВАРІАНТ ДОЛУЧИТИСЬ – ВІДГУКНУТИСЬ НА ЗАПИТ, ЯКИЙ РОЗСИЛАЮТЬ ПО НАВЧАЛЬНИХ ЗАКЛАДАХ .
Психоделіки для

лікування тяжких
психічних станів:
Психоделічні препарати здебільшого
заборонені в Європі, але нові дослідження показують, що у контрольованих умовах деякі з них можуть приносити користь.
На цьому тлі несподіваним є рішення регуляторних органів Австралії.

Стало відомо, що ліки, які містять психоделічні речовини 3,4-метилендиоксиметамфетамін (МДМА, широко відомий як екстазі) та псилоцибін (активний компонент «чарівних» грибів), незабаром будуть використовуватися в цій країні для лікування пацієнтів із посттравматичним стресовим розладом (ПТСР) та резистентною до терапії депресією відповідно. Це рішення робить Австралію першою країною у світі, яка офіційно визнала терапевтичне застосування цих двох психоделіків.
На думку деяких експертів, інші країни, зокрема США, можуть рухатися до аналогічного результату.

Однак наскільки це безпечно та які існують ризики?
Схоже, що Австралія може знайти певні відповіді на ці питання.
Психоделіки, як правило, стигматизовані та є незаконними в країнах Європи у зв’язку з побоюваннями
з приводу можливих шкідливих наслідків їх застосування. Однак в інших частинах світу цілющі властивості деяких психоделічних сполук давно визнані. Упродовж тисячоліть вони є частиною духовних і культурних церемоній. Інакше кажучи, імовірно, що певний лікувальний потенціал у цих сполук є, але наукової бази, яка б чітко його описала і систематизувала, недостатньо.
З одного боку, це логічно. Адже навіщо взагалі мати справу із загадковими психоделіками, якщо сучасна медицина має цілий арсенал уже вивчених і затверджених лікарських засобів. Насправді така потреба існує. Адже досить поширеними є ситуації, коли у пацієнтів з тяжкими психологічними розла-
дами схвалені підходи до лікування не працюють. Зокрема, йдеться про резистентний до терапії великий депресивний розлад.
Ця тенденція штовхає до пошуку нових підходів до терапії, серед яких застосування психоделіків виглядає досить обнадійливо.
David Badcock — генеральний директор британського консультативного комітету з питань наркотиків Drug Science, каже, що за останні 10 років дослідження в цій галузі відновилися. Основна мета комітету Drug Science — розглянути та дослідити наукові докази шкоди наркотиків без політичного втручання.
«У медичній спільноті зростає розуміння переваг такого лікування. Я сподіваюся, що це перша позитивна зміна з багатьох», — зазначив David Badcock.
На сьогодні в десятках досліджень, які проводяться в США і фінансуються з приватних джерел, а також у кількох випробуваннях, що проходять у Європі, вивчають біологічні механізми ефектів психоделіків, щоб їх можна було безпечно інтегрувати в суспільство. З’являється дедалі більше доказів того, що у контрольованих умовах деякі психоактивні речовини мають величезний терапевтичний потенціал. Особливо коли йдеться про вирішення серйозних проблем з психічним здоров’ям, що важко піддаються лікуванню, таких як ПТСР, великий депресивний розлад, алкоголізм та розлади харчової поведінки.
ВІД « МАГІЇ » ДО
12 Журнал «Сучасна фармація» • modern-pharmacy.com.ua • 2023 / березень • Пульс часу • Іновації
РЕАЛЬНОСТІ
У статті, опублікованій Європейською комісією (European Commission), зазначено, що кінцевою метою багатьох учених у цій галузі є декриміналізація психоделіків (як синтетичного, так і натурального

ПСИХОДЕЛІКИ: 99 КЛІНІЧНИХ
походження), а також створення безпечних протоколів, які дозволять психотерапевтам використовувати ці сполуки в медичних цілях.
ВИПРОБУВАНЬ У ФАЗАХ І - ІІІ

За даними GlobalData, налічується лише до сотні клінічних випробувань, що стосуються психоделічних засобів. Більшість із таких кандидатів — 49 — перебувають у середині шляху. Що стосується інших психоделіків, в цей час проводиться 27 поточних та запланованих випробувань фази I–III для діетіламіду лізергінової кислоти (ЛСД) та 31 дослідження для екстазі. Що ж, психоделічні препарати обтяжені важким культурним тягарем, який заважає пройти їм процес клінічної розробки з тією ж швидкістю, що й розробки «звичайних» ліків. Однак єдиний спосіб полегшити цей тягар — отримати надійні дані, які можуть розвінчати негативні уявлення про наркотики та, нарешті, довести цінність цього класу препаратів. І цілком можливо, що в частині з 99 випробувань вдасться досягти цієї мети.

НА ЗАМІТКУ!!!
ЦЕ ЦІКАВО!!!
Психоделіки мають довгу історію традиційного
використання в народній медицині та релігійних
практиках. Їх здатність впливати на сприйняття
використовувалася для фізичного і духовного
лікування. Психоделіки використовувалися людьми в шаманських і релігійних ритуалах, починаючи з доісторичних часів. В даний час в релігійних
цілях психоделіки використовуються, наприклад, індійцями Південної Америки та відомі під назвою ентеогени.
Перший інтерес до психоделіків в західній науці виник в середині-кінці XIX століття з початком
вивчення мескаліну. Після Другої світової війни психоделіки використовували як ліки, у тому числі, при лікуванні депресій. Потім, починаючи з 1960-х років, широко поширилося вживання психоделіків як наркотиків.
ВПЛИВ ПСИХОДЕЛІКІВ НА ЛЮДИНУ Психоделіки можуть бути надзвичайно небезпечні при необдуманому, необережному використанні, через здатність надзвичайно посилювати як позитивні, так і негативні емоції, думки, переживання, а також викликати дезорієнтацію, дереалізацію, деперсоналізацію та інші психотичні явища, особливо у неврівноважених і психічно нездорових людей. Деякі можливі ефекти психоделічних речовин: ілюзії; відчуття страху, депресія, ейфорія, умиротворення; можливі різкі переходи від одного стану до іншого; порушення координації рухів; слухові і зорові псевдогалюцинації; яскраві переживання подій минулого; тимчасове просторове порушення сприйняття навколишнього світу; ілюзорні неординарні здібності (наприклад, ілюзія телепатії).
Тож, нам залишається лише спостерігати за досвідом Австралії та робити раціональні висновки, які допоможуть у пошуку оптимальної терапії для певних категорій хворих. Адже на фоні війни поширеність тяжких психічних розладів стає дедалі болючішим питанням для України.
Журнал «Сучасна фармація» • modern-pharmacy.com.ua • 2023 / березень • Пульс часу • Іновації 13
ЗНАНЬ ПРО
МОЗОК
Щорічно, починаючи з 1995 року, у першій половині березня у світі відзначають Всесвітній тиждень знань про мозок (Brain Awareness Week), започаткований благодійною організацією Dana Alliance for Brain Initiatives, і в 2023 році він триватиме з 13 по 19 березня. Це міжнародна глобальна кампанія, спрямована на популяризацію знань про мозок та найновіші досягнення у галузі нейронауки.
Основне завдання Всесвітнього тижня знань про
мозок — поширення знань про досягнення і відкриття

в галузі вивчення мозку, адже дослідження мозку — це
надія на лікування та профілактику від захворювань
та розладів, а також забезпечення кращої якості життя
у будь-якому віці.
Міжнародний Тиждень знань про мозок проводиться в різних країнах практично в один і той же час, що дає змогу зосередити увагу суспільства кожної держави та міжнародної спільноти загалом на актуальних темах для всього людства.
ГОЛОВНИЙ МОЗОК — один із найскладніших і найзагадковіших органів людського організму. Він контролює все, що ми робимо: від основних функцій, таких як дихання та частота серцевих скорочень, до більш складних речей, таких як прийняття рішень, пам’ять і мовлення. Пропонуємо ознайомитися з деякими цікавими фактами щодо роботи мозку.
1. Обсяг пам’яті мозку необмежений. У мозку, на відміну від комп’ютерів і телефонів, місце ніколи не закінчується. Неможливо дізнатися, настільки багато інформації, щоб не залишилося місця для її розміщення. Важливо тільки пам’ятати, що мозку необхідно висипатися, щоб краще запам’ятовувати нову інформацію.
2. Мозок не втомлюється від інтелектуальної роботи. Почуття втоми й апатії з’являються лише через емоції та переживання. При розумовій роботі склад крові, що проходить через мозок, не змінюється. 3. Закоханість можна побачити на фМРТ. Хтось вважає, що закоханість — це стан душі людини. Але насправді, коли людина закохана, в мозку відбуваються зміни. Якщо зробити фМРТ, то на знімках буде помітно як «загоряються» місця, в яких присутній дофамін — нейромедіатор, що викликає приємні відчуття.
4. Мозок не відчуває біль. У мозку немає больових рецепторів. Вони присутні тільки в мозкових оболонках і кровоносних судинах.
5. Мозок не може існувати ні без кисню, ні без глюкози. Нервовим клітинам необхідні ці дві речовини для функціонування і виживання. Якщо протягом 3-5 хвилин мозок не отримує достатньо кисню або глюкози, в ньому відбуваються незворотні порушення. 6. У мозку є німі зони. Дійсно, так звані «німі» зони мозку, які не відповідають за важливі функції, існують. Тільки на перший погляд здається, що після резекції цих зон ми не побачимо втрати функцій людини. Насправді вільних зон немає, в різному ступені всі відділи головного мозку активні.

7. Мозок працює активніше, коли ми спимо. Працюючи, мозок створює електричні поля, які можна виміряти на поверхні шкіри голови за допомогою методу електроенцефалографії. Нам здається, що під

ВСЕСВІТНІЙ ТИЖДЕНЬ
14 Журнал «Сучасна фармація» • modern-pharmacy.com.ua • 2023 / березень • Пульс часу • Події
час сну мозок вимкнений, але насправді він працює навіть активніше, ніж вдень. У період неспання він виробляє альфа- і бета-хвилі, а під час сну, особливо на його початкових стадіях, тета-хвилі. Їх амплітуда більше, ніж у інших хвиль.
8. Короткотривалої пам’яті вистачає на 20-30 секунд. Ви коли-небудь замислювалися, чому
Мозок дорослої людини важить 1,3-2 кг. У жінок в середньому мозок становить близько 2,5 % від маси тіла, а у чоловіків — 2 %.
75 % мозку — це вода. За консистенцією мозок подібний на желе. Зневоднення в 2 %, втрата натрію та електролітів можуть спричинити різкі зміни пам’яті та уваги.
Людський мозок містить близько 86 млрд нейронів.
Обсяг пам’яті мозку до 2,5 млн гігабайтів (це 2,5 петабайт). Це означає, що він може зберігати 3 мільйони годин шоу-програм. Щоб використати такий об’єм інформації, нам доведеться дивитися телевізор протягом більше 300 років.
Мозок — потужний комп’ютер. 4-му найпотужнішому суперкомп’ютеру у світі знадобилося 40 хвилин, щоб імітувати лише одну секунду мозкової діяльності людини. Цей комп’ютер мав 705024 процесорних ядер і 1,4 млн. ГБ оперативної пам’яті.
Інформація у мозку в різних типах нервових клітин проходить з різною швидкістю. Ці сигнали можуть мати повільну швидкість (близько
Отже, здоров’я нашого мозку є ключовим фактором для нашого загального здоров’я та благополуччя. Існує багато способів, які допоможуть зберегти мозкове здоров’я, такі як:
Регулярна фізична активність, яка покращує кровообіг та живлення мозку.
Здорова харчова поведінка, включаючи регулярне споживання овочів, фруктів, риби та здорових жирів.
Збереження мозкової активності, включаючи читання, головоломки, настільні ігри, займання улюбленим хобі, розвиток у невідомих для себе сферах і, звичайно, навчання впродовж усього життя.
Зменшення стресу та заняття релаксаційними практиками, такими як йога та медитація.
Підтримка соціальних зв’язків та взаємодії з іншими людьми, що може допомогти зменшити ризик розвитку депресії та інших психічних розладів.
Бережімо та любімо свій мозок, він потребує уваги та догляду, щоб забезпечити наш загальний добробут.
За матеріалами: https://www.brainawareness.org


після того, як ми ненадовго відволіклися, ми забуваємо, що хотіли сказати? Це пов’язано зі здатністю мозку утримувати в пам’яті невеликі обсяги інформації. Він зберігає її для швидкого доступу, але всього лише протягом 20–30 секунд. Числа, наприклад, утримуються в пам’яті в середньому 7,3 секунди, а букви — 9,3.
1,61 км/год) або дуже стрімку (близько 430 км/год). Крім того, нервові клітини можуть передавати 1000 нервових імпульсів в секунду.
Мозок (саме відділ середній мозок) генерує 48,6 думок на хвилину, це близько 70 000 думок на добу (з них 95 % — повторювані випадкові думки, а близько 80 % — негативні: самокритичні, песимістичні, безрадісні).
Мозок — «найжирніший орган», бо складається щонайменше з 60 % жиру (омега-3 та омега-6), які допомагають стабілізувати клітинні стінки, зменшувати запалення та поліпшувати роботу імунної системи.
Мозок — найгарячіша частина тіла, адже вона на 2,5°С вища, ніж температура тіла.
Мозок у голові — не єдиний мозок. У животі є «вторинний мозок», який впливає на настрій, на реакцію від того, що ми їмо, а також на прийняття рішень. Він містить 100000 нейронів та кишкові бактерії, які відповідальні за більш ніж 30 нейромедіаторів, в тому числі і серотонін («гормон щастя»).

МОЗОК У ЦИФРАХ!
Журнал «Сучасна фармація» • modern-pharmacy.com.ua • 2023 / березень • Пульс часу • Події 15
НОВИЙ ТЕСТ
ДЛЯ ВИЗНАЧЕННЯ

ІНФЕКЦІЙ



Сезон зимових застуд, грипу та RSV настав у північній півкулі, і медичні працівники повинні швидко приймати рішення щодо лікування, коли пацієнти звертаються в лікарню.
За даними ВООЗ, респіраторні віруси є причиною смерті 20 % дітей, які помирають у віці до п’яти років. Якби вчені змогли створити тест, який міг би
швидко й точно виявляти декілька вірусів, це могло б
мати чудовий результат. ПЛР-тести потужні, чутливі
та точні, але вони вимагають копіювання фрагмента геному мільйони разів, що займає кілька годин. Дослідники з Кембриджу розробили новий тест, який «виловлює» декілька респіраторних вірусів одночасно, використовуючи окремі ланцюги ДНК як «приманку», і дає високоточні результати менш ніж за годину.
Тест використовує «наноприманку» ДНК для одночасного виявлення найпоширеніших респіраторних вірусів, включаючи грип, риновірус, RSV та COVID-19. Для порівняння, тести ПЛР (полімеразна ланцюгова реакція), незважаючи на те, що вони високоспецифічні та високоточні, можуть одночасно перевірити лише один вірус і показують результат за кілька годин.
Хоча багато поширених респіраторних вірусів мають схожі симптоми, вони потребують різного лікування. Дослідники кажуть, що тестування на кілька вірусів одночасно гарантує, що пацієнти швидко отримають правильне лікування, а також може зменшити необґрунтоване використання антибіотиків.
Крім того, тести можна використовувати в будьяких умовах і легко модифікувати для виявлення різних бактерій і вірусів, включаючи потенційно нові варіанти SARS-CoV-2, вірусу, який викликає COVID-19. Про результати повідомляється в журналі Nature Nanotechnology.
Вчені заснували свій тест на структурах, побудованих із подвійних ланцюгів ДНК із нависаючими одинарними ланцюгами. Ці поодинокі ланцюги є «приманкою»: вони запрограмовані на певні ділянки РНК цільових вірусів. Потім наноприманки пропускають через дуже крихітні отвори, які називаються нанопорами. Розпізнавання нанопор схоже на зчитувач стрічки, який перетворює молекулярні структури в цифрову інформацію за мілісекунди. Структура кожної наноприманки розкриває цільовий вірус або його варіант.
Дослідники показали, що тест можна легко перепрограмувати, щоб розрізняти варіанти вірусу, включаючи варіанти вірусу, який викликає COVID-19. Цей підхід забезпечує майже 100% специфічність завдяки точності програмованих структур наноприманок.
Патент на цю технологію було подано компанією Cambridge Enterprise, відділом комерціалізації університету, а співавтор, професор Ульріх Кейзер, став співзасновником компанії Cambridge Nucleomics, яка зосереджена на виявленні РНК з точністю до однієї молекули.
Джерело: https://www.sciencedaily.com





РЕСПІРАТОРНИХ
16 Журнал «Сучасна фармація» • modern-pharmacy.com.ua • 2023 / березень • Пульс часу • Вакцінація: за та проти


На початку березня у столиці Австрії пройшов
Європейський конгрес радіології (European Congress of Radiology — ECR). Делегація компанії «ФАРМАК»


взяла участь у заході та представила міжнародній спільноті стенд із трьома контрастними лікарськими засобами власного виробництва.
ECR є однією з найбільших медичних подій у Європі та другою за величиною подією радіологів у світі. Цьогоріч у заході взяли участь понад 25 000 радіологів із понад 120 країн світу. Виставка займала 26 000 квадратних метрів і демонструвала найновіші продукти та послуги 257 експонентів із 33 країн у галузі радіології.
На виставці «ФАРМАК» представив магнітнорезонансні контрастні засоби, а також рентгеноконтрастний лікарський препарат.
Компанія є не лише лідером українського ринку у цих сегментах, а й експортує препарати до країн ЄС та інших країн світу, серед яких Німеччина, Польща, Велика Британія, Казахстан та Молдова.
Окрім візиту багатьох українських радіологів та радіографів, стенд «ФАРМАК » відвідали дистриб’ютори з Австрії, Франції, Німеччини, Ірландії, Литви, Індії, Мексики, Румунії, Саудівської Аравії та Іраку.
«ФАРМАК» ПРЕДСТАВИВ СВОЇ ЛІКИ НА
ЄВРОПЕЙСЬКОМУ КОНГРЕСІ РАДІОЛОГІЇ У ВІДНІ
18 Журнал «Сучасна фармація» • modern-pharmacy.com.ua • 2023 / березень • Пульс часу • Події
визнано компанією
із найкращою
репутацією серед
фармвиробників та
імпортерів України
31 березня 2023 р. на Міжнародному форумі PRNext оголосили переможців VIII Національного рейтингу якості управління корпоративною репутацією «Репутаційні АКТИВісти». Перше місце у галузі «Фармація та медицина»

посів лідер фармацевтичної галузі України «Фармак».
Всього у рейтингу взяли участь 663 компанії із різних галузей, які продемонстрували найкращу роботу своєї системи репутаційного менеджменту в умовах війни. Серед них — вітчизняні підприємства та українські підрозділи міжнародних корпорацій.
Журі рейтингу, до якого увійшли 149 незалежних аналітиків, галузевих експертів і спеціалізованих журналістів провідних медіа, оцінювало компанії за 5 критеріями: репутаційна стабільність, медіа активність, інноваційний підхід, іміджевий капітал КСВ та антикризова стійкість.
«Багато українських фармкомпаній значно постраждали від обстрілів, наприклад, «Фармак»

втратив склад із продукцією на сотні мільйонів гривень… Втім, це не зупинило українську фармацевтичну галузь, і вона продовжила працювати, надавати гуманітарну допомогу та всіляко підтримувати медичні заклади, територіальну оборону, ЗСУ та своїх співробітників в їхніх лавах, а також мирне населення», — коментує Олена Труш, членкиня журі та керуюча власниця ТОВ «РедБіз Лабораторія Медичного Бізнесу».
«Репутація українського бізнесу у війну — це не тільки про його власні досягнення. Але і про те, що він формує своєрідний індикатор стабільності для нашої громадськості та іноземних партнерів. У минулому році «Фармак» 28 лютого, у самий розпал великої війни, сплатив наперед податки, щоб підтримати державу; згодом відновив інвестиції в нові та існуючі виробничі майданчики, облаштував безпечні сховища для співробітників тощо. Протягом усього року ми робили все для того, щоб наші ліки були доступні українському споживачеві та допомагали ЗСУ: від медикаментів до автомобілів та безпілотників. Це і є найкращим показником відповідального бізнесу та репутації, яку маємо сьогодні», — зазначила Алла Позичанюк, керівниця PR-відділу «Фармак».

«ФАРМАК»
Журнал «Сучасна фармація» • modern-pharmacy.com.ua • 2023 / березень • Пульс часу • Події 19
ЛІКИ ВІД
РЕВМАТОЇДНОГО
АРТРИТУ
знижують ризик
виникнення
серцево-судинних
захворювань
ЗГІДНО З РЕЗУЛЬТАТАМИ НОВОГО ДОСЛІДЖЕННЯ, ШИРОКО ВИКОРИСТОВУВАНІ ПРЕПАРАТИ, ЯКІ ЗМЕНШУЮТЬ ЗАПАЛЕННЯ СУГЛОБІВ У ПАЦІЄНТІВ З РЕВМАТОЇДНИМ АРТРИТОМ, ТАКОЖ ЗМЕНШУЮТЬ ЗАПАЛЕННЯ СУДИН І СЕРЦЕВО-СУДИННИЙ РИЗИК.
Люди з ревматоїдним артритом мають більший за середній ризик серцево-судинних захворювань, але нове дослідження показує, що препарати, які зазвичай використовуються для зменшення запалення суглобів у пацієнтів, також знижують і кардіоваскулярний ризик.
Нещодавні клінічні випробування показали, що імуномодулятори — препарати, які зменшують запалення — значно зменшують серцеві напади, інсульти та інші серцево-судинні події у людей із серцево-судинними захворюваннями. Але було незрозуміло, чи ці
ліки мають подібний ефект на людей з ревматоїдним артритом, які мають на 50% вищий ризик серцевих захворювань, ніж середня людина.
Понад 1,3 мільйона дорослих
у Сполучених Штатах мають
ревматоїдний артрит, хронічне
аутоімунне та запальне захворювання, яке викликає хворобливий набряк
суглобів. Відомо, що запалення
призводить до атеросклерозу та серцевих
захворювань, що може пояснити
підвищений рівень серцевих захворювань
у людей з ревматоїдним артритом.
Метотрексат є препаратом першої лінії для лікування пацієнтів із помірним та важким ревматоїдним
артритом, але більшості пацієнтів з ревматоїдним артритом призначають також інгібітор фактора некрозу пухлини (TNFi) або потрійну терапію (метотрексат плюс сульфасалазин і гідроксихлорохін).
У новому дослідженні, очолюваному дослідниками з Колумбійського університету, Брігама та Жіночої лікарні, 115 дорослих із помірним або важким ревматоїдним артритом, незважаючи на лікування метотрексатом, були рандомізовані для додавання TNFi — або адалімумабу (Humira), або етанерцепту (Enbrel) — або піти на потрійну терапію. Через шість місяців в обох групах спостерігалося подібне зниження артеріального запалення, ризику серцево-судинних захворювань і активності захворювання РА.
Комплексне протизапальне лікування зменшило ризик серцевих захворювань у пацієнтів з ревматоїдним артритом, але лікарі все ще повинні звертати увагу на звичайні фактори ризику серцево-судинних захворювань, такі як високий рівень холестерину, високий кров’яний тиск і ожиріння. Але оскільки запалення — ключова ознака ревматоїдного артриту — ще більше підвищує серцевосудинний ризик, то зменшуючи запалення шляхом лікування артриту є новим механізмом зниження ризику серцевих захворювань у цих пацієнтів.
Джерело: www.sciencedaily.com





20 Журнал «Сучасна фармація» • modern-pharmacy.com.ua • 2023 / березень • Пульс часу • Пульс часу


ГАЛУЗІ У ФАРВАТЕРІ ГАЛУЗІ
c.23
Кардіопротекція в сучасній кардіології та раціональний підхід до вибору препарату










c.30
Перші дні, тижні і місяці війни:
історії фармацевтів-героїв Харкова
c.36
Декасан® — інгаляційна протидія
вірусам та бактеріям
c.42
Аваналав на варті відновлення сексуального здоров’я
c.46
Алергія на амброзію: агресивність
пилку визначається місцем його
походження та навколишнім
середовищем
Fides facit fidem

Довіра викликає
довіру
У ФАРВАТЕРІ ГАЛУЗІ У ФАРВАТЕРІ
РАЦІОНАЛЬНИЙ ПІДХІД ДО ВИБОРУ
ПРЕПАРАТУ

A
Макієнко Н.В. , кандидат медичних наук, лікар-кардіолог вищої категорії
«Ми дійшли висновку, що причиною всіх важких захворювань є кисневе голодування.
Гіпоксія, або брак кисню в тканинах — причина виникнення різних захворювань»
Стівен Лівайн, відомий фахівець з молекулярної біології
ХХI ст. показує зростаючу кількість коморбідних станів у пацієнтів, які є не тільки суттєвим тягарем для них самих, а й серйозним викликом для медичної спільноти, що потребує подальшого пошуку ефективних терапевтичних ланок. Серед захворюваності, інвалідності та смертності населення в Україні найпоширенішими залишаються хвороби системи кровообігу (артеріальна гіпертензія (АГ), гострі та хронічні форми цереброваскулярної патології, гострі та хронічні форми ішемічної хвороби серця (ІХС), атеросклероз), ендокринні хвороби та їх ускладнення (ожиріння, метаболічний синдром, інсулінорезистентність, цукровий діабет (ЦД) 2-го типу), а також коморбідні стани [1-3]. Поліорганні зміни, які виникають при поєднанні зазначеної патології, ускладнюють вибір раціонального медичного засобу з меншим ризиком розвитку небажаних побічних реакцій, а також ці стани можуть сприяти формуванню поліпрагмазії.
В формуванні багатьох захворювань хвороби системи кровообігу задіяний ряд патофізіологічних ланок, однією з яких є гіпоксія. Як ми знаємо, всі живі клітини постійно потребують кисню. Людина може знаходитись приблизно 3-6 хвилин без повітря, але коли рівень кисню в крові стає нижче 80 %, починають виникати порушення роботи органів та систем, що сприяє формуванню патологічного стану — гіпоксії, яка супроводжує, як відомо, перебіг багатьох захворювань [4].
ЕКСКУРС
В здоровому організмі, подібно до всіх інших клітин, клітини міокарда й нервової
системи потребують енергії для виконання всіх необхідних завдань. Джерелом цієї енергії в організмі людини є аденозинтрифосфорна кислота (АТФ), що синтезується за участю кисню, а також глюкози або вільних жирних кислот.
2Фізіологічний енергетичний обмін міокарда здійснюється за участю кисню. В стані відносного спокою міокард споживає 8–10 мл кисню на 100 г тканини, що в 15 разів вище, ніж середній рівень споживання кисню іншими органами та тканинами. Основний енергетичний субстрат для кардіоміоциту в нормі — нейтральні жири та вільні жирні кислоти (ВЖК), що забезпечують процеси енергозабезпечення більш ніж на 70 % (β-окислення). В меншій мірі енергозабезпечення міокарда
здійснюється за рахунок глюкози (10–30 % аеробний гліколіз за участю
Рекомендації
фарватері галузі
modern-pharmacy.com.ua



•
2023 / березень • У спеціаліста 23
КАРДІОПРОТЕКЦІЯ В
СУЧАСНІЙ КАРДІОЛОГІЇ
ТА
В ФІЗІОЛОГІЮ
1
кисню та анаеробний гліколіз — 10 %) [4].
Журнал «Сучасна фармація» •
•
ГІПОКСІЯ (лат. hypoxia < грец. hypo — під, нижче + oxys — кислий), або кисневе голодування

тканин — типовий патологічний процес, що виникає внаслідок недостатнього постачання
тканин киснем або порушення засвоєння його тканинами [5].
В залежності від причин виникнення й механізмів розвитку виділяють гіпоксію екзогенну зовнішню (гіпобаричну або нормобаричну), респіраторну (дихальну), циркуляторну (серцево-судинну), гемічну (кров’яну), тканинну (цитотоксичну внаслідок дії отрут), перевантажувальну (гіпоксію навантаження), субстратну та змішану [4, 6].
ПАТОФІЗІОЛОГІЧНІ ЗМІНИ ПРИ ГІПОКСІЇ
За поширеністю виділяють місцеву та загальну
гіпоксію, за швидкістю розвитку та тривалістю — блискавичну, гостру, підгостру і хронічну гіпоксію, за ступенем тяжкості — легку, помірну, тяжку, критичну (смертельну) гіпоксію.
Залежно від етіології прийнято розрізняти гіпоксію двох видів: пов’язану зі зниженням парціального тиску в повітрі, що вдихається, та зумовлену
патологічним процесом в організмі.
В організмі існує дві самих вразливих системи
до гіпоксії та які, перш за все, реагують на дефіцит

кисню — це нервова та серцево-судинна системи.
Найбільш чутлива до гіпоксії нервова система.

Як відомо, нейрони кори головного мозку можуть
повноцінно функціонувати в умовах повного припинення кровотоку всього до 6 хв., нейрони довгастого мозку витримують повне припинення кровопостачання 20-30 хв., нейрони спинного мозку — до 60 хв. Отже, при тривалій гіпоксії виникає ряд патофізіологічних змін — ураження центрів кровообігу й дихання, розлади дихальних рефлексів, з’являються судоми, втрачається свідомість [4].
Також метаболічно гнучким та чутливим до кисневого голодування є серцевий м’яз, який знаходиться на другому місці після нервової системи по чутливості до гіпоксії. Під час ішемії/реперфузії виникає
пошкодження мітохондрій у кардіоміоцитах, які безпосередньо залучені в патофізіологічні механізми, при цьому виникають метаболічні порушення, які впливають, перш за все, на електричну активність, скорочувальну функцію клітин і при продовженні
ішемії загрожують їх життєздатності. Зменшення

постачання кисню та надходження субстрату знижує продукцію енергії мітохондріями [4]. При гіпоксичних станах змінюється характер енергозабезпечення міокарда. А саме при ішемії та порушенні нормального кровопостачання, синтезу АТФ змінюється окислення жирних кислот, а також активується гліколітичний шлях утворення АТФ. Кардіоміо-
цит активно використовує глюкозу з ендогенного глікогену, запаси якого у міоциті швидко виснажуються. Основним механізмом можливого синтезу АТФ під час ішемії стає анаеробний гліколіз з його утворенням, з накопиченням лактату та пірувату. У мітохондріях кардіоміоцитів накопичується велика кількість недоокислених жирних кислот, що чинять руйнівну дію на клітинні мембрани. Крім того, висока внутрішньоклітинна концентрація жирних кислот призводить до пригнічення утилізації глюкози та швидкості продукції АТФ, підвищує проникність мембран для іонів кальцію, підвищує адренергічну відповідь міокарда. [7]. В сучасній медичній практиці все частіше для корекції гіпоксичних станів, їх наслідків та попередження прогресування захворювань призначають препарати, які можуть корегувати ці зміни. Існує великий арсенал лікарських засобів для корекції гіпоксичних станів, але одними з найбільш актуальних стали препарати, які здатні за допомогою різних механізмів згладжувати енергетичний дефіцит, захищати клітини на зворотній стадії від пошкодження й активувати становлення структури й функції, тобто антигіпоксанти. Ця група препаратів поєднує у собі, як правило, властивості мембраностабілізатора та антиоксиданта, бо дефіцит енергії спричиняє різноманітні метаболічні порушення, у тому числі активує вільнорадикальне окиснення в клітині. В сучасній кардіології ці препарати мають назву кардіопротекторні препарати
Кардіопротекторні препарати (або кардіоцитопротекторні препарати) (лат. Сardio — серце + protectio — «прикриття, заступництво; захист») — препарати, які шляхом прямого впливу на кардіоміоцит усувають порушення, передусім, метаболізму та функцій мембран кардіоміоцитів [8].
24 Журнал «Сучасна фармація» • modern-pharmacy.com.ua • 2023 / березень • У фарватері галузі • Рекомендації спеціаліста
Кардіопротекторні препарати сприяють відновленню функціонального стану серця завдяки взаємодії з певними рецепторними ділянками мембрани, ферментами або фрагментами іонних каналів, які, впливаючи на основні види обміну речовин, тим самим запобігають розвитку незворотного ушкодження кардіоміоцитів. Ця група препаратів має здатність оптимізувати тканинне дихання та метаболізм, забезпечити захист клітини в умовах нормального функціонування організму та при патофізіологічних станах: ішемії, гіпоксії, оксидативному стресі; тобто мають можливість відновлювати мітохондріальну біоенергетику [9].
N.B!
«живлення» при аритміях серця, а також як для лікування, так і для профілактики кардіопошкоджень при застосуванні хіміотерапевтичних агентів; деякі кардіопротектори використовують при порушеннях мозкового кровообігу; їх широко застосовують у спортивній медицині та ветеринарії) й потребує ретельного вибору в кожному конкретному випадку [11].
МЕТОНАТ може посилювати дію кардіологічних засобів (нітрогліцерину, ніфедипіну, β-адреноблокаторів, антигіпертензивних засобів і периферичних вазодилататорів).
Історія застосування міокардіальних цитопротекторів нараховує декілька десятків років та широкий арсенал лікарських засобів з різними шляхами впливу на міокард.


Ще 1991 року R. Ferrari опублікував роботу про метаболічну протекцію ішемічного ушкодження міокарда вільними радикалами шляхом застосування тіоловмісних речовин [10]. Також R. Ferrari визначив, що кардіопротекторна або кардіоцитопротекторна терапія — це лікування, яке шляхом безпосереднього впливу на кардіоміоцит сприяє його виживанню в умовах ішемії (гіпоксії).
Спираючись на ці висловлювання, можна узагальнити, що весь спектр призначень кардіопротекторних препаратів є дуже різноманітним (коронарогенні та некоронарогенні захворювання серця, як допоміжні препарати комбінованої фармакотерапії, в лікуванні коморбідних станів; як додаткове джерело
МЕТОНАТ при зниженій працездатності, фізичному та психоемоційному перенапруженні та в період одужання після гострих респіраторних вірусних інфекцій, в тому числі після COVID-19 інфекції, сприяє:

підвищенню концентрації
уваги;
поліпшенню пам’яті, нейропсихологічних та когнітивних функцій;
підвищенню рухової й м’язової
активністі;
підвищенню здатністі організму витримувати великі навантаження;
скорішому відновленню енергетичного потенціалу організму.
спеціаліста
Рекомендації
•
Основним критерієм кардіоцитопротекторної дії препарату з метаболічною активністю повинна бути відсутність негативного впливу на показники гемодинаміки, на скоротливу функцію міокарду, артеріальний
тиск та інші гемодінамічні параметри.
Новим етапом в історії кардіометаболічної терапії стало створення класу коректорів метаболізму — інгібіторів окиснення ВЖК (мельдоній ((3-(2,2,2-триметилгідразиній) пропіонату дигідрат) та інші), які впливають на активність ферментів, що беруть участь у біохімічних реакціях [9]. Одним із таких органопротективних засобів є мельдоній (3-(2,2,2-триметилгідразиній) пропіонат). Мельдоній уперше синтезували в середині 1970-х років в Інституті органічного синтезу в Латвійській республіці група дослідників під керівництвом Івара Калвіньша. У 1984 р. був запатентований у США. Із 1988 року мельдоній дозволено застосовувати в медицині.
За 30-річний період перебування на фармацевтичному ринку мельдоній продемонстрував свою ефективність у складі комплексного лікування найпоширеніших серцево-судинних захворювань. Відомо, що застосування мельдонію у пацієнтів сприяє пригніченню окиснення жирних кислот як джерела енергії
У фарватері галузі
•
2023 / березень
•
modern-pharmacy.com.ua



•
Журнал «Сучасна фармація»
25
та оптимізації окиснення глюкози в результаті зворотної конкурентної інгібіції ферменту γ-бутиробетаїнгідроксилази та зниження карнітинзалежного транспорту довголанцюгових жирних кислот у мітохондрії. Про такі механізми дії препарату свідчить активація ферментів аеробного окиснення глюкози, а саме гексокінази, а також піруватдегідрогенази, що залучають піруват у цикл Кребса [13-16]. Водночас доведено, що, на відміну від інших метаболітотропних
препаратів, мельдоній не підвищує концентрацію
недоокиснених жирних кислот, оскільки запобігає транспорту довголанцюгових жирних
кислот до мітохондрій. При цьому він не перешкоджає доокисненню коротколанцюгових продуктів проміжного окиснення жирних кислот. Тому мельдоній не зумовлює токсичної
дії, що супроводжує утворення ліпопероксидів на фоні активації вільнорадикального окиснення при ішемії та реперфузії міокарда. Також у експериментальних дослідженнях визначено
МЕТОНАТ може бути призначений у комплексній фармакотерапії при коморбідних станах, зокрема при діабетичній нефропатії та нейропатії.
кардіо-, нейро- та в цілому цитопротекторну, ендотеліопротекторну імуномодулюючу, антиагрегантну дію мельдонію [14, 15].
Продемонстровано його вплив на біосинтез оксиду азоту, зниження рівня С-реактивного білка, послаблення експресії інтерлейкіну-1, підвищення рівня інтерферону, а також антикетогенні властивості при цукровому діабеті та ожирінні [15].
Доказова база ефективності та спектр використання мельдонію з кожним роком розширюється. Кардіопротекторна активность препарату підтверджена результатами досліджень, що свідчать про сповільнення формування зони некрозу та скорочення періоду реабілітації пацієнтів із інфарктом міокарда (ІМ). У проспективному багатоцентровому дослідженні MILSS І у пацієнтів із стабільною стенокардією напруження ІІ–ІІІ ФК, у тому числі з перенесеним ІМ, перкутанною ангіопластикою чи аортокоронарним шунтуванням, визначено ефективність препарату в різних дозах на тлі базисної терапії: значне підвищення тривалості фізичного навантаження, періоду до появи елевації сегмента ST, до розвитку ангінозного нападу, підвищення фізичної витривалості, зменшення потреби в нітрогліцерині та зниження ФК стенокардії [17].


Було відзначено хорошу переносимість мельдонію пацієнтами похилого та старечого віку з ішемічною хворобою серця (ІХС) та хронічною серцевою недостатністю (ХСН) [2], а також доведено покращення когнітивних функцій у цієї когорти населення [18]. Дослідники призначали його у комплексній фармакотерапії при коморбідних станах, особливо при діабетичній нефропатії та нейропатії [19].
Механізми реалізації кардіоцитопротекторної дії мельдонію подібні до таких при цереброваскулярній патології [18]. Підтверджено ефективність мельдонію під час ранньої реабілітації неврологічних хворих, в тому числі в комплексній терапії з ішемічним інсультом в гострий період. Включення мельдонію в комплексну фармакотерапію хворих із дисциркуляторною енцефалопатією атеросклеротичного генезу значно поліпшувало ступінь компенсації кровотоку, сприяло регресу клініко-неврологічних синдромів, покращенню когнітивних функцій, нормалізації біоелектричної активності головного мозку [20].


Встановлено підвищення толерантності до фізичного навантаження, поліпшення якості життя пацієнтів. Застосування мельдонію ефективне у осіб із захворюваннями периферичних судин, а також у складі відновної терапії при дисплазії сполучної тканини [15].
ПЕРСПЕКТИВИ ЗАСТОСУВАННЯ
Ще одним із показань до призначення мельдонію може стати лікування гіпоксичних станів у пацієнтів з COVID-19 інфекцією або постковідних станів, тим самим запобігаючи розвитку чи прогресуванню серцево-судинних ускладнень. Так, в одному із останніх експериментальних досліджень показано, що лікування мельдонієм запобігало зменшенню мітохонд-
ріального окислення жирних кислот із супутнім підвищенням метаболізму пірувату в серцевих волокнах щурів і мишей, розвитку систолічної дисфункції правого та лівого шлуночків шляхом посилення функції мітохондрій в випробувальних моделях шлуночкової дисфункції, яка нагадувала серцево-судинні ускладнення у пацієнтів з COVID-19 [21].
26 Журнал «Сучасна фармація» • modern-pharmacy.com.ua • 2023 / березень • У фарватері галузі • Рекомендації спеціаліста
На українському фармацевтичному ринку діючу речовину мельдоній представлено під торговою назвою «МЕТОНАТ» фармацевтичної компанії «САЛЮТАРІС» [22].

МЕТОНАТ пригнічує активність ферменту гамма-бутиробетаінгідроксилази, за рахунок чого знижується швидкість біосинтезу вищезгаданого карнітину та транспорт довголанцюгових жирних кислот у клітину. В цьому випадку вдається виключити жирні кислоти з процесів енергозабезпечення та активувати альтернативний механізм за
участю глюкози — анаеробний гліколіз, який дозволяє нормалізувати транспорт АТФ та адаптувати обмін речовин до умов ішемії, тим самим покращити кровопостачання. Це сприяє покращенню скорочувальної функції міокарда, переносимості фізичних навантажень, зменшенню частоти нападів стенокардії.
МЕТОНАТ здатний впливати на внутрішньоклітинні процеси, сприяючи швидкому відновленню організму після перенесеної інфекції, тим самим попереджає виникненню астенічного синдрому.
ПЕРЕВАГИ МЕТОНАТУ

Чиста речовина
МЕТОНАТ від САЛЮТАРІС виробляється за
сучасною технологією
електромембранного
синтезу, що дозволяє
забезпечити найвищу
чистоту субстанції.
без домішок (на відміну від аналогів, отриманих шляхом йонообмінних смол)
Багаторічний позитивний досвід застосування
Препарат має доведені позитивні ефекти:
антиоксидантні — зменшує інтенсивність
перекисного окислення ліпідів, підвищує активність ендогенних антиоксидантів, знижує наслідки окисного стресу; цитопротекторні — підвищує ефективність
метаболізму і зменшує утворення вільних радикалів, блокуючи окислення жирних кислот; антигіпоксичні — покращує утилізацію організмом кисню і знижує потребу в ньому, що підвищує стійкість органів і тканин до гіпоксії;
Безпека
застосування
МЕТОНАТУ

підтверджується відсутністю
несприятливих
змін основних біохімічних
показників.
СУЧАСНА ТЕХНОЛОГІЯ ЕЛЕКТРОМЕМБРАННОГО СИНТЕЗУ
Ступенева терапія ампули №10 + капсули 250 мг №50 на ПОВНИЙ середній рекомендований курс
Кращі
показники ефективності та безпеки

енергопротекторні — підвищує інтенсивність процесів окислення глюкози, збільшує енергетичний потенціал клітини, знижує накопичення лактату;
ангіопротекторні — стимулює вироблення оксиду азоту, поліпшує мікроциркуляцію за рахунок зменшення агрегації тромбоцитів і збільшення еластичності мембран еритроцитів; імуномодулюючі — підвищує сумарне значення Т-системи і співвідношення Т-хелперної і Т-супресорної популяцій та впливає на рівні IgM і IgA, IgG.
1 капсула містить 250 мг метонату
(3-(2,2,2-триметилгідразиній) пропіонату дигідрат
5 мл розчину (1 апмула) містить 500 мг метонату
(3-(2,2,2-триметилгідразинію) пропіонату дигідрат

Журнал «Сучасна фармація» • modern-pharmacy.com.ua • 2023 / березень • У фарватері галузі • Рекомендації спеціаліста 27
Також показаннями до застосування МЕТОНАТУ є мозковий інсульт і хронічна недостатність мозкового кровообігу, оскільки він сприятливо впливає на клітини центральної нервової системи, поліпшуючи циркуляцію крові в осередку ішемії, сприяючи перерозподілу мозкового кровотоку на користь ішемізованої ділянки. Рекомендований у період одужання після травм голови та енцефаліту.
МЕТОНАТ МАЛОТОКСИЧНИЙ ТА НЕ СПРИЧИНЯЄ
ЗАГРОЗЛИВИХ ПОБІЧНИХ ЕФЕКТІВ.
Все перелічене збільшує клінічний спектр призначень
МЕТОНАТУ, при цьому ефективність його підвищується в
комплексній терапії при: зниженні працездатності та при фізичному, психоемоційному перенапруженні;
при підвищенні розумових і фізичних навантажень;
при зниженні концентрації та уваги, зниженні пам’яті;
під час зниження фізичної витривалості;
при слабкості й втомлюваності після фізичних та розумових перевантажень.
МЕТОНАТ широко використовується в офтальмологічній практиці
Позитивний вплив МЕТОНАТУ на дистрофічно змінені судини сітківки робить його актуальним у лікуванні гемофтальму та крововиливу у сітківку ока різної етіології (у тому числі діабетичної та гіпертонічної).
Протипоказів до застосування мельдонію небагато, але про них варто пам’ятати:
реакція гіперчутливості на компоненти, що входять до його складу
підвищений внутрішньочереп-
ний тиск
тяжка печінкова та/або ниркова
недостатність
вагітність та годування груддю
дитячий та підлітковий вік
Оскільки мельдоній метаболізується в печінці й нирках, пацієнтам із хворобами цих органів під час лікування слід бути максимально уважними. МЕТОНАТ можна призначати лише з 18 років.
МЕТОНАТ представлений у 2 лікарських формах: у вигляді розчину д/ін’єкцій 100 мг/мл в ампулах по 5 мл та капсулах по 250 мг. Це дозволяє приймати препарат перорально або вводити внутрішньовенно, що визначається загальним станом пацієнта.
Добова доза препарату МЕТОНАТ для дорослої людини становить 500 мг. Дозу можна розділити на 2 прийоми або застосувати всю одразу. Тривалість курсу лікування — від 4 до 6 тижнів. Препарат можна застосовувати курсами 2–3 рази на рік.
Резюмуючи ефекти діючої речовини МЕТОНАТУ, можно сказати, що препарат дає можливість залишатись активним при різних станах.
Таким чином, гіпоксичний стан об’єднує настільки різні захворювання, що розширює можливості для застосування антигіпоксантів в клінічній практиці, при цьому необхідно розуміти механізми саморегуляції та механізми розвитку цих патологій, уникаючи тим самим побічних небажаних ефектів.
Літературні джерела
1. Амосова Е.Н. Метаболическая терапия повреждений миокарда, обусловленных ишемией: новый подход к лечению ИБС и сердечной недостаточности. К.,2000 — 8 с. (Сер.: «В помощь практическому врачу»).
2. Беловол А.Н., Князькова И.Н. Метаболическая терапия при ишемической болезни сердца у лиц пожилого возраста. Ліки України. 2012.№ 161(5).С. 51–55.
3. Долженко М.Н. К вопросу о целесообразности применения метаболической кардиопротекции в эпоху доказательной медицины / М.Н. Долженко //МЛ. — 2012. — №2-3, (88-89). — С. 1 — 8.
4. Березовський В. Сучасний стан проблеми кисневої недостатності: саногенна і патогенна дія гіпоксії / В. Березовський, І. Літовка // Праці наукового товариства ім. Шевченка. Медичні науки. — 2017. — Т. 49. — С. 94-109. — Режим доступу: http://nbuv.gov.ua/UJRN/pntsh_lik_2017_49_51.
5. https://www.pharmencyclopedia.com.ua/article/2960/gipoksiya
6. Богданова Н.О., Погорєла Н.Х., Лук’янець О.О. Роль гіпоксії у розвитку деяких патологічних станів та злоякісних пухлин // Фізіол. журн. 2021. Т. 67, № 2 С.53-60
7. Dambrova Maija, Zuurbier Coert J, Borutaite Vilmante et al. Energy substrate metabolism and mitochondrial oxidative stress in cardiac ischemia/reperfusion injury // Free Radic Biol Med. 2021.Vol.165.P.24-37. https://doi.org/ 10.1016/j. freeradbiomed.2021.01.036
8. https://www.pharmencyclopedia.com.ua/article/6334/kardioprotektorni
9. Компендиум 2015 — Лекарственные препараты / Под ред. В.Н. Коваленко. — К., 2015.
10. Ferrari R, Ceconi C, Curello S et al. Oxygen free radicals and myocardial damage: protective role of thiol-containing agents.// Am J Med. 1991. Vol. 30;91(3C):95S-105S https://doi.org/10.1016/0002-9343(91)90291-5
11. Сидорова Н.Н. Метаболическая терапия: право на жизнь / Н.Н. Сидорова // erapia. Український медичний вісник. — 2016. — № 3. — С. 7-10.
12. https://uk.wikipedia.org/wiki/ %D0 %9C %D0 %B5 %D0 %BB %D1 %8C %D0 %B4 %D0 %BE %D0 %BD %D1 %96 %D0 %B9

13. Калвиньш И.Я. Милдронат и механизмы оптимизации клеточного производства энергии в условиях кислородного голодания. Цереброкардиальная патология — новое в диагностике и лечении: Матер. III Междунар. симпозиума, 2001, с. 3–16.
14. Бурчинский С.Г. Стратегия нейрометаболической фармакотерапии у пациентов с артериальной гипертензией. Артериальная гипертнезия. 2015. N6(44). — С. 65-69.
15. Чекман І.С., редактор. Фармакологія: підручник. Вид. 3-тє, виправлене та доопрацьоване. Вінниця: Нова Книга; 2016. 783с.
16. Dambrova M, Makrecka-Kuka M, Vilskersts R, et al. Pharmacological e ects of meldonium: biochemical mechanisms and biomarkers of cardiometabolic activity. Pharmacol Res. 2016.Vol.113.P. 771–780. https://doi.org/10.1016/j.phrs.2016.01.019.
17. Dzerve V. MILSS I Study Group A dose-dependent improvement in exercise tolerance in patients with stable angina treated with mildronate: a clinical trial «MILSS I». Medicina, Kaunas.2011.Vol. 47(10).P. 544–551



18. Логина И.П., Калвиньш И.Я. Милдронат в неврологии. — Рига, 2012. — 56 с
19. Мошковська Ю.О. Використання коректорів метаболізму — сучасний підхід комбінованої терапії хворих на ішемічну хворобу серця. Ліки України.2013.№ 167(1).С. 66–69
20. Хасенова Г.П., Кайшибаев Н.С., Кайшибаева Г.С. и др. Эффективность применения препарата милдронат у больных с дисциркуляторной энцефалопатией атеросклеротического генеза. Междунар. неврол. Журнал.2012. № 7(53).С. 87–93.
21. Vilskersts Reinis, Kigitovica Dana, Korzh Stanislava et al. Protective E ects of Meldonium in Experimental Models of Cardiovascular Complications with a Potential Application in COVID-19. Int J Mol Sci. 2021.Vol.21;23(1):45. https://doi. org/10.3390/ijms23010045
22. https://compendium.com.ua/info/173488/metonat/
28 Журнал «Сучасна фармація» • modern-pharmacy.com.ua • 2023 / березень • У фарватері галузі • Рекомендації спеціаліста
МОЖЛИВІСТЬ ЗА ЛИШАТИСЬ АК ТИВНИМ
СПРИЯЄ ПОКРАЩЕННЮ
МЕТАБОЛІЗМУ МІОКАРДУ


В УМОВАХ ГІПОКСІЇ*
ПІДВИЩУЄ ЕФЕКТИВНІСТЬ
АНТИАНГІНАЛЬНОЇ ТЕРАПІЇ
У ПАЦІЄНТІВ З ІШЕМІЧНОЮ
ХВОРОБОЮ СЕРЦЯ*
ПІДВИЩУЄ ЕФЕКТИВНІСТЬ КОМПЛЕКСНОЇ ТЕРАПІЇ У ПАЦІЄНТІВ З СЕРЦЕВОЮ НЕДОСТАТНІСТЮ*
СТУПІНЧАСТА ТЕРАПІЯ: ампули №10 + капсули 250 мг №50 на ПОВНИЙ середній рекомендований курс Виробляється за сучасною технологією електромембранного синтезу
ПОКРАЩУЄ ЕФЕКТИВНІСТЬ
КОМПЛЕКСНОЇ ТЕРАПІЇ ПРИ
ГОСТРИХ ТА ХРОНІЧНИХ
ІШЕМІЧНИХ ПОРУШЕННЯХ
МОЗКОВОГО КРОВООБІГУ*
Чиста субстанція без домішків
ПОКРАЩУЄ ФІЗИЧНУ ВИТРИВАЛІСТЬ*
*Інструкція до медичного застосування лікарського засобу МЕТОНАТ Скорочена інформація про лікарський засіб Метонат® Склад: діюча речовина: метонат (3-(2,2,2-триметилгідразиній) пропіонату дигідрат); 1 капсула містить 250 мг метонату; 5 мл розчину (1 ампула) містять 500 мг метонату. Лікарська форма: Капсули, розчин для ін’єкцій Фармакотерапевтична група: Засоби, що впливають на серцево-судинну систему. Інші кардіологічні препарати. Код АТХ С01Е В22, Показання: У комплексній терапії у таких випадках: захворювання серця та судинної системи: стабільна стенокардія навантаження, хронічна серцева недостатність (NYHA I-IIІ функціональний клас), кардіоміопатія, функціональні порушення діяльності серця та судинної системи; гострі та хронічні ішемічні порушення мозкового кровообігу; знижена працездатність, фізичне та психоемоційне перенапруження; у період одужання після цереброваскулярних порушень, травм голови та енцефаліту. Протипоказання: Підвищена чутливість до 3-(2,2,2-триметилгідразинію) пропіонату дигідрату та/або до будь-якої допоміжної речовини препарату, підвищення внутрішньочерепного тиску, тяжка печінкова та/або ниркова недостатність, вагітність, годування груддю. Спосіб застосування та дози: Доза для дорослих становить 500 мг на добу (2 капсули 250 мг або 1 ампула 5 мл) Добову дозу можна застосовувати всю одразу або розділити на дві разові дози. Препарат рекомендується застосовувати в першій половині дня. Інформація для професійної діяльності медичних та фармацевтичних працівників. Призначена для розповсюдження на семінарах, конференціях, симпозіумах на медичну тематику. Перед застосуванням препарату необхідно ознайомитись з повною інструкцією. РП Метонат капсули по 250 мг №50 UA/11399/01/01, термін дії РП необмежений з 16.03.2021. Наказ МОЗ №43 від 11.01.2022, Виробник. ПрАТ «Лекхім-Харків». Місцезнаходження виробника та адреса місця провадження його діяльності. Україна, 61115, Харківська обл., місто Харків, вулиця Северина Потоцького, будинок 36. РП Метонат, розчин для ін`єкцій 100 мг/мл по 5 мл в ампулах №10 термін дії РП необмежений з 28.04.2021 UA/11449/01/01, Наказ МОЗ №43 від 11.01.2022 Виробник. ПАТ «Монфарм». Місцезнаходження виробника та його адреса місця провадження його діяльності. Україна, 19100, Черкаська обл., м. Монастирище, вул. Заводська, 8. За додатковою інформацією звертайтесь до ТОВ «Фармацевтична компанія «Салютаріс». Місцезнаходження 01042, м. Київ, бульвар Дружби народів, 9, поштова адреса: а/с 57, тел.: +038 (044) 290-77-99
ПЕРШІ ДНІ, ТИЖНІ

І МІСЯЦІ ВІЙНИ:
ІСТОРІЇ ФАРМАЦЕВТІВГЕРОЇВ ХАРКОВА
Жити і працювати у Харкові — і сьогодні випробування. Після звільнення Харківської області польова артилерія вже не дістає до міста, але ворог нещадно обстрілює прикордонні райони, а в саме місто щосекунди може прилетіти ворожа ракета С-300. Сирена лунає по декілька разів на день, а повітряна тривога може тривати годинами.
Місто встояло, і це допомогло встояти цілій країні. Харків здобув славу героїчного міста завдяки незламності не тільки його захисників, але й комунальників, лікарів, фармацевтів, волонтерів, які продовжували виконувати свою роботу.
У цьому номері ми публікуємо історії фармацевтів-харків’ян, записані у найстрашніші для Харкова перші тижні і місяці війни. Це історії Каріни Шевчук, Аліни Артобалевської, Владлени Жєвєдєвої, а також мами і доньки Лариси і Юлії Закривидороги. У той час, як тисячі жителів евакуювалися з міста або перебували у підвалах і на станціях метрополітену, ці мужні жінки і дівчата працювали під обстрілами, щоб харків’яни могли дочекатися Перемоги.
ЛАРИСА ЗАКРИВИДОРОГА: У
Вона не вважає себе героїнею, а свої вчинки — подвигом. «Я просто виконую свою роботу», — каже Лариса Володимирівна Закривидорога, яка щодня стає за перший стіл, щоб харків’яни мали змогу придбати ліки.
24 лютого 2022 року у неї був чесно зароблений вихідний. Лариса Володимирівна мріяла виспатися. Але бомби, які російські «друзі» скинули на військову частину поряд з її будинком, розбудили жителів Північної Салтівки о п’ятій ранку.



— Ми з чоловіком прокинулися і одночасно запитали один одного: «Війна?» Вірити не хотілося. Я взяла собаку і вийшла на вулицю. Наш будинок стоїть над дорогою, тому перше, що я побачила, — чотири вантажівки з українськими військовими. Вони просили місцевих не виходити на вулицю, особливо вночі.


— ДІСТАТИСЯ ДО АПТЕКИ

МЕНЕ БУЛА ОДНА ЗАДАЧА
30 Журнал «Сучасна фармація» • modern-pharmacy.com.ua • 2023 / березень • У фарватері галузі • У фарватері галузі
— Ви послухалися?
— До ранку не виходила, а о сьомій пішла на роботу.
— Під обстрілами?
— Приблизно на півдорозі до моєї аптеки «Салтівська-1» стоїть церква. Я собі сказала, що маю добігти
до неї, і якщо все буде добре, то й день пройде нормально. Бог мене збереже.
— Багато ваших колег поїхали з міста? — У нашій аптеці з дванадцяти співробітників залишилося троє: я і двоє хлопців — Олексій Володимирович Карпов та Сергій Федорович Гурьєв. Ми назвали нашу команду «Чіп і Дейл поспішають на допомогу». Так втрьох і мігрували з однієї аптеки в іншу.
— А чому довелося мігрувати?
— Тому що в аптеці швидко закінчувався товар. Чимало аптек зачинилися на початку війни, не було кому вийти на роботу, а в аптеках залишалися ліки, які
були вкрай потрібні людям.
Спочатку ми розпродали весь товар нашої «Салтівської-1». Напередодні війни в аптеці були зроблені величезні запаси. У мирний час цієї кількості ліків вистачило б на декілька місяців. Однак з початком бомбардувань багато харків’ян перебралися в метро, а наша аптека якраз розташована поряд з однією зі станцій. Тому щоранку біля віконця, через яке ми обслуговували харків’ян, утворювалась величезна черга. Наша аптека виявилась єдиною, що працювала у ті дні на вулиці Героїв Праці.
Усі пацієнти приходили з довжелезними списками, щоб прискорити процес відпуску ліків. Ми працювали з 8.00 до 13.00. Щоправда, я відпрошувалася у хлопців раніше, адже на Салтівці саме в цей час посилювалися обстріли. Тож колеги вже самі зачиняли аптеку. — І яка аптека прийняла вашу команду після «Салтівської-1»?

КАРІНА ШЕВЧУК: ХАРКІВ’ЯНИ МАЮТЬ
ПІДСТАВЛЯТИ ОДИН ОДНОМУ ПЛЕЧЕ
Жити і працювати у Харкові — це справжнє випробування. Але наші фармацевти щодня «на відмінно» складають іспит на витримку і людяність.
«Аптека 9-1-1 Центральна 9» розташована поряд зі станцією метро «Перемога». У цей район досить часто прилітає, але завідувачка Каріна Шевчук вже звикла до обстрілів, бо за першим столом з самого початку війни.

У мирний час в аптеці працювали дванадцять співробітників. Але потім дівчина залишилася сама. Згодом штат поповнювався за рахунок працівників з інших аптек мережі, які жили поряд. Але не настільки швидко, як росли черги під аптекою.
— Це була аптека на «Компасі». Там ми теж обслуговували людей через віконце. За два тижні впоралися і переїхали в іншу аптеку, що знаходилася у торговельному центрі «Dафі» на вулиці Героїв Праці, 9. Згодом і з нею довелося розпрощатися. Північну Салтівку російські війська обстрілювали безперестанку — там було суцільне пекло. Дуже багато будинків розтрощено. Все чорне, обгоріле. Іноді дорогою на роботу чи з роботи змушена була ховатися у під’їздах розбитих будинків, коли зовсім близько прилітало. Я навіть плакала від образи. Ну за що це все харків’янам? Наш будинок не встояв, тому довелося переїхати в інший район, де хоча б не було прямих влучань.
— Ви розлучилися з хлопцями?
— На жаль, обставини змусили. Розпалася наша героїчна команда. Довелося перейти в аптеку «Нові будинки-2». Там було спокійніше, ніж на Салтівці.
— Але все одно обстріли продовжувалися?

— Так. Був випадок, коли до нас в аптеку під час бомбардування забігли п’ятеро поліцейських. І запитують у мене: «А ви не боїтеся?» Я посміхнулася і кажу: «Я з Північної Салтівки». Харків’яни зрозуміють!

— А вам насправді не страшно?
— Мені страшно зараз, коли пригадую той період. А тоді була лише одна задача — дістатися до аптеки, а потім — з аптеки додому. Не можна було боятися, адже нас чекали люди. Деякі з них обходили пішки пів Харкова у пошуках необхідних ліків. Хіба я могла не вийти на роботу? А раптом саме ця таблетка метформіну могла врятувати пацієнту життя, а він її не купив, бо аптека була зачинена?
Фармацевти обрали цю професію, отже мають виконувати свої обов’язки за будь-яких обставин. Це наша робота. Війна продовжується, але й життя триває. Зараз я працюю завідувачкою «Аптеки 9-1-1» у Немишлянському районі Харкова. Вистоїмо!
•
• 2023 /
• У
• У фарватері галузі 31
Журнал «Сучасна фармація»
modern-pharmacy.com.ua
березень
фарватері галузі
Люди у паніці скуповували майже все, оскільки ситуація у Харкові погіршувалася щодня. Місто постійно бомбили, часто вибухи лунали зовсім поряд. Іноді вранці доводилося збирати на підлозі аптеки упаковки ліків, що впали з полиць, коли десь неподалік розривались снаряди і від вибухової хвилі здригалися стіни.
Спочатку під час масованих обстрілів
аптеку зачиняли, але згодом звикли і вже за звуками вибухів навчилися розрізняти, наскільки серйозною є небезпека. Якщо вибухи лунали далеко, то продовжували відпускати ліки.
В аптеку приходило багато військових, для яких завжди був «зелений коридор». Відвідувачі проявляли

повагу і розуміння і пропускали їх без черги.
Співпрацювали і з волонтерами. «До нас звернулися волонтери зі Львова. У місті критично не вистачало дитячого харчування, підгузків, засобів догляду
за дітьми та ліків. До Львова через війну виїхали
багато людей, зокрема мами з малюками, тому в місцевих аптеках запаси необхідних товарів дуже швидко
вичерпалися. У нас же були ці запаси, до того ж нам
«перекидали» товар з інших аптек нашої мережі, працівники яких виїхали. Тому ми збирали і відправляли необхідні товари за списками волонтерів».
Каріна пригадує, як на станції метро «Перемога», де ховалися багато харків’ян, люди стали масово хворіти на COVID-19. «Звідти присилали «гінців» з довжелезними списками. На щастя, в аптеці були необхідні ліки і ми могли допомогти людям. Рекомендували їм хоча б час від часу ненадовго виходити на свіже повітря, але вони були дуже наляканими, тому навряд чи дослухалися до наших порад».
Завідувачка «Аптеки 9-1-1» з першого дня ввела обмеження на відпуск ліків в одні руки, оскільки через паніку люди готові були скуповувати все. Тож для забезпечення ліками більшої кількості пацієнтів доводилось ділити упаковку і видавати в одні руки по декілька пластинок одного лікарського засобу.

Але під опікою фармацевтів були не лише відвідувачі аптеки. «Одного разу довелося посеред вулиці обробляти велику рвану рану жінці. Пояснити їй щось було неможливо — вона виявилась іноземкою і не розуміла нашої мови. Надали першу допомогу і на швидкій відправили до лікарні».
Ходити на роботу під обстрілами, консультувати і заспокоювати знервованих відвідувачів аптеки, рятувати їх від відчаю у місті, яке ворог намагався знищити, стало щоденною справою для Каріни Шевчук. «Бути фармацевтом — це вміти ставити інтереси людей вище за свій страх і втому. Війна дала нам урок людяності і мужності. Ми — харків’яни і маємо підставляти один одному плече».
ЮЛІЯ ЗАКРИВИДОРОГА: МИ БУДЕМО ПРАЦЮВАТИ ДО ОСТАННЬОГО!
«Головна аптека твого міста» на вулиці Пушкінській працювала з першого дня війни. Її двері були зачинені лише 27 лютого, коли сусідньою вулицею йшли російські танки.
Завідувачку «Головної аптеки твого міста» Аптечної мережі 9-1-1 Юлію Андріївну Закривидорогу вранці 24 лютого на порозі зустріли два фармацевти, які чергували вночі. «Не йдіть туди, там всі плачуть», — з такого напуття розпочався перший робочий день під обстрілами. Потім таких днів буде безліч — з довжелезними чергами, прильотами поряд і людьми, які плачуть і просять завтра відкритися, бо «ми без вас загинемо».
Юлія зайшла в аптеку і побачила всіх працівників зміни. Всі двадцять вийшли на роботу! Свою завідувачку вони сповістили про рішення, яке тоді прийняли одностайно: «Ми будемо працювати до останнього!»

той найстрашніший день 24 лютого відвідувачі

займали чергу з п’ятої ранку. Лише працівники нічної
зміни до восьмої ранку встигли обслужити понад 200
людей! Але черга не зменшувалась. Об одинадцятій
годині поряд почали лунати вибухи, і завідувачка
вирішила зачинити аптеку.
Наступного дня на зміну вийшли семеро із 43 працівників, які в мирний час працювали у найбільшій аптеці Харкова. Юлія вже тоді вирішила: якщо навіть всі працівники відмовляться, то вона працюватиме
вдвох зі своєю заступницею. «Аптека працювала 25 і 26 лютого. Ввечері мені зателефонували з тероборони і попередили, що 27 лютого через Харків йтимуть російські танки, тому аптеку відкривати не можна. Це був єдиний день, коли наші відвідувачі не змогли купити у нас ліки. Після того і дотепер ми відкриті щодня».
У «Головній аптеці» був найбільший запас ліків і вона стала рятівним колом для харків’ян. До того ж, поставки до цієї аптеки не припинялися. «5 березня нам доставили 300 ящиків товару. Водій і мій чоловік,
У
32 Журнал «Сучасна фармація» • modern-pharmacy.com.ua • 2023 / березень • У фарватері галузі • У фарватері галузі
який разом зі мною щодня працював в аптеці, розвантажували їх під обстрілами. Потім до нас звозили товар з інших аптек, які зачинилися через відсутність персоналу. Коли розбомбили аптеку на вул. Лісопарківській, привезли у «Головну аптеку» все те, що вдалося врятувати. Безцінний вантаж розбирали руками, кожну коробочку ретельно переглядали і перевіряли. Отже, у нас завжди були ліки і, звісно, відвідувачі, адже чимало аптек у Харкові не працювали».
Люди дякували і буквально молилися на своїх фармацевтів-рятівників. «Ви тільки працюйте! Нам без вас не вижити!» Це казав кожен другий відвідувач.

Юлія пригадує 8 березня. В аптеку з довжелезним списком ліків прийшов волонтер. Побачив, що працюють лише жінки. Поки йому збирали замовлення, він збігав за квітами і подарував кожній працівниці троянду. «Це було несподівано і дуже приємно. Але святкова історія на цьому не закінчилася. Чоловік, що чекав у черзі і був свідком такого незвичного привітання, повернувся в аптеку через 10 хвилин з оберемком жовтих тюльпанів — у тому букеті була 41 квітка.
Він сказав мені: «Дякую вам за те, що аптека працює!»
«Головна аптека твого міста» продовжує працювати увесь час. Коли надто близько прилітає, фармацевти ховаються в метро, але обов`язково повертаються
на робоче місце. «Ми — працівники сиcтеми охорони здоров`я, тому наше головне завдання — рятувати людей. Ми не маємо права приректи на загибель діабетиків, гіпертоніків та інших пацієнтів, для яких ліки — єдиний спосіб вижити. Я і мої колеги добре це розуміємо, тому і виходимо працювати в свою аптеку щодня».
4 МІСЯЦІ БЕЗ ВИХІДНИХ ЗАРАДИ ЛЮДЕЙ

Ранок 24 лютого розпочався з вибухів. На Північній Салтівці у Харкові, де жила Аліна Вадимівна Артобалевська, завідувачка одразу двох аптек — «Аптеки оптових цін» на Північній Салтівці та «Аптеки 9-1-1» на Холодній горі, їх неможливо було ні з чим сплутати. Вона одразу зрозуміла, що почалося повномасштабне вторгнення.
«Згодом зателефонували мої «нічники» з обох аптек. Вони були перелякані і не знали, що робити з натовпом, який штурмував аптеки. Я зібралася і разом з чоловіком поїхала в аптеку на Північній Салтівці. У другу свою аптеку відправила на допомогу заступницю. Ми приїхали, відпустили дівчат з нічної зміни і встали за перший стіл».

Людей була просто сила-силенна. Хвіст черги на вулиці навіть не було видно. В обох аптеках, якими керувала Аліна Вадимівна, було дуже багато товару, це дозволило максимально задовольняти попит. «Аптека 9-1-1» на Холодній горі відпускала через віконце, а на Північній Салтівці обслуговували людей в залі.

«З десяти працівників залишилися ми вдвох з моєю заступницею, тому було непереливки. Люди нервували і не завжди поводилися адекватно, особливо напруга зростала перед закриттям аптеки.
фарватері галузі
• У
modern-pharmacy.com.ua •

• У фарватері галузі
2023 / березень 33
•
АЛІНА АРТОБАЛЕВСЬКА:
Ми мали зачинятися о 15-й, транспорт не ходив, тому на роботу і з роботи діставалися, як прийдеться. Коли йшли пішки під обстрі-
Журнал «Сучасна фармація»
лами, коли вдавалося викликати таксі, це коштувало 500–600 грн, при цьому ще годину доводилося чекати, поки хтось погодиться їхати. Але не вийти на роботу ми не могли, бо людям були потрібні ліки. Приходили багато волонтерів, і ми збирали величезні коробки ліків на десятки тисяч. А ще у нас, на Північній Салтівці, було дуже багато матусь — вони звикли купувати тут дитяче харчування і засоби догляду за малюками. Хіба я мала право залишити їх без необхідного?»

У такому шаленому темпі «Аптека оптових цін» на Північній Салтівці працювала 10 днів. Над аптекою постійно гули літаки, було дуже страшно. Північну
Салтівку обстрілював ворог з якимось нелюдським
натхненням. Але Аліна Вадимівна разом із заступ-
ницею не дозволяли страху взяти гору. На початку березня в сусідній будинок прилетів снаряд і зникла електрика.
«Певний час ми ще збирали ліки за списками, поки керівництво не прийняло рішення задля нашої безпеки зачинити аптеку. Навколо вже було надто багато прильотів».
Після цього Аліну Вадимівну направили в аптеку на Французькому бульварі приймати товар з розбитих аптек мережі.
«Нам щодня привозили товар із семи–восьми аптек. До того ж ми обслуговували волонтерів — збирали ліки за списками».
У травні Аліна Вадимівна разом із ще однією завідувачкою — Неярою Муратгазієвою звернулися до керівництва з проханням відкрити аптеку на Північній Салтівці.
Жодна аптека там не працювала, і людям доводилося обходити пів міста в пошуках ліків.
«4 місяці без вихідних! Але інакше під час війни не можна. Кожен має викладатися на повну, у кожного свій фронт».
Згодом Аліна Вадимівна стала куратором аптек. Зараз вона відповідає за роботу тридцяти аптек і відкриває аптеки на Північній Салтівці.
ВЛАДЛЕНА ЖЄВЄДЄВА: ВТОМЛЮВАЛИСЯ
НАСТІЛЬКИ, ЩО НАВІТЬ НА ПАНІКУ СИЛ НЕ ЗАЛИШАЛОСЯ
Дівчина ні на день не виїжджала з Харкова. Навіть
тоді, коли було страшно виходити на вулицю, вона

не дозволяла собі залишити аптеку зачиненою.

Коли в березні 2022 року її призначили
завідувачкою «Аптеки Низькі Ціни №1», Владлена не сперечалася, хоча і не планувала підніматися кар’єрними сходами.
«У війни свої закони, вона не запитує, чого ми хочемо», — каже Владлена Жєвєдєва зараз і посміхається. Вона нікому і ніколи не дозволяла приймати рішення за неї, звикла нести відповідальність за кожен свій крок. Такою була з дитинства. Дівчина виросла в родині фармацевтів — дідусь викладав фармакогнозію в Національному фармацевтичному університеті, мама працювала в аптеці. Здавалося б, вибір майбутньої професії був очевидним. Але це не про Владлену. «Мені подобалась психологія — хотіла допомагати людям стати щасливими. Довго зважувала. Потім подумала, що щасливою може бути лише здорова людина».

Фармація перемогла!
Після 9 класу дівчина вступила до коледжу і закінчила його в 2015 році. Одразу подала документи в НФаУ на заочне відділення і пішла працювати в «Аптеку 9-1-1». Спочатку було складно, але Владлена ніколи не
обирала легкого шляху. «Я розуміла, що потрібен час на опанування практичних навичок. Прийняла це як виклик. Досить швидко влилася в роботу, і мене вже не лякала черга відвідувачів. Робота за першим столом приносила справжнє задоволення. Я відчувала себе на своєму місці». Але ця аптека зачинилася.
У 2017 році дівчина перейшла в «Аптеку оптових цін» поруч з міською лікарнею №2 імені О. О. Шалімова. Починала за першим столом, за рік закінчила Національний фармацевтичний університет і стала завідувачкою. Але в середині 2019 року життя Владлени круто змінилося — вона прийняла рішення поїхати жити за кордон.
Новий етап — нові випробування
За два роки Владлена повернулася в Україну. «Дуже скучила за роботою. Але розуміла, що зараз не готова йти на завідування, потрібно надолужити згаяне, адже за кордоном я не працювали за фахом. Тому вла-
34 Журнал «Сучасна фармація» • modern-pharmacy.com.ua • 2023 / березень • У фарватері галузі • У фарватері галузі
штувалася фармацевтом в «Аптеку Низькі Ціни №1».
Тут і зустріла війну». Про початок повномасштабного вторгнення дівчина дізналася ще вночі напередодні. «Зателефонувала колега і розповіла, що чула якісь дивні звуки. Вибухи? Ми з нею посміялися і вирішили, що то хтось запускає феєрверки. На тому і полягали спати, але ненадовго. Опівночі мені повідомили знайомі, що за пару годин розпочнеться. Які в мене були варіанти? Одразу виїхати або залишитися. Страху не було — тоді ми ще не знали, чого боятися. На той момент все здавалося якимось кіно, де ти у глядацькому залі переживаєш

за героїв на екрані, а не за себе. О п’ятій ранку зателефонувала мама, яка живе в Харківській області. Вона плакала і примовляла: «Доню, виїжджай, на місто сунуть танки й ворожа техніка. У нас навкруги вибухи!» Страшне кіно перетворилося на реальність…»
Владлена зібрала необхідні речі і вирушила в інший район Харкова до бабусі з дідусем. Саме онука принесла стареньким страшну звістку. Вирішили триматися разом, так здавалося безпечніше.
А що відбувалося в аптеці?
— Двоє співробітників виїхали вже 24 лютого, ще двоє — за тиждень. Ми залишилися вдвох з колегою.
Нам на допомогу приходили працівники з інших аптек нашої мережі, зазвичай ті, хто жив поруч, бо транспорт не ходив.
На роботу виходили по двоє. Люди в буквальному сенсі влаштовували засідку під аптекою. Зранку за пів години до відкриття на нас вже чекала черга мінімум з 30 людей. Наша аптека єдина працювала у мікрорайоні.
Паніка була «головним двигуном прогресу». Скуповували все, що треба і не треба, бо не знали, чи відкриємося ми завтра і чи залишиться хоч щось в аптеці. Ми запускали в аптеку по двоє–троє людей, бо інакше той шалений натовп стримати було неможливо. Кілька разів черга вдиралася в аптеку. Люди кричали, плакали, вмовляли… Думали, доведеться навіть викликати поліцію, але після гарячих дискусій вони приходили до тями.
Як швидко виник дефіцит ліків і як вирішували цю
проблему?
— За тиждень уже не було практично нічого із серцевих і заспокійливих ліків. Перевіряли по кілька разів інструкції до всіх лікарських засобів першої необхідності і робили заміну — намагалися хоч якось допомогти людям, які вперше не знаходили в аптеці своїх ліків і дуже лякалися.
Але нашим відвідувачам пощастило. Нам привезли лікарські засоби, які вдалося врятувати з аптеки, зруйнованої внаслідок прильоту. 500 синіх ящи-

ків-контейнерів з препаратами! Вони займали всю площу аптеки, навіть прослизнути між ними не завжди вдавалося.
Розібрати їх було справжнім випробуванням. У тих ящиках траплялися і коробки, що підгоріли, і шматки штукатурки... Закрилися на два дні (торгувати все одно було нічим) і взялися сортувати і розкладати. На третій день відкрилися. Обслуговували відвідувачів і водночас розбирали товар: двоє фармацевтів за касами, двоє — порпаються в контейнерах з ліками.
За тиждень–півтора розпродали майже все. Історія повторилася — нам привезли ліки ще з однієї зачиненої аптеки. Так і викручувалися, поки не відновилося постачання. Тоді і наші відвідувачі, і ми зітхнули з полегшенням.
В завідувачки за замовчуванням
Воєнні будні не давали розслабитися. «Аптека Низькі Ціни №1» залишилася без керівництва — завідувач виїхав. Дівчата продовжували працювати. Відповідальність за ситуацію взяла на себе Владлена. Коли вона зателефонувала куратору, щоб дізнатися, кому повідомляти про рішення, прийняті колегами, у відповідь почула: «Тобі, ми ще три дні тому призначили тебе завідувачкою. Більше немає на кого покластися, допоможи нам, у тебе є досвід і хороші рекомендації». Збентежена дівчина трохи здивувалася такому «нестандартному» рішенню, але підкорилася. «Так потрібно компанії, значить, я зроблю все, щоб не підвести її. Дівчата мої всі розумниці і досвідчені, працювали на совість, не жалілися, що складно або страшно. Дуже дякую своєму колективу, сама б я не впоралась».
Владлена виконала дану собі обіцянку. Харківська «Аптека Низькі Ціни №1» працює всю війну. Дівчина опікується колегами, відвідувачами, бабусею з дідусем і мамою.
«Найстрашнішим моїм спогадом був період, коли мама не виходила на зв’язок. Вона живе в Циркунах, які довгий час перебували під окупацією. Інтернет і мобільний зв’язок ледь жевріли. Їй доводилося залазити на дах будинку, щоб зателефонувати. Спочатку я сварила її за це, бо дуже хвилювалася, щоб її не поранили. А коли кілька днів не чула її голос, то подумки кричала: «Ну, лізь вже на той дах! Хоч на хвилинку!». Мама ніби чула і дзвонила. Я видихала. А на роботі боятися не було ані часу, ані сил. Графік був дуже напружений, людей стільки, що іноді і води попити ніколи. Зараз головне — дбати про тих, хто поруч. Для мене це в першу чергу наші клієнти».
У фарватері
/ березень
• •
modern-pharmacy.com.ua У фарватері галузі 35

Журнал
• 2023
Секрет незламності Владлени Жєвєдєвої: «Роби, що маєш, і нехай буде, що має бути». Цей девіз жодного разу не підвів молоду завідувачку, яка не побоялася відповідальності і успішно воює за здоров’я людей на своєму фармацевтичному фронті. •
«Сучасна фармація» галузі
ДЕКАСАН ® —

ІНГАЛЯЦІЙНА
ПРОТИДІЯ ВІРУСАМ
ТА БАКТЕРІЯМ
AІрина Кучма, кандидат медичних наук, доцент кафедри мікробіології,бактеріології, вірусології та імунології навчально-наукового медичного
інституту НТУ «ХПІ»
Людини, яка нікола в житті не застуджувалася і не підхоплювала застуду чи грип, швидше за все, в світі не існує. Ці хвороби хоч і викликані різними вірусами, але мають подібні симптоми: першіння в горлі, кашель, риніт, слабкість тощо. З подібними проблемами рано чи пізно стикаються всі. Тому питання про те, які препарати проти застуди і грипу найбільш ефективні, завжди залишається актуальним.
ГРІ в структурі інфекційної патології займають провідне місце та складають до 90 %. Експерти Всесвітньої організації охорони здоров’я відзначають, що ГРІ — найпоширеніша в людській популяції група захворювань, яка в останні роки має постійну тенденцію до збільшення. Навіть у міжепідемічний період на них хворіє 1/6 частина населення планети. В Україні
щорічно з приводу ГРІ звертається від 10 до 14 млн. осіб, що становить 25–30 % усієї та близько 75–90 %
інфекційної захворюваності в Україні.
ГРІ небезпечні не лише як інфекційні
захворювання, асоційовані з розладом дихальної функції (є причиною розвитку важких синдромів — бронхообструктивного та гіпертермічного, синдрому крупу; і бактеріальних ускладнень — пневмонія, середній отит, риносинусіти), а й як патологічні стани, здатні порушувати стійкість функціонування імунітету, спричиняти погіршення перебігу хронічних неінфекційних захворювань, у тому числі сер-
цево-судинних, аутоімунних, метаболічних (передусім цукрового діабету) [7, 8].
Гостра респіраторна
Повітряний шлях поширення та висока сприйнятливість населення до усіх збудників, що є причиною ГРІ, зумовлює їх епідеміологічну особливість — швидкість та широту розповсюдження. Соціальні причини, що пов’язані з глобальним процесом постійного зростання урбанізації, більш тісні контакти людей практично в будь-якій точці земної кулі та посилення міжконтинентальних міграційних процесів також сприятимуть подальшому поширенню ГРІ [7].
інфекція (ГРІ) визначається як будь-яка
гостра інфекційна хвороба верхніх або нижніх дихальних шляхів, що супроводжується розвитком респіраторного синдрому та загально інтоксикаційними проявами різного ступеня вираженості.
Збудниками ГРІ можуть бути як віруси, так і бактерії. Найчастіше причиною ГРІ є віруси, і тоді такі захворювання зазвичай визначають як гострі респіраторні вірусні інфекції (ГРВІ). На сьогодні відомо понад 300 різноманітних вірусів — збудників ГРВІ — це грип, парагрип, аденовіруси, респіраторно-синцитіальний вірус тощо. Віруси
не тільки спричинюють самостійне заго-




36 Журнал «Сучасна фармація» • modern-pharmacy.com.ua • 2023 / березень • У фарватері галузі • Фармакотерапія
стрення, але й прий мають участь у вірус-індукованому
порушенні антибактеріального
захисту в альвеолярних макрофагах людини, що робить хворого вразливим до додаткової бактеріальної інфекції.

Для частини ГРВІ існує певна «вибірковість»
Клінічні прояви ГРІ та ГРВІ багато в чому схожі, диференціювати їх часто неможливо. Респіраторний синдром є провідним і проявляється в переважно топічному (локальному) ураженні дихальних шляхів — фарингіт, ларингіт, трахеїт тощо. Інфекції верхніх дихальних шляхів включають в себе гострий риносинусит, гострий середній отит, фарингіт/тонзиліт і ларингіт. Інфекції нижніх дихальних шляхів — трахеїт, гострий бронхіт, бронхіоліт та пневмонію [7, 8].
пошук етіотропного лікування із використанням препаратів з противірусним спектром дії. З іншого боку доведена роль бактеріальної мікрофлори в етіології ГРВІ, що формує умови для призначення антибактеріальних препаратів.
ураження верхніх дихальних шляхів, пов’язана з рецепторно-лігандними взаємовідносинами, що дозволяє клінічно запідозрити етіологію ГРВІ.
Відповідно до «Уніфікованого клінічного протоколу первинної медичної допомоги дорослим та дітям при гострих респіраторних інфекціях»
існує три стратегії лікування антибактеріальними препаратами [7]:




непризначення (повна відмова від антибактеріальних лікарських засобів);
відкладене у часі призначення антибактеріальних
лікарських засобів (при якому застосування антибактеріальних лікарських засобів дозволяється

На фоні такої різноманітності уражень та клінічних проявів дуже гостро стає питання раціонального лікування та призначення лікарських засобів різних фармакологічних груп. Оскільки в етіології ГРВІ провідне значення мають віруси, актуальним є
через певний часовий проміжок, у випадку погіршення клінічного стану або відсутності позитивної динаміки);
негайне призначення антибактеріальних лікарських засобів.
Антибіотикорезистентність — виклик сьогодення
Згідно з даними Всесвітньої глобальної системи моніторингу антимікробної стійкості (GLASS) стійкість бактерій до антибіотиків зростає з кожним роком. У 2019 році було зареєстровано майже 5 млн. смертей внаслідок антибіотикорезістентності (АБР) у всьому світі [9, 13]. За даними експертів ВООЗ до 2050 року ця цифра збільшиться до 10 млн. чоловік [11, 14, 15]. На сьогодні причиною АБР є не тільки безконтрольне застосування антибіотиків у практичній медицині, а і у ветеринарії, сільському господарстві, а також їх потрапляння в ґрунт і воду. За даними Державного науково-дослідного інституту антибіотики виявляються в 40 % зразків м’яса і м’ясних продуктів і в 25 % зразків молока, а їх тривале знаходження в продуктах харчування сприяє потраплянню антибіотиків до організму людини та формуванню стійкості до антибактеріальних препаратів [13]. Внаслідок цього лікування багатьох інфекційних захворювань, зокрема, респіраторних (пневмонії, бронхіти, бронхіоліти, навіть туберкульозу), стає важчим.
Боротьба з АБР є пріоритетом ВООЗ, яка розробила та опублікувала документ під назвою «Глобальна стратегія ВООЗ зі стримування антибіотикорезистентності» (WHO Global Strategy for Containment of Antimicrobial Resistance), в якому закріплені основні напрямки роботи задля стримування розвитку та поширення стійких штамів, а саме зменшення розповсюдження бактеріальних інфекцій, забезпечення дотримання нормативно-правових актів щодо раціонального використання протимікробних препаратів та заохочення виготовлення нових антибіотиків та вакцин [14].
ЦЕ ЦІКАВО!!!
У 1945 році за відкриття пеніциліну Флемінгу, Чейну і Флорі було присуджено Нобелівську премію, що ознаменувало початок ери антибіотиків. І хоча антибіотики вважають найвидатнішим відкриттям у медицині XX сторіччя й універсальною зброєю проти більшості патогенів, проте поява резистентності до них загрожує поверненням в доантибіотикову еру. А якщо врахувати, що сучасне комфортне життя серйозно послабило імунітет людини, повернення в «допеніцилінову» еру може стати для світу тим самим апокаліпсисом, про який так багато говорять.


Флорі Ернст Борис Чейн Олександр
Журнал «Сучасна фармація» • modern-pharmacy.com.ua • 2023 / березень • У фарватері галузі • Фармакотерапія 37
Хоуард Уолтер
Флемінг
Враховуючи рекомендації «Уніфікованого клінічного протоколу
первинної медичної допомоги дорослим та дітям при гострих респіраторних інфекціях» остаточне вирішення щодо призначення антибактеріального препарату має спиратися на потреби пацієнта з огляду на його проблеми та очікування щодо використання антибіотиків, які будуть визначені під час медичної консультації у дорослих та дітей з
ГРІ в закладах первинної медичної допомоги [7]. В закладах охорони
здоров’я, що надають первинну медичну допомогу, з метою терапії ГРІ використовують емпіричне антибактеріальне лікування, а отже, має бути обраний лікарський засіб, який має не лише антибактеріальну, а й противірусну активність. У свою чергу, ефективне лікування визначається не лише правильним вибором антибактеріальних засобів, а й великою мірою залежить від способу доставки лікарського засобу в дихальні шляхи. Тому одне із значущих місць у протоколах ведення хворих на ГРІ займає небулайзерна терапія [1, 7].
На сьогодні одним із перспективних, доступних і ефективних шляхів боротьби з інфекційними збудниками є застосування четвертинних амонієвих сполук у якості антисептичних засобів. Вони належать до поверхнево-активних речовин, добре розчиняються у воді та мають детергентні властивості. Ці речовини порушують проникність цитоплазматичної мембрани мікробних клітин, інгібують пов’язані з мембраною ферменти, необоротно порушують функцію мікробної клітини. Антисептики групи четвертинних амонієвих сполук характеризуються низькою токсичністю та низькою сенсибілізуючою дією, не подразнюють шкіру і слизові оболонки [10].
Одним із таких універсальних антибактеріальних засобів із широким спектром дії та потужним місцевим ефектом є ДЕКАСАН® у вигляді стерильного розчину в небулах виробництва фармацевтичної компанії «Юрія-Фарм» (Україна) [4].
ЦЕ ВАЖЛИВО!!!
Декаметоксин внесений до електронної бази даних
хімічних сполук і сумішей PubChem, яка існує з 2004 року, належить Національному центру біотехнологічної


інформації США (NCBI) і є підрозділом Національної медичної бібліотеки США (PubMed).
Етапи розвитку ГРЗ (ГРВІ):
Ураження чутливого епітелію верхніх дихальних шляхів (ВДШ). Розмноження вірусів в епітелії ВДШ та його ушкодження.
Генералізація процесу, вірусемія, ураження судинної стінки з розвитком вторинних процесів.
Формування системної клітинної імунної відповіді, стимуляція розвитку серологічного захисту.
Усунення інфекційного процесу, розвиток серологічного захисту, репаративні процеси відновлення.
Небулайзерна терапія — сучасно й ефективно

Небулайзерна терапія — метод доставки ліків безпосередньо у вогнище ураження за допомогою небулайзера (розпилювача), приладу, що перетворює розчини лікарських засобів в аерозоль (рівень доказовості ІА). У рекомендаціях Европейського респіраторного і Британського торакального товариств перевагу в способі доставки ліків надано небулайзеру завдяки тому, що: введення ліків безпосередньо в «шоковий» орган, що забезпечує безпосередню доставку препарату, виключаючи його резорбтивну дію на інші органи, а також створення вищої концентрації лікарського засобу у дихальних шляхах; дозволяє істотно знижувати дозування лікарських засобів, а за необхідності дає можливість використання високих доз препарату і досягнення ефекту за короткий проміжок часу [14];
можливість використання у будь-якому віці (у дітей, літніх та ослаблених пацієнтів), це неінвазивний метод, який не чинить травмувального
впливу на психіку, що дуже важливо при лікуванні дітей [1];
не потребує додаткових зусиль для виконання процедури (відсутня необхідність синхронізації глибокого вдиху і застосування

пристрою, як при використанні дозованих інгаляторів).

38 Журнал «Сучасна фармація» • modern-pharmacy.com.ua • 2023 / березень • У фарватері галузі • Фармакотерапія
Саме лікарський засіб ДЕКАСАН® у небулах є таким, що значно покращує фармакокінетику і фармакодинаміку декаметоксину і позитивно впливає на комплаенс пацієнтів до терапії.
НА ЗАМІТКУ!!!
Особливості небулайзерної терапії
Всмоктування ліків через слизову оболонку дихальних шляхів відбувається у 20 разів швидше, ніж при прийомі таблетованих форм. Терапевтичний ефект при цьому настає при меншій
дозі речовини та обумовлений тим, що ліки у формі аерозолю
набувають величезної сумарної площі, а отже, і обумовлюють
більш високу фізичну та терапевтичну доступність та активність, впливаючи безпосередньо на вогнище запального процесу.
Спектр дії декаметоксину (ДЕКАСАНУ®)
ДЕКАСАН® має широкий спектр протимікробної, антипротозойної та противірусної дії, виявляє десенсибілізуючі і протизапальні властивості. Механізм дії декаметоксину полягає в деструкції та підвищенні проникності мікробної стінки, інактивації екзотоксину, пригніченні
синтезу білка виключно в клітинах бактерії збудника. Особливість дії препарату базується на його здатності з’єднуватися з ліпідними структурами, порушувати проникність клітинної мембрани, що призводить до порушення гомеостазу всередині клітин, яка зумовлює лізис останніх. Вибірковість дії препарату проявляється у відсутності впливу на здорові клітини організму, оскільки стінка бактеріальної клітини складається з коротких ліпідних ланцюжків, які швидко руйнуються під впливом декаметоксину ( ДЕКАСАНУ®), тоді як довгі ліпідні ланцюжки клітин людини не зазнають впливу його молекул [1, 4, 6].
Декаметоксин (ДЕКАСАН®) чинить:
вiруліцидну дiю на складні ліпофільні віруси грипу A, B, простого герпесу, вірус везикулярного стоматиту, ВІЛ, віруси гепатиту), зокрема виражену дію на SARS-CoV-2;
бактерицидний вплив на грампозитивні (стафiлококи, стрептококи, коринебактерії, капсульнi бактерії) і грамнегативні мікроорганізми (синьогнійна паличка, ешерихії, сальмонели, шигели, клебсієли, вібріони);
фунгiцидну дiю на дрiжджi, дрiжджоподiбнi гриби, збудники епiдермофiтiї, трихофiтiї, мiкроспорiї, еритразми, деякi види плiсневих грибiв (аспергiли, пенiцили);
протипротозойну дiю на трихомонади, лямблії;
руйнує екзотоксини бактерій і знижує адгезію коринебактерій, сальмонел, стафілококів.
ДЕКАСАН® у формі небул є засобом вибору для лікування
ГРІ як у дорослих, так і у дітей, що підтверджено


клінічними дослідженнями
В період сезонного збільшення захворюваності на ГРІ та ГРВІ особливого значення набуває саме віруліцидна дія ДЕКАСАНУ®. В експериментальному дослідженні, проведеному на базі Одеського науково-дослідного інституту вірусології та епідеміології ім. І.І. Мечникова, визначено, що механізм віруліцидної дії декаметоксину (ДЕКАСАНУ®) реалізується за рахунок руйнування ліпідного шару суперкапсидної оболонки складних вірусів, до яких відноситься
Клінічні ознаки, що характерні для ГРІ:
1. Скарги: більше чи менше виражені симптоми загальної інтоксикації, катаральні симптоми — дряпання, значно рідше — біль у горлі, нежить, сухий кашель.
2. Помірна гіперемія, в основному піднебінних дужок, м’якого піднебіння, язичка, задньої стінки глотки із наявністю зернистості (збільшені лімфатичні фолікули).
3. Гіперемія слизової оболонки носових ходів.
4. Мигдалики переважно інтактні (за винятком аденовірусної інфекції).
5. Кон’юнктивіт (виражений більше чи менше, залежно від виду респіраторної інфекції).
6. Ознаки ураження декількох відділів верхніх дихальних шляхів.

7. Для кожного виду є характерним найтяжче ураження певного відділу верхніх дихальних шляхів з розвитком характерної симптоматики.

Журнал
• modern-pharmacy.com.ua • 2023 / березень • У фарватері галузі • Фармакотерапія 39
«Сучасна фармація»
Антибіотикорезистентність —
явище набуття мікроорганізмами стійкості до дії антибіотичних препаратів. «Проблемні» мікроорганізми, які мають уже сформовані механізми резистентності до антибіотиків широкого спектру дії, об’єднані у групу ESKAPE: Enterococcus faecium, Staphylococcus aureus, Klebsiella pneumoniae, Acinetobacter baumannii, Pseudomonas aeruginosa, Enterobacter spp.
вірус грипу людини А і В, везикулярного стоматиту, вірус простого герпесу 1 та 2 типу. Декаметоксин
( ДЕКАСАН®) пригнічує процеси репродук-


ції вірусів, на стадіях проникнення в
клітину та реплікації вірусної нуклеїнової кислоти. Дослідження in vitro


продемонстрували можливість
ушкодження вірусної протеази, розвитком віруліцидного ефекту і на позаклітинні віруси [3].
Використання 0,02% розчину
Декасану® по 2 мл кожні 12 годин у вигляді небулайзерної терапії продемонструвало його високу ефективність
мічали покращення загального стану. Середня тривалість лікування дітей з ГРЗ склала 6 діб. Застосування препарату показало його хорошу переносимість у дітей [12].
За фармакодинамічними та фармакокінетичинми характеристиками декаметоксин повністю відповідає вимогам до антисептичного препарату для лікування ГРІ.
при лікуванні дітей віком від 1 місяця до 3 років з ГРІ [12]. Курс лікування складав від 3 до 7 діб. Показанням для призначення даного препарату були клінічні прояви ГРІ, діагноз установлювався на підставі клініко-лабораторних даних. На фоні проведеної терапії ДЕКАСАНОМ® виявлений позитивний клінічний ефект у 90 % хворих дітей – стійкі зменшення явищ проявів ГРЗ спостерігались уже на 2 добу після призначення препарату. Наприкінці першого тижня лікування респіраторні ознаки захворювання
залишилися тільки у 3 хворих дітей, але всі вони від-
Головна
Додавання ДЕКАСАНУ® до комплексної терапії вірусно-бактеріальних негоспітальних пневмоній у дорослих (інгаляції через небулайзер двічі на добу по 2 мл 0,02% розчину протягом 5-7 діб) достовірно знижувало частоту інфекційних ускладнень, тривалість антибіотикотерапії, а також термін досягнення позитивних результатів лікування [2]. Доведено посилення протимікробної ефективності антибіотиків цефалоспоринової, карбапенемової, аміноглікозидної, фторхінолонової, поліміксинової груп у присутності декаметоксину ( ДЕКАСАНУ®) щодо акінетобактерій та псевдомонад. Утворення стiйких до декаметоксину (ДЕКАСАНУ®) форм мікроорганізмів при тривалому застосуваннi вiдбувається повiльно i не перевищує ефективних концентрацiй препарату. У процесi лiкування препаратом підвищується чутливість АБР мiкроорганiзмiв до антибiотикiв.
— профіль безпеки препарату ДЕКАСАНУ®
Питання токсичності та безпеки, а також можливі побічні ефекти декаметоксину ( ДЕКАСАНУ®) ґрунтовно вивчені на доклінічному етапі. Визначено, що декаметоксин ( ДЕКАСАН®) за результатами тестів реакції гіперчутливості сповільненого типу та за кількістю антитіло утворюючих клітин у селезінці, титрів гемаглютинінів в сироватці крові не чинить
токсичної дії на гуморальну та клітинну імунну відповідь.
За показниками хромосомних аберацій у клітинах кісткового мозку мишей встановлено відсутність мутагенних властивостей препарату. Було доведено, що препарат не спричиняє порушень репродуктивної функції самців та самок щурів, не викликає ембріоле-
увага
40 Журнал «Сучасна фармація» • modern-pharmacy.com.ua • 2023 / березень • У фарватері галузі • Фармакотерапія
тальної дії, не чинить негативного впливу на розвиток нащадків [5].
Також підтверджено відсутність місцевоподразнювальної дії декаметоксину ( ДЕКАСАНУ®) при введенні до кон’юнктивального мішка ока кролів. Субстанція декаметоксину не виявляє здатності до кумуляції в дослідах на щурах. Додатковими перевагами декаметоксину ( ДЕКАСАНУ®) є здатність до інактивації мікробних токсинів та протизапальні властивості.
Отже, призначення інгаляційного антисептика ДЕКАСАН® на старті терапії ГРІ є етіологічно
обґрунтованим, відповідає рекомендаціям
«Уніфікованого клінічного протоколу
первинної медичної допомоги дорослим та
дітям при гострих респіраторних інфекціях», є раціональним з приводу формування
антибіотикорезистентності та комплаенса
пацієнтів до лікування.
Список використаних джерел:


1. Березна Т.Г. Персоніфікований підхід до лікування гострих бронхітів у дітей: міфи чи практика, що заснована на доказах? — Здоров’я України. Тематичний номер «Пульмонологія, Алергологія, Ринологія». — 2022. — № 1 (58)-2(59). — С. 15-17. https://health-ua.com/ multimedia/7/0/3/0/3/ 1663316184.pdf.
2. Боророва Е.Л. Ефективність і безпека застосування декаметоксину у комплексному лікуванні пацієнтів з вірусно-бактеріальною негоспітальною пневмонією III клінічної групи. — Infusion & Chemotherapy. — 2021. — № 1. — С. 15-21. DOI: 10.32902/2663-0338-2021-1-15-21
3. Гридіна Т.Л. Противірусні властивості офіціальних препаратів декаметоксину, етонію та унітіолу по відношенню до вірусів грипу і простого герпесу: Дис... канд. біол. наук: 03.00.06. — Одеса, 2008. — 139 с.
4. Декаметоксин. Інструкція до застосування. https:// mozdocs.kiev.ua/likiview.php?id=6195.
5. Деркач Н.В., Штриголь С.Ю., Лар’яновская Ю.Б., Кошова О.Ю., Ковальова Є.О. Специфічна токсичність препарату «Декасан». — Клінічна та експериментальна патологія. — 2016. — Т.XV, № 2 (56), Ч.1. — С. 59-66.
6. Довідник лікарських препаратів Компендіум. Декасан. https://compendium.com.ua/dec/270258/
7. Уніфікований клінічний протокол первинної медичної допомоги дорослим та дітям. Гострі респіраторні інфекції. — Наказ Міністерства охорони здоров’я України 16 липня 2014 р. № 499 (у редакції наказу Міністерства охорони здоров’я України від 11.02.2016 № 85). https://www. dec.gov.ua/wp-content/uploads/2019/11/2014_499ykpmd_ gri.pdf.
8. Клінічні рекомендації з діагностики, лікування та профілактики ГРВІ у дітей раннього віку: навчальний посібник / С. О. Мокія-Сербіна, Н. В. Василенко, Т. В. Литвинова, В. А. Шелевицька; ДЗ «Дніпропетровська медична академія МОЗ України» ; МОЗ України. — 2-е вид., стереотип. — Кривий Ріг : Вид. Р. А. Козлов, 2015. — 158 с. 9. Назарчук О. А., Нагайчук В. І. Антибіотикорезистентність Acinetobacter baumannii як збудника хірургічної ін-
фекції та підходи до її подолання з використанням антисептика декаметоксину. — Journal of Perioperative Medicine. — 2018. — Т 1, № 2. — С. 18-22. DOI: 10.31636/ prmd.v1i2.2
10. Палій Г.К., Ковальчук В.П., Деркач Н.М., Палій Д.В. Обґрунтування ефективності антисептичного препарату декасан в лікуванні хворих на гнійно-запальні захворювання. — Український хіміотерапевтичний журнал. — 2010. — № 1-2 (23). — С. 78-82.
11. Райлян М.В., Васюра В.М., Делікатна І.С. Основні причини зростання антибіотикорезистентності та шляхи вирішення проблеми. — 2018. — Збірник тез наукових робіт учасників міжнар. наук.-практ. конф. «Теоретичні та практичні аспекти розвитку сучасної медицини», 2223 червня 2018 р., М. Львів. — С. 80-82.
12. Січенко П.І., Бугаєнко В.О., Кропятник Н.П. та ін. Декасан в інгаляційній терапії гострих респіраторних захворювань у дітей раннього віку. — Актуальні питання теоретичної та клінічної медицини: збірник тез доповідей Міжнародної науково-практичної конференції студентів та молодих вчених, м. Суми, 10-12 квітня 2013 р. / Відп. за вип. М.В. Погорєлов. — Суми: СумДУ, 2013. — С. 156.
13. Тимощук С.А., Симочко Л.Ю. Поширення антибіотикорезистентних мікроорганізмів у навколишньому природному середовищі. — Екологічні науки. — 2020. — № 2 (29). Т. 2. — С. 11-15. DOI https://doi.org/10.32846/23069716/2020.eco.2-29.2.2.
14. Christopher J.L., Murray Kevin, Shunji Ikuta, et al. Global burden of bacterial antimicrobial resistance in 2019: a systematic analysis. — e Lancet. — 2022. — DOI: https:// doi.org/10.1016/S0140-6736(21)02724-0.
15. The Review on Antimicrobial Resistance. Tackling drugresistant infections globally: final report and recommendations (2016). Ed: Jim O’Neill // UK Government and Wellcome Trust, 2016. https://amrreview.org/sites/default/files/160525_Final %20paper_ with %20cover.pdf.


Журнал «Сучасна фармація» • modern-pharmacy.com.ua • 2023 / березень • У фарватері галузі • Фармакотерапія 41
АВАНАЛАВ



НА ВАРТІ
ВІДНОВЛЕННЯ
СЕКСУАЛЬНОГО ЗДОРОВ’Я
Сексуальна активність — необхідна складова життя всіх жителів планети. Дослідники в області медицини змогли довести, що секс — це не тільки потреба, але і ключ до здоров’я. Він зберігає молодість всього організму, підтримує людину в тонусі, стимулює відновлювальні процеси в клітинах, впливає на всі внутрішні органи людини. Для сильної половини людства здатність підтримати повноцінність сексуальної функції — одне із важливих критеріїв, якими чоловіки часто оцінюють не лише своє фізичне здоров’я, а й власну мужність і соціальну значущість. Адже практично кожному чоловікові у будь-якому віці хочеться виглядати в очах оточуючих молодим, сильним, активним, сексуальним та впевненим у своїх силах.

У кожного чоловіка рано чи пізно настає такий період, коли його «сексуальні апетити» зменшуються, так звана еректильна дисфункція. За даними Всесвітньої організації охорони здоров’я, порушення ерекції спостерігається у кожного десятого чоловіка старше 21 року. У віці 40–50 років — у 40 %, в 50–60 років — у 48–57 %, після 60-ти років — проблема наздоганяє кожного третього чоловіка. Оскільки більшість чоловіків вважають дану проблему особистою і «ганебною», тільки 22,2 % з них звертаються за допомогою до фахівців.
ЧОМУ У ЧОЛОВІКІВ ВИНИКАЮТЬ ПРОБЛЕМИ
З ЕРЕКЦІЄЮ?
психологічні — в результаті стресу, депресії, неврозу, хронічної втоми чи страху зазнати невдачі при статевому акті;
запальні процеси сечостатевої системи;
судинні: вроджені (обумовлені дисфункцією венозної системи) та набуті (зустрічаються у більш пізньому віці в зв’язку із ураженням артерій); гормональні — пов’язані з порушенням роботи залоз внутрішньої секреції, які відповідають за секрецію тестостерону та інших статевих гормонів;
неврологічні
захворювання, ураження центральної та периферичної нервової системи;
спосіб життя: гіподинамія, шкідливі звички та ін.
NEW
ЕРЕКЦІЯ —
дуже чутливий
барометр
психологічного стану
чоловіка, тому вона легко зникає, коли є страх, невпевненість, а її епізодична
відсутність не вказує на розвиток еректильної
дисфункції.
ЦЕ ЦІКАВО!!!
В Індії еректильну дисфункцію ліку-

вали вареними в рослинній олії яйцями алігатора, жаби чи горобця. Їх
чистили, розтирали та змащували підошви стоп чоловіків.
В Європі темою «чоловічої сили»
займалася церква, тому лікуван-

ня знайти не намагалися. Головною
причиною імпотенції церковні авторитети назвали дію бісівських сил.
Науковий підхід у вивченні імпотенції виник тільки до кінця XIX століття.
У праці «Статева слабкість чоловіків» (1883) вказано, що причиною імпотенції є ранні статеві зв’язки. Чим вище сексуальна активність чоловіка, тим швидше він її витратить і захворіє статевим безсиллям.
«Прорив» у лікуванні еректильної дисфункції пов’язаний з появою першого високоефективного
перорального препарату для лікування еректильної дисфункції з групи інгібіторів ФЕД-5 — силденафілу.
Відкриття цієї речовини, а точніше його ефектів щодо ерекції, сталося внаслідок сприятливого збігу
обставин. У процесі клінічних випробувань черговий антиангіналь-
ний препарат у багатьох хворих
призводив до розвитку своєрідного
«побічного ефекту», що полягав у поліпшенні еректильної функції.
Віртуальна реальність у поєднанні
з низькою руховою активністю
фактично крадуть тестостерон
у чоловіків. Якщо рівень гормону
підвищити, то цілком імовірно, що
чоловіка більше тягнутиме до жінки, а не комп’ютера.
Проблема чоловічої потенції хвилювала навіть неандертальців та кроманьйонців — в наскальному живописі можна побачити оголених людей із зображенням статевих органів. Пізніше, із розвитком релігії, із великими фалосами зображали фігури богів, які відповідали за родючість. Перші згадки про імпотенцію зустрічаються в писемних джерелах VIII ст. до н.е. в Стародавній Індії. Індуси вважали, що основні причини імпотенції психологічні, наприклад, після статевого акту із невродливою жінкою.
Лікування еректильної дисфункції вимагає комплексного підходу та поєднує як немедикаментозні, так і медикаментозні способи. Перші полягають у зміні способу життя: відмова від шкідливих звичок, заняття спортом, зниження ваги, боротьба із стресогенними чинниками. Ідеальна терапія еректильної дисфункції включає такі аспекти як простота, неінвазивність, висока ефективність та відсутність виражених побічних ефектів.
Інгібітори фосфодіестерази 5 типу (ФДЕ-5) є препаратами першої лінії лікування еректильної дисфункції згідно рекомендаціям Американської асоціації урологів та Європейської асоціації урологів. Пригнічення руйнування циклічного гуанозин монофосфату оксиду азоту призводить до різкого зростання його концентрації в клітинах, в яких основною формою фосфодіестераз є саме ФДЕ-5. У клітинах гладкої мускулатури це викликає розслаблення, а у разі кавернозних артерій дозволяє посилювати приплив крові до кавернозних тіл і, як наслідок, сприяє розвитку ерекції.
Подальше вдосконалення фармацевтичних технологій виробництва дало можливість виділити більш селективні молекули, ніж представники першого покоління інгібіторів ФЕД-5, які активно впроваджуються в протоколи лікування і є основою пероральної терапії еректильної дисфункції. Одним із таких унікальних та сучасних представників інгібіторів ФДЕ-5 є препарат АВАНАЛАВ, представлений
на фармацевтичному ринку
АТ «Київський вітамінний завод».
NB!
АВАНАЛАВ містить діючу речовину аванафілу, який є єдиним селективним інгібітором ізоферменту ФДЕ-5 з нижчою частотою побічних ефектів у порівнянні з іншими препаратами даної групи та розвиває ефективність протягом приблизно 15хв після прийому.
ТРИВАЛІСТЬ ДІЇ — АВАНАЛАВ діє протягом 6-8 годин, що дозволяє здійснити кілька статевих контактів із невеликим періодом відновлення.
ШВИДКІСТЬ
ДІЇ —


АВАНАЛАВ вважається
одним із найбільш
швидкодіючих інгібіторів фосфодіестерази 5-го типу. Діяти препарат починає вже ЧЕРЕЗ 15
ХВИЛИН після прийому. Для порівняння, максимальний ефект
при прийомі силденафілу та
варденафілу настає не менш, ніж через 60 хвилин, а тадалафілу — до 2 годин.
ВИСОКА ЕФЕКТИВНІСТЬ: аналіз чотирьох рандомізованих контрольованих досліджень, в якому загалом взяли участь1381 пацієнтів, показав, що аванафіл (АВАНАЛАВ) дозою 100 мг був достовірно ефективнішим, аніж плацебо (в середньому в 3 рази). Дози 100 та 200 мг добре переносились.
ВІДСУТНІСТЬ
ЗАЛЕЖНОСТІ ерекції від прийому їжі.
АВАНАЛАВ діє незалежно
від часу застосування, що забезпечує зручність для пацієнта та підвищує його прихильність до лікування.

ГНУЧКІСТЬ ДОЗУВАННЯ.
АВАНАЛАВ випускається в двох дозування: по 50 та 100 мг аванафілу в 1 таблетці, а наявність упаковок препарату із різною кількістю таблеток (№ 1 та № 4) повністю відповідає сучасним потребам ринку та уподобанням споживачів.
Переваги
Переваги
АВАНАЛАВУ — єдиного








вітчизняного
аванафілу









ВИСОКА БЕЗПЕКА
ТА НИЗЬКА ЧАСТОТА ПОБІЧНИХ ЕФЕКТІВ.
Аванафіл має унікальний фармакокінетичний профіль. Препарат не накопичується в крові, що мінімізує ризик передозування та виникнення небажаних реакцій. Під час прийому аванафілу протягом понад 52 діб, лише близько 2 % пацієнтів припинили лікування через небажані реакції.
ВІДСУТНІСТЬ ПОТРЕБИ В КОРЕКЦІЇ
ДОЗИ в залежності від віку, функції нирок та печінки. Аванафіл характеризується швидким всмоктуванням, з кінцевим періодом
напіввиведення протягом 5 годин після прийому, завдяки чому не вимагається корекції дози в залежності від стану функції нирок, печінки і віку.
АВАНАЛАВ може вживатися в поєднанні із багатьма рецептурними лікарськими засобами. ПРИ ПСИХОГЕННИХ ПОРУШЕННЯХ (синдром тривожного очікування невдачі) АВАНАЛАВ допомагає подолати психологічний бар’єр — ерекція не зникає при впливі провокуючих факторів (під час надягання презервативу, через сторонні звуки тощо).
АВАНАЛАВУ — єдиного вітчизняного аванафілу
ВИБІР
АВАНАЛАВ діє незалежно від часу застосування, при цьому необхідно пам’ятати про те, що дія препарату розвивається тільки на тлі адекватного сексуального збудження та значною мірою залежить від нього.
В Україні препарат АВАНАЛАВ активно
впроваджується у практику терапії
еректильної дисфункції з можливою
перспективою використання даного
інгібітору ФДЕ-5 як препарату другої лінії
при деяких урологічних захворюваннях
(доброякісна гіперплазія передміхурової
залози, синдром хронічного тазового болю).
Великий наголос при цьому робиться на його
ефективність та високий профіль безпеки як препарату 2-го покоління інгібіторів ФДЕ-5.
Обирай АВАНАЛАВ виробництва
АТ «КИЇВСЬКИЙ
ВІТАМІННИЙ ЗАВОД»:
без хвилювання про ефективність;
без хвилювання про швидкість та тривалість ефекту;
без хвилювання про безпеку та побічні явища.
ШАНОВНІ ЧИТАЧІ!
Якщо у Вас є поетичний талант або Ви тільки починаєте пробувати свої сили, Ви креативна та творча особистість, тоді цей конкурс саме для Вас!
з 5 по 27 квітня
Редакція журналу «Сучасна фармація» запрошує лікарів та фармацевтів до участі в поетичному конкурсі – написати вірш про лікарський препарат «АВАНАЛАВ»!
Памʼятайте – не перемагає той, хто не бере участь

Редакційна рада обере п’ять найкращих робіт, автори яких отримають цінні призи. Роботи та імена переможців ми опублікуємо на сторінці журналу «Сучасна фармація» соціальної мережі Facebook.
ПІДВЕДЕННЯ ПІДСУМКІВ КОНКУРСУ ТА НАГОРОДЖЕННЯ ПЕРЕМОЖЦІВ ВІДБУДЕТЬСЯ 30 КВІТНЯ
Надсилайте свої роботи на електронну адресу редакції
журналу «Сучасна фармація» publicpharmacy@gmail.com У листі повинна бути вказана Ваша контактна інформація: ПІБ, телефон та місце роботи.



тел.: (057) 780-70-77, (067) 578-65-15

АВАНАЛАВ — ТВЕРДИЙ
УСПІШНИХ ЧОЛОВІКІВ! NB!
ПОЕТИЧНИЙ КОНКУРС
АЛЕРГІЯ НА
АМБРОЗІЮ:
агресивність пилку
визначається



місцем його
походження та навколишнім
середовищем
Різні географічні та кліматичні регіони, з яких походить пилок амброзії, а також ступінь забруднення навколишнього середовища можуть впливати на
тяжкість алергічних реакцій, таких як сінна лихоманка та астма. Пилок рослин у
різних районах виявляє різний рівень агресивності. До такого висновку прийшла міжуніверситетська дослідницька група під керівництвом MedUni Vienna за участю Віденського університету та Університету природних ресурсів і прикладних наук. Дослідження нещодавно було опубліковано в журналі Frontiers in Allergy.
Дослідницька група розробила модель алергії, в якій миші вдихали пилок рослин амброзії (Ambrosia artemisiifolia), зібрані в різних географічних місцях. Вони виявили, що навіть невеликої кількості пилку (загалом 180 пилкових зерен) достатньо для виникнення алергічної реакції, що набагато менше, ніж висока концентрація пилку в повітрі під час сезонного періоду цвітіння. Через зміну клімату європейський період цвітіння подовжується, і рослина здатна поширитися в більш північні райони. Крім того, регіональне походження пилку визначає тяжкість алергічної реакції, яку вона викликає. Провідний дослідник і координатор проекту «Атопіка» Мішель Епштейн з MedUni Vienna пояснила, що пилок з різних середо-
вищ може відрізнятися за своєю агресивністю. Амброзія полинолиста (Ambrosia artemisiifolia)

є високоалергенною рослиною, пилок якої викликає сінну лихоманку у чутливих людей і може призвести
до астми. В даний час понад 33 мільйони європейців страждають від алергії на амброзію, і дослідники прогнозують збільшення до 77 мільйонів випадків до 2060 року в результаті зміни клімату. Річний економічний тягар ЄС від алергічної астми вже оцінюється в 151 мільярд євро.
Вольфрам Векверт, професор кафедри функціональної та еволюційної екології Віденського університету та один з авторів, сказав, що фактори навколишнього середовища змінюють агресивність пилку. Наступні кроки — це подальше визначення характеристик пилку, особливо на молекулярному рівні, щоб однозначно визначити суміш алергенних компонентів. Герхард Каррер, професор ботаніки в Університеті природних ресурсів і прикладних наук, який був частиною команди, що збирала пилок в Австрії, сказав, що боротьба з амброзією є серйозною проблемою громадського здоров’я та стратегією адаптації для пом’якшення та управління наслідками зміни клімату. На думку дослідників, існує висока ймовірність того, що зміна клімату та інші фактори навколишнього середовища також вплинуть на ряд інших рослин, що виробляють пилок. Ця прикладна дослідницька модель тепер забезпечує стратегію для подальших досліджень впливу зміни клімату на алергію на пилок. Джерело: https://www.sciencedaily.com

46 Журнал «Сучасна фармація» • modern-pharmacy.com.ua • 2023 / березень • У фарватері галузі • Арсенал знань


АРСЕНАЛ ЗНАНЬ АРСЕНАЛ ЗНАНЬ
c.49
Доппельгерц — надійний спосіб врятувати гаджетомана
c.53
МОЗ розширює електронний рецепт на всі рецептурні препарати

c.54
На допомогу фахівцю: Як ефективно лікувати кашель
c.60
Хвороби королів чи прокляття династій? Історичні нариси

c.64
Як пережити передменструальний дисфоричний розлад?

c.66
Очні краплі «Хіло-комод» — незамінний помічник в лікуванні синдрому сухого ока
c.72
Вдома краще: Як впоратися
з непростими почуттями
Summum bonum medicīnae sanĭtas








Найвище благо
медицини – здоров’я
A

Мінакова Світлана, канд. мед. наук, офтальмолог
Очі — дзеркало душі і завдяки ним ми можемо бачити життя у найяскравіших



фарбах. Але на жаль, ми рідко замислюємося
про те, що неправильне освітлення, нераціональне харчування та екрани гаджетів стомлюють очі, що призводить до розвитку офтальмологічних захворювань.
В останні десятиліття спостерігається зростання набутих захворювань очей. Так, близько 80 % школярів в Україні страждають від комп’ютерного синдрому (А. Риков, 2005), а понад 30 % дітей віком до 18 років страждають на короткозорість (І. Кужда, 2006, Д. Етан, 2010). До того ж, за даними всесвітньої організації охорони здоров’я (ВООЗ) від вікової макулярної дегенерації (ВМД) у всьому світі страждає понад 25 мільйонів людей похилого віку, а до 2025 року захворюваність потроїться.
надійний спосіб
врятувати
гаджетомана
Світло моє — ворог мій або подорож світлового променя в оці
Кожен орган має свою функцію і свої «професійні шкідливості». Наприклад, для ока досить негативним фактором є світло, при цьому не має значення, йдеться про природне сонячне світло або про штучне освітлення.
Так, ультрафіолетове світло становить певну небезпеку для людини, хоч і є невидимим. Вся область ультрафіолетового випромінювання умовно ділиться на ближню та далеку. Близький УФ-діапазон, у свою чергу, поділяється на три складові — UVA, UVB та UVC, які відрізняються за своїм впливом на організм людини. UVC (довжина хвилі 200–280 нм) — є найбільш короткохвильовим та високоенергетичним ультрафіолетовим випромінюванням. UVB (280–315нм) — це випромінювання середньої енергії і становить небезпеку для ока людини! Саме UVB сприяє виникненню уражень рогівки — фотокератиту, а в екстремальних умовах — і захворювань шкіри. UVB — практично повністю поглинається рогівкою, але частина UVBдіапазону (300–315 нм) може проникати в око! UVA — це найбільш довгохвильова і найменш енергетична складова ультрафіолету з діапазоном довжин хвиль 315–380 нм. Частина цих променів поглинається рогівкою, а більшість — кришталиком.

На відміну від ультрафіолету, синє світло є видимим. Саме сині світлові хвилі надають забарвлення неба (або будьякого іншого предмета). До синього світла відносяться хвилі з довжиною хвилі від 380 до 500 нм.

Журнал «Сучасна фармація» • modern-pharmacy.com.ua • 2023 / березень • Арсенал знань • Експертна думка 49
Відомо, що з віком кришталик каламутніє, пропускає менше світла, у тому числі й синього. Тому найбільша проникність для синього кольору — у вічі
дитини, яка вже активно користується гаджетами. З цієї ж причини найбільше ризикують користувачі
гаджетів зі штучним кришталиком без фільтру від синього світла. Ультрафіолетові, а переважно сині промені згубні
для структур ока. Потрапляючи на рогівку, вони не відбиваються, а токсично діють на її епітелій, що призводить до печіння, світлобоязні, почервоніння очей — так починається комп’ютерний синдром. Посилює
цей синдром рідкісне моргання за екраном комп’ютера чи смартфона. В результаті рогівка не змочується сльозою та приєднується відчуття сухості.
Під час «спілкування» з гаджетами у дітей та підлітків відбувається постійне фокусування зору на короткі відстані та різко зростає навантаження на
зорові м’язи, що призводить до розвитку у них спазму.

Крім цього, синє світло цих гаджетів запускає каскад
біохімічних реакцій.
Так, світлові промені, потрапляючи на сітківку, руйнують її фоторецептори — палички та колбочки — особливі клітини, що перетворюють світло на нервові імпульси, які потім надходять у головний мозок, де й формуються зорові образи. При народженні людині
дано величезний стратегічний запас: 7 мільйонів колбочок та 120 мільйонів паличок, які дозволяють добре бачити вдень та вночі. Однак під впливом світла їх кількість зменшується, що з часом викликає зниження зору, а в деяких випадках навіть загрожує сліпотою. У повній темряві зоровий пігмент родопсин і фотопсин, що містяться в паличках та колбочках, повинні відновлюватися. Однак, коли людина дні та ночі проводить за комп’ютером та зі смартфоном у руці, запаси білка вже не встигають поповнитись.
Під впливом світла фоторецептори руйнуються та
утворюються вільні радикали, які згодом викликають
Ö²ÊÀÂÎ:



помутніння в кришталику та дистрофічні зміни сітківки. Утворення вільних радикалів у тканинах очей відбувається під впливом світла постійно, незалежно від того, чи насолоджується людина красою пейзажу, захоплено читає книгу чи працює за комп’ютером. Тому тривалі зорові навантаження, зловживання гаджетами, нестача вітамінів у раціоні можуть призвести до розвитку початку спазму циліарного м’яза, а надалі — до формування короткозорості.
До станів, що найчастіше зустрічаються, та захворювань органу зору, які обумовлені впливом на око ультрафіолетового та синього світла, відносяться:
комп’ютерний синдром; спазм циліарного м’яза; короткозорість; вікова макулярна дегенерація.

Найчастіше ці стани випливають один з одного і знаходяться у безпосередньому причинно-наслідковому зв’язку. Так, наприклад, комп’ютерний синдром, що «помолодшав», може довгий час залишатися непоміченим у дитини та в результаті приводити до розвитку функціонального, поки що оборотного, спазму
ВСІ ЛЮДИ У СВІТІ МАЮТЬ КАРИЙ КОЛІР
Меланін — пігмент, що зумовлює колір очей.
ОЧЕЙ!
Точніше — кількість пігменту визначає колір райдужної
оболонки людини. Так, у карооких — максимальна
кількість пігменту, а у блакитнооких —
його мінімальна кількість. Меланін поглинає
світлові промені, тим самим захищаючи сітківку та перешкоджає її пошкодженню. Тому блакитні та сірі очі
потенційно більш схильні до розвитку ВМД, тому що їхні очі містять меншу кількість пігменту меланіну.
При цьому блакитні очі пропускають у внутрішні
структури в 100 разів більше світла, ніж карі очі!
50 Журнал «Сучасна фармація» • modern-pharmacy.com.ua • 2023 / березень • Арсенал знань • Експертна думка
акомодації. Однак згодом за відсутності належного лікування спазм трансформується в короткозорість.
У деяких випадках з віком міопія ускладнюється дегенеративними змінами на сітківці.
Вікова макулярна дегенерація розвивається у людей після 50 років на тлі хронічних супутніх захворювань організму. Однак і тут не обходиться без впли-
ЧИ ІСНУЮТЬ ПАСТКИ

Пошкоджують очі не всі світлові промені, а лише ті з них, які проникають крізь світлозахисний бар’єр. Природа передбачила механізм захисту очей від шкідливої дії світлових променів, інакше люди були б буквально приречені на сліпоту. Завдяки природній системі захисту найбільше шкідлива, синьо-фіолетова частина світлового спектру не проникає крізь світлозахисний бар’єр, а вільні радикали нейтралізуються.
Природним фільтром або пасткою для шкідливих світлових променів є природні пігменти — каротиноїди — лютеїн та зеаксантин, які накопичуються в паличках, колбочках, кришталику і поглинають ці промені. Таким чином лютеїн та зеаксантин відповідають за функціонування антиоксидантної системи ока.



Накопичені в сітківці лютеїн та зеаксантин захищають пігментний епітелій сітківки від ушкоджуючого впливу світлових променів, особливо фіолетової та синьої частини світлового спектру. Крім того, лютеїн та зеаксантин є ефективними інгібіторами вільних радикалів у пігментному шарі сітківки.
Крім лютеїну та зеаксантину є ряд речовин, які є потужними антиоксидантами — це вітаміни А, Е, С, мікроелементи цинк, антоціани та флавоноїди.
Вітамін А (ретинол) сприяє омолодженню популяції усіх клітин організму, покращує процес регенерації, має антиоксидантну та імуномоделюючу дію. Використовується для синтезу зорового пурпуру, що відповідає за нічний зір. Його недостатність загрожує порушенням колірного сприйняття та погіршенням бачення у темряві. Вітамін А підтримує процес акомодації та темнової адаптації.
Вітамін Е (токоферол)
бігти пошкодженню сітківки ультрафіолетом та запобігти катаракті.
Вітамін С (аскорбінова кислота)
знижує ймовірність появи катаракти. У співдружності з каротиноїдами захищає сітківку від впливу світла та вільних радикалів, тим самим запобігає окисленню зорових пігментів і перешкоджає їх втраті. Зменшує проникність та ламкість
ву ультрафіолетових та синіх світлових променів, які надають додаткову шкідливу дію на пігментний епітелій сітківки. При його руйнуванні утворюються вільні радикали, які ушкоджують палички та колбочки. Продукти метаболізму, що утворилися, накопичуються на сітківці з утворенням «друз» і викликають її дегенерацію.
капілярів, що особливо важливо при діабетичній ретинопатії. Цинк сприяє підтримці здорового зору. Цей мікроелемент є постійною складовою частиною тканин ока і забезпечує його нормальний метаболізм та відновлення кліткових структур, є необхідним для засвоєння організмом вітамінів А та Е, а також є природнім активатором більш ніж 200 ферментів. Він перешкоджає утворенню вільних радикалів. Крім того, цинк попереджає старіння кришталика
та розвиток катаракти. Дефіцит цинку в організмі пов’язують з відшаруванням сітківки, розвитком ретробульбарного невриту, блефариту та порушенням кольоророзрізнення.
Антоціани чорниці та флавоноїди лимона сприяють синтезу зорового пігменту родопсину, який відповідає за сутінковий зір та покращують стан капілярів сітківки, відповідно. Покращуючи місцевий кровообіг, чорниця сприяє регенерації тканин сітківки.
Цікаво, що під час Другої світової війни англійські льотчики їли чорницю і
Крім того, як лютеїн, так і екстракт чорниці, володіючи антиоксидантним ефектом, запобігають пошкодженню сітківки та помутнінню кришталика, сприяють зміцненню судин та уповільнюють вікові зміни у тканинах ока.
ДЛЯ СВІТЛОВИХ ПРОМЕНІВ?
Журнал «Сучасна фармація» • modern-pharmacy.com.ua • 2023 / березень • Арсенал знань • Експертна думка 51
ЗАХИСТИТИ ЗОРОВІ


КЛІТИНИ ВІД ГОЛОДНОЇ
СМЕРТІ!
Головні воїни антиоксидантної системи ока — каротиноїди, флавоноїди, вітаміни А, Е, С, цинк потрапляють в організм тільки з їжею та практично не синтезуються у організмі.
Так, добова потреба у лютеїні
становить 5 мг, а зеаксантині —
1 мг. Для того, щоб забезпечити
їх достатнє надходження з їжею, необхідно вживати не менше півтора кілограма моркви і 0,5 кілограма солодкого перцю на добу!
Тим, чиї очі відчувають інтенсивні зорові навантаження, необхідно щодня з’їдати ще більше. Однак щоденний раціон здатний
компенсувати ледве чи третину
від добової потреби в каротино-
їдах, флавоноїдах та вітамінах, тому додатковий прийом нутри-
цевтиків є життєвою необхідністю підтримки здоров’я очей.
ЗАСОБАМ МОЖНА ДОВІРИТИ СВОЇ ОЧІ?

Такими вітамінними
комплексами є препарати німецької компанії Квайссер Фарма — Доппельгерц актив вітаміни для очей із лютеїном і Доппельгерц актив вітаміни для очей з чорницею.
У складі Доппельгерц актив вітаміни для очей з лютеїном: лютеїн, зеаксантин, вітаміни А, С, Е та цинк.
У складі Доппельгерц актив вітаміни для очей з чорницею: порошок плодів чорниці, лютеїн, вітамін А, цинк, лимонний біофлавоноїдний комплекс.
Дані вітамінні комплекси є джерелом каротиноїдів, біофлавоноїдів, антоціанів та посилені вітамінами А, Е, С та цинком.
Також є вітамінний комплекс для дітей із 3-х років у вигляді жувальних пастилок зі смаком лісових ягід. Ситуація, коли дитина їсть із планшетом або телефоном, зараз не рідкість. Захистити дитячі очі допоможуть вітаміни Доппельгерц актив Кіндер з лютеїном, вітаміном А, Е, В2 , цинком та бета-каротином. Не мають у складі консервантів, штучних барвників, глютену та лактози.
За рахунок складу представлені вітамінно-мінеральні комплекси характеризуються найширшим спектром показань для застосування:
зниження стомлюваності при роботі за комп’ютером, керування автомобілем;
захист від впливу ультрафіолетових променів та синього спектру світла;
поліпшення адаптації до темряви;
зниження ризику розвитку макулярної дегенерації та катаракти;
як додаткове джерело антиоксидантів в організмі.
СПОСІБ ТА ДОЗИ ЗАСТОСУВАННЯ: Дорослим та дітям після 12 років — по 1 капсулі 1 раз на день під час або після їжі.
Курс прийому — від 1 до 3 місяців.
Кіндер вітаміни для очей для дітей з 3-х років по 1 жувальній таблетці, а з 7-ми років по 2 жув. таблетки.
Переваги даних комплексів у порівнянні
з іншими очевидні:
бренд, заснований у 1897 році, який на сьогоднішній день завоював довіру пацієнтів у більш ніж 50 країнах світу;
зручність застосування — 1 раз на добу;
доступна цінова категорія при високій німецькій якості; оптимальне поєднання антиоксидантів у добовому дозуванні.
Дякую, що знайшли час і прочитали цю статтю, а весь цей час ваші очі працювали! Скажемо ж їм «дякую» — подбаємо про них за допомогою Доппельгерц актив вітамінів для очей!
ТОЖ ЯКИМ
52 Журнал «Сучасна фармація» • modern-pharmacy.com.ua • 2023 / березень • Арсенал знань • Експертна думка
ЕЛЕКТРОННИЙ РЕЦЕПТ НА ВСІ РЕЦЕПТУРНІ ПРЕПАРАТИ
Для того, аби спростити процес призначення ліків, зробити його ефективнішим та сучасним, весною 2023 року МОЗ впроваджує електронний рецепт на всі рецептурні ліки. Також це дозволить посилити контроль за відпуском рецептурних ліків у аптеках. До цього переліку відносяться зокрема: антибіотики, протисудомні засоби, гормональні препарати (у тому числі й гормональні контрацептиви), препарати для лікування артеріального тиску, серцевих хвороб, деякі антигельмінтні препарати, деякі вітаміни, кроворозріджуючі препарати, антидепресанти, нейролептики та релаксанти, деякі лікарські засоби із групи анальгетиків, протикашльових, антигістамінних та заспокійливих лікарських засобів.


На сьогодні електронний рецепт є одним із найпоширеніших електронних медичних інструментів в Україні. Наразі в електронній системі охорони здоров’я міститься близько 550 тисяч рецептів на антибіотики та ще понад 11 тисяч — на наркотичні (психотропні) лікарські засоби.
НА ЯКІ ЛІКИ БУДЕ ПОТРІБЕН ЕЛЕКТРОННИЙ
РЕЦЕПТ?
Електронний рецепт пошириться на зареєстровані
в Україні лікарські засоби, що підлягають відпуску за рецептом лікаря та які пацієнт купує за власні кошти. ЧИ БУДУТЬ ЩЕ ДІЯТИ ПАПЕРОВІ РЕЦЕПТИ?
Рішення буде впроваджуватися поступово: за відсутності світла чи зв’язку у медичному закладі лікар, як і раніше, може виписати рецепт на спеціальному паперовому бланку.
ЧИ ПОТРІБНО МАТИ ДЕКЛАРАЦІЮ З СІМЕЙНИМ
ЛІКАРЕМ ДЛЯ ТОГО, ЩОБ ОТРИМАТИ РЕЦЕПТ?
Е-рецепт можна буде отримати незалежно від наявності декларації з сімейним лікарем. Водночас пацієнт має бути обов’язково зареєстрований в електронній
НА ЗАМІТКУ!!!
системі охорони здоров’я — це проста процедура, яку може швидко здійснити будь-який лікар.
ЯКІ ЛІКАРІ БУДУТЬ ВИПИСУВАТИ Е-РЕЦЕПТИ?
Виписати е-рецепт зможуть лікарі усіх спеціальностей державних, комунальних чи приватних клінік, або ж лікар-ФОП. І для цього необов’язково мати договір з НСЗУ.

ЧИ ЗМОЖЕ ЛІКАР ВИПИСАТИ РЕЦЕПТ НА
КОНКРЕТНУ ТОРГОВУ НАЗВУ ЛІКІВ?
Е-рецепт не містить торгових назв препаратів, а лише міжнародну непатентовану назву, іншими словами — діючу речовину. Так пацієнт самостійно приймає рішення щодо бренду лікарського засобу з відповідною діючою речовиною.
ЧИ МОЖНА ПРИДБАТИ МЕНШУ КІЛЬКІСТЬ ЛІКІВ
ЗА РЕЦЕПТОМ, НІЖ ПРИЗНАЧИВ ЛІКАР?
Так, можливо погасити електронний рецепт частково, тобто придбати меншу кількість ліків, аніж призначив лікар. Можливим є одноразове погашення рецепту на мінімальну кількість препарату (наприклад, блістер чи ампулу). При цьому повторно отримувати рецепт для відпуску залишку ліків не потрібно.
АЛГОРИТМ — ЯК ОТРИМАТИ ЛІКИ ЗА Е-РЕЦЕПТОМ
1. Записатися до лікаря первинної ланки, з яким підписано угоду. Варто звернути увагу на те, що участь у програмі «Доступні ліки» можлива лише за умови підписання декларації з лікарем.
2. Прийти на прийом.
3. Лікар має разом з пацієнтом пересвідчитися, що вказаний у декларації номер телефону досі актуальний для пацієнта. Це перевірять за кодом мобільного оператора та останніми цифрами номера.
4. Лікар виписує електронний рецепт в електронній системі охорони здоров’я або дає електронне направлення до лікаря-спеціаліста, який відтак випише електронний рецепт.
5. Пацієнт отримує на мобільний телефон повідомлення з текстом: «Ваш рецепт: ХХХХ-ХХХХ-ХХХХ-ХХХХ.
Код підтвердження: ХХХХ», яке потрібне для отримання ліків в аптеках.
6. Якщо потрібно або на прохання пацієнта лікар може надати пацієнту роздрукований консультаційний висновок із зазначенням даних про виписані електронні рецепти.
7. Під час відвідування аптеки-учасниці урядової програми пацієнт повинен надати номер рецепту.
8. Фармацевт надає пацієнту інформацію щодо наявних препаратів за програмою «Доступні ліки».
9. Обрання пацієнтом із переліку препарату та надання фармацевту чотиризначного коду. Якщо в конкретній аптеці у наявності немає потрібних ліків, пацієнт має право звернутися до іншої аптеки. За матеріалами офіційного сайту МОЗ України
https://moz.gov.ua
МОЗ РОЗШИРЮЄ
Журнал «Сучасна фармація»
• 2023 / березень • Арсенал знань • Події 53
• modern-pharmacy.com.ua
ДОПОМОГУ ФАХІВЦЮ:
Як ефективно
лікувати
кашель
Катерина Лугова, апірантка відділення кардіоревматології Державної установи «Інститут охорони здоров’я дітей та підлітків Національної академії медичних наук України»
Проблема кашлю: про що
він може розповісти та
симптомом яких хвороб
може бути?
Кашель — захисний рефлектор-



ний акт, що відіграє провідну роль
у видаленні з дихальних шляхів мокротиння і сторонніх тіл (часток
пилу, диму, слизу тощо). Кашель виникає при подразненні кашлевих рецепторів внаслідок вдихання аерополютантів, тютюнового диму, затікання назального секрету, запалення слизових оболонок дихальних шляхів тощо [1].
ЦЕ ЦІКАВО:
Найбільше кашлевих рецепторів знаходиться в
гортані, трахеї та місці поділу бронхів. Також вони
є у плеврі, нижній частині стравоходу, шлунку, у
зовнішніх слухових ходах. До речі, безпосередньо
в легенях немає кашлевих рецепторів.
Очевидно, що кашель є однією з найпоширеніших ознак бронхолегеневих захворювань [2]. За даними сучасних епідеміологічних досліджень, кашель — найчастіший симптом, з приводу якого пацієнти звертаються за амбулаторною медичною допомогою [3–4].
Загальносвітова практика свідчить про те, що щорічно ГРВІ переносять близько 500 млн осіб, та загальновідомо, що кожен дорослий у середньому 2–4 рази на рік хворіє на гострі респіраторні захворюваннями. Діти хворіють ще частіше - у середньому до 6 разів протягом року [5].
У цьому контексті дуже цікаві дані щодо економічних витрат на ведення хворих із кашлем. Наприклад, у Великій Британії річні витрати на лікуван-
ня кашлю становлять щонайменше 979 млн фунтів стерлінгів (це близько 44 млрд гривень!!!), при цьому 104 млн фунтів стерлінгів витрачається пацієнтами для придбання безрецептурних лікарських засобів. У США річні витрати на придбання безрецептурних ліків для лікування кашлю й усунення симптомів застуди досягають 3,6 млрд дол. [6]. Ці дані свідчать про те, що кашель — це актуальна проблема, особливо в осіннє-зимовий і весняний період, яка потребує ефективного вирішення.
Розрізняють такі види кашлю залежно від його тривалості:
гострий, який турбує хворого менше трьох тижнів;
підгострий, який триває від трьох до восьми тижнів;
хронічний, що триває більше восьми тижнів.
Виділяють:
продуктивний кашель (з мокротинням);
непродуктивний (сухий).

Гострий кашель, як правило, обумовлений гострими вірусними інфекціями верхніх і нижніх дихальних шляхів. Додатковими досить поширеними причинами гострого кашлю є гострий риносинусит, кашлюк, алергічний риніт, астма, застійна серцева недостатність, пневмонія, різні аспіраційні синдроми, емболія легеневої артерії [7].
Причиною підгострого (постінфекційного) кашлю тривалістю від 3 до 8 тижнів є гіперреактивність бронхів, розвиток трахеобронхіальної дискінезії внаслідок перенесеної вірусної або мікоплазмової (Mycoplasmapneu moniae) та хламідійної (Chlamydophila
A
НА
54 Журнал «Сучасна фармація» • modern-pharmacy.com.ua • 2023 / березень • Арсенал знань • Професійний конкурс
pneumoniae) інфекції. Підгострий кашель часто має затяжний характер і зазвичай нечутливий до стандартної протикашльової терапії [8].



Тривалий або хронічний (понад 8 тижнів) продуктивний кашель може спостерігатися при ХОЗЛ, бронхоектазії, новоутвореннях дихальних шляхів і легень, абсцесі легені [2].
Непродуктивний хронічний кашель нерідко спостерігається у пацієнтів із захворюваннями шлунково-кишкового тракту (гастроезофагеальна рефлюксна хвороба, грижа стравохідного отвору діафрагми), хворобами серцево-судинної системи (серцева недостатність) [9–10]. Нерідко кашель пов’язаний із прийомом деяким лікарських засобів.

Гострий кашель спочатку може бути сильним і нав’язливим, але зазвичай проходить швидко і рідко потребує значного медичного втручання. Гострий і підгострий кашель зазвичай не вимагають спеціальних діагностичних досліджень і підлягають лише симптоматичному лікуванню, якщо звісно немає «червоних прапорців» і підозри на іншу, більш серйозну, патологію. Рентген грудної клітки може бути доцільним, якщо кашель визначається як сильний або якщо пацієнт виглядає дуже хворим.
ЯК НЕ ПРОПУСТИТИ НЕБЕЗПЕКУ: «Червоні прапорці» при кашлі: кашель має хронічний характер і триває понад 8 тижнів; відкашлюється кров чи гнійне мокротиння, є відчуття задишки, утруднення дихання або/та біль у грудях, тривале підвищення температури; є такі симптоми, як незрозуміла втрата ваги й апетиту, стійка зміна голосу, поява набряків на шиї чи значне потовиділення вночі.
Гострий кашель при ГРВІ, як правило, малопродуктивний, часто сухий і минає протягом 2–3 тижнів. Однак у низці випадків кашель при ГРВІ може бути продуктивним, з вираженими порушеннями відходження мокротиння, особливо в ослаблених хворих, осіб похилого й старечого віку, маленьких дітей, пацієнтів, які мають супутні захворювання та ін.
Хронічний кашель — вкрай актуальна проблема для сучасної медицини. Відомо, що скарги на тривалий або постійний кашель виникають у 18 % населення США, 16 % — у Великій Британії, 11 % — у Швеції, 11,9 % — в Італії. В одному з епідеміологічних досліджень у Фінляндії, присвячених проблемі кашлю, яке охоплювало 13980 осіб (79,2 % жінок; середній вік 46,6 року), було виявлено, що 373 пацієнти мали скарги на гострий кашель, 174 — на підгострий і 421 — на хронічний [11]. Автори стверджують, що кашель асоціюється зі збільшенням вірогідності відвідування де-
кількох (трьох і більше) лікарів протягом року, значно знижує якість життя та має істотний соціально-економічний вплив за рахунок збільшення кількості візитів до лікаря та днів відпустки через хворобу.
За розрахунковими даними, близько 600 млн осіб у світі страждають на хронічну обструктивну хворобу легень (ХОЗЛ) [12]. Отже, враховуючи кількість пацієнтів із хронічною патологією бронхолегеневої системи (ХОЗЛ/хронічний бронхіт, бронхіальна астма), стає очевидним, що проблема хронічного кашлю також потребує належної уваги.
СТРАТЕГІЯ ЛІКУВАННЯ КАШЛЮ: ЯКИЙ ЛІКАРСЬКИЙ ЗАСІБ ВИБРАТИ?
Правильний підбір лікарських засобів має вкрай важливе значення, оскільки дозволяє покращити ефективність терапії і зменшити ризик ускладнень.
При продуктивному кашлі необхідно покращувати евакуацію мокротиння з верхніх дихальних шляхів, тому доцільно застосовувати відхаркувальні засоби, які розріджують мокротиння та полегшують його виведення [13].
Відхаркувальні засоби за механізмом дії умовно поділяють на три групи. Препарати першої групи розріджують бронхіальний секрет за рахунок збільшення секреції бронхіальних залоз (переважно водного компонента слизу) і тому називаються секретомоторними відхаркувальними засобами. Муколітики, препарати другої групи, зменшують в’язкість мокротиння внаслідок порушення структури мукополісахаридів, що зумовлюють специфічну консистенцію бронхіального секрету [14–16]. До третьої групи відносяться комбіновані препарати, що містять мукоактивні компоненти різнонаправленої дії.
Журнал «Сучасна фармація» • modern-pharmacy.com.ua • 2023 / березень • Арсенал знань • Професійний конкурс 55
Лікування продуктивного кашлю слід починати якомога швидше, бажано з першого дня його появи, оскільки полегшення відділення в’язкого секрету дозволить уникнути обструкції дихальних шляхів і знизити ймовірність виникнення пневмонії.


Найефективнішими лікарськими засобами для лікування вологого кашлю є муколітики. А гарним профілем безпеки і швидким ефектом володіє група стимуляторів синтезу сурфактанту (амброксолу гідрохлорид).
За своєю хімічною формулою амброксол є похідним бензиламінів: транс-4- [(2-аміно-3,5 дибромбензил)аміно]циклогексанолу гідрохлорид. Це активний N-десметил — метаболіт бромгексину (синтетичного похідного алкалоїду вазіцину), речовини, яку отримують шляхом естракції з рослини Adhatoda vasica (адатода сосудиста). Видалення метильної групи і введення гідроксильної групи в пара-транс-положенні циклогексилового кільця дали амброксолу можливість стимуляції синтезу сурфактанту, надали йому протизапальних, антиоксидантних і місцевих анестетичних властивостей у доповненні до мукокінетичного та мукоциліарного ефектів його вихідної сполуки [17].
Амброксол є активним метаболітом бромгексину і тому має більш виражений мукоактивний ефект. Біодоступність амброксолу становить 70–80 % (у бромгексину — 20 %). Крім того, при пероральному прийомі дія амброксолу починається через 30 хвилин і триває протягом 6–12 годин, при інгаляційному введенні ефект настає швидше (до 15 хвилин) і триває також 6–12 годин [18].
Основними ефектами амброксолу гідрохлориду є муколітичний, мукокінетичний та мукорегуляторний. Муколітичний ефект обумовлений розщепленням кислих мукополісахаридів та дезоксирибонуклеїнової кислоти, нормалізацією співвідношення серозного та слизового компонентів бронхіального секрету зі зниженням в’язкості мокротиння за рахунок активації гідролаз та вивільнення лізосом із клітин Клара. Мукокінетичний ефект амброксолу обумовлений посиленням рухової активності війчастого епітелію з підвищенням мукоциліарного кліренсу. Мукорегуляторна дія амброксолу реалізується внаслідок нормалізації співвідношення серозного та слизового компонентів секрету завдяки підвищенню секреції серозних клітин бронхіальних залоз та стимуляції виділення сурфактанту в альвеолах [19].

Крім того, амброксол має протизапальні властивості , що реалізуються шляхом пригнічення прозапальних цитокінів, а також підвищення активності макрофагів [20]. Завдяки блокуванню виділення серотоніну й гістаміну, амброксол демонструє протинабрякову, помірну знеболюючу й ан-
Амброксол був уперше схвалений для застосування як самостійний лікарський засіб у 1978 р.

Амброксол синтезується з парацетамолу та 2-аміно-3,5 дибромобензальдегіду шляхом послідовних каталітичних реакцій.
У 2012 р. Всесвітня організація охорони здоров’я віднесла цю молекулу до переліку основних лікарських засобів.

Сьогодні амброксол зареєстрований
в усіх країнах — членах Європейського Союзу.

тиоксидантну дію, що пов’язана з блокуванням вільних радикалів.
Амброксол також проявляє імуномодулюючий ефект завдяки здатності активізувати макрофаги й підвищувати синтез секреторних IgA та IgG. Важливими ефектами амброксолу є його противірусні властивості. Відомо, що він знижує реплікацію вірусів грипу, парагрипу, риновірусу шляхом стимуляції синтезу ендогенного сурфактанту та блокування протеаз верхніх і нижніх дихальних шляхів [21].
Практично значущою властивістю амброксолу є його здатність підвищувати концентрацію антибіотиків у альвеолах та на слизовій оболонці бронхів. Цей ефект реалізується завдяки підвищенню швидкості пасивної дифузії антибіотиків із кровоносних судин у легеневу тканину без зміни їх концентрації у плазмі крові [22]. Цей ефект може сприяти скороченню курсу антибіотикотерапії та пришвидшенню одужання хворого.
Отже, амброксол потенціює дію антибіотиків, сприяючи збільшенню їхньої концентрації в осередку інфекції. У пацієнтів з ХОЗЛ терапія амброксолом призводила до значного зниження кількості загострень.
56 Журнал «Сучасна фармація» • modern-pharmacy.com.ua • 2023 / березень • Арсенал знань • Професійний конкурс
ЦЕ ЦІКАВО:
Біоплівка — це не просто скупчення бактерій на слизовій оболонці чи тканині, а складна конструкція, яка складається з клітинного компоненту асоціації культур мікроорганізмів і позаклітинного матриксу з біологічної суміші полісахаридів, глікопептидів, нуклеїнових кислот і ліпідів.
У 60 % випадків розвитку хронічних і рецидивуючих інфекцій, що не піддаються лікуванню, встановлена значуща роль біоплівок. У медичному аспекті ключовою особливістю біоплівки є те, що у ній мікроорганізми набувають нових властивостей, підвищується їхня стійкість до антибіотиків. В епідеміологічних дослідженнях встановлено, що генетична інформація про антибіотикорезистентність може передаватися від штаму до штаму в межах моно- або полімікробних біоплівок, що істотно ускладнює лікування нозокоміальних інфекцій [23, 24].
Зазначалося достовірне зменшення тривалості загострень і скорочення тривалості антибіотикотерапії [25].
Також амброксол чинить помірний опосередкований вплив на процеси формування біоплівок патогенів, порушуючи їх структурну цілісність і впливаючи на деякі етапи їх розвитку.
Амброксол не провокує бронхообструкції.
K.J. Weissman і співавт. продемонстрували статистично достовірне поліпшення показників функції зовнішнього дихання у хворих з бронхообструкцією
і зменшення гіпоксемії на фоні прийому амброксолу.
Слід зазначити, що в країнах Європи саме амброксол є лікарським засобом, що н айчастіше призначається . Так, у Німеччині у 2015 р. його частка на ринку мукоактивних засобів склала 24 % [26]. Для амброксолу існує велика доказова база щодо застосування у хворих з продуктивним кашлем. Найважливіше значення має дослідження H. Matthys та ін. з вивчення ефективності різних лікарських засобів у хворих на ГРВІ. Це великомасштабне плацебоконтрольоване дослідження з 4 паралельними групами, за результатами якого амброксол поряд з іншими препаратами значно перевершував плацебо за впливом на кашель. В інших дослідженнях застосування амброксолу призводило до покращення якості життя та зменшення частоти загострень хронічного бронхіту [27].
Ефективність амброксолу доведена у низці порівняльних досліджень при лікуванні гострих інфекцій респіраторного тракту у дітей. Наприклад, у пацієнтів із бронхітом застосування амброксолу сприяло більш швидкому регресу клінічних симптомів порівняно з ацетилцистеїном [28]. Подібні результати були отримані при порівнянні ефективності амброксолу й карбоцистеїну у лікуванні гострого кашлю. У всіх цитованих дослідженнях відзначено гарну переносимість препарату.
В останні роки вивчаються нові можливості застосування амброксолу у лікуванні ГРВІ, оскільки відкрита його здатність пригнічувати потенціалзалежні натрієві канали, розташовані на чутливих нервових закінченнях. Це надає анальгезуючий ефект та зменшує такі прояви застуди, як біль у горлі [15].
У дослідженні С. de Mey зі співав. вивчалася ефективність і переносимість перорального спрею з розчином амброксолу для полегшення гострого болю в горлі при гострому неускладненому фарингіті у порівнянні з розпиленням плацебо. Встановлено, що розпилювальний розчин, що містив 10 мг амброксолу в кожній дозі (що відповідає одному струменю РЕСПИКС® СПРЕЮ), показав статистично значуще поліпшення ефекту послаблення болю. Послаблення болю в горлі виникало вже через 15 хв після дозування спрею. Відзначено, що лікування спреями з амброксолом дуже добре переноситься пацієнтами [30].
РЕСПИКС® СПРЕЙ — інноваційний прорив у лікуванні кашлю при ГРВІ
На сьогоднішній день
РЕСПИКС® СПРЕЙ — перший і єдиний в Україні зареєстрований розчин амброксолу у вигляді дозованого спрею.
Він починає діяти вже у слизовій оболонці
ротової порожнини, що значно пришвидшує ефект і приносить
швидке полегшення.

Склад: амброксолу гідрохлорид 50 мг (5 % розчин)
Допоміжні речовини: Левоментол, Амонію гліциризат (екстракт кореню солодки) та ін.
РЕСПИКС® СПРЕЙ володіє такими терапевтичними ефектами:
полегшує відкашлювання і зменшує вираженість продуктивного кашлю;

протизапальна й антиоксидантна дія;

місцева анестезуюча дія — важлива при лікуванні гострих інфекцій дихальних шляхів, зокрема для зменшення болю в горлі та полегшення болю у грудях при кашлі;

Журнал «Сучасна фармація» • modern-pharmacy.com.ua • 2023 / березень • Арсенал знань • Професійний конкурс 57
сприяє зменшенню кількості загострень ХОЗЛ;
при одночасному призначенні з антибіотиками підвищує їх концентрацію в бронхіальному секреті й мокротинні;
противовірусна дія (блокує рецептори ICAM-1
за допомогою яких вірус потрапляє в клітину);
імуномодулююча дія (збільшує синтез IgA в 10 разів; IgМ на 12 %; протеїну А (SP-A) до 170 %);
зменшує ризик розвитку бактеріальних ускладнень.
Безпека й переносимість амброксолу пацієнтами з
гострими та хронічними захворюваннями легень доведена у численних рандомізованих контрольованих дослідженнях. Найпоширеніші побічні ефекти амброксолу спостерігалися з боку шлунково-кишкового тракту. Однак вони зустрічаються з дуже низькою частотою та не вимагають відміни лікарського засобу. Дані аналітичного огляду безпеки амброксолу, виконаного PRAC, переконливо свідчать про вкрай низький ризик виникнення важких шкірних побічних реакції та анафілактичних реакцій [29].
РЕСПИКС® СПРЕЙ показаний:
Для лікування гострих і хронічних бронхолегеневих захворювань, що супроводжуються порушенням утворення та виведення слизу, — дорослим і
дітям від 12 років.
Список використаної літератури
1. Chung KF, McGarvey L, Song WJ, Chang AB, Lai K, Canning BJ, Birring SS, Smith JA, Mazzone SB. Cough hypersensitivity and chronic cough. Nat Rev Dis Primers. 2022 Jun 30;8(1):45
2. Asthma Workgroup, Chinese Society, Respiratory, Diseases (CSRD), Chinese Medical Association. e Chinese national guidelines on diagnosis and management of cough (December 2010). Chinese Medical Journal 2011 Oct;124(20):3207-19.
3. Finley C, Chan DS, Garrison S, Korownyk C, Kolber MR, Campbell S, Eurich DT, Lindblad AJ, Vandermeer B, Allan GM. What are the most common conditions in primary care? Systematic review. Canadian Family Physician 2018 Nov;64(11):832-40.
4. Morice A. Epidemiology of cough. Pulmonary Pharmacology and erapeutics 2002;15(3):253-9.

5. Bergmann, M., Haasenritter, J., Beidatsch, D. et al. Coughing children in family practice and primary care: a systematic review of prevalence, aetiology and prognosis. BMC Pediatr 21, 260 (2021).
6. Marathe PA, Kamat SK, Tripathi RK, Raut SB, Khatri NP. Over-the-counter medicines: Global perspective and Indian scenario. J Postgrad Med. 2020 Jan-Mar;66(1):28-34.

7. Sandeep Sharma; Muhammad F. Hashmi; Mohamed S. Alhajjaj. Cough. National Library of Medicine, August 18, 2022.
8. Braman SS. Postinfectious cough: ACCP evidence-based clinical practice guidelines. Chest. 2006 Jan;129(1 Suppl):138S-146S.
9. Saritas Yuksel E, Vaezi M. Extraesophageal manifestations of gastroesophageal re ux disease: cough, asthma, laryngitis, chest pain. Swiss Med Wkly. 2012 Mar. 11.
10. Irwin R, Curley FJ, French CL. Chronic cough. e spectrum and frequency of causes, key components of the diagnostic evaluation, and outcome of speci c therapy. e American Review of Respiratory Disease 1990 Mar;141(3):640-7.
11. Koskela HO, Lätti AM, Pekkanen J. e impacts of cough: a cross-sectional study in a Finnish adult employee population. ERJ Open Research 2018 Nov 12;4(4). pii: 00113-2018. doi: 10.1183/23120541.00113-2018. eCollection 2018 Oct.
12. Global strategy for the diagnosis, management and prevention of COPD. Global Initiative for Chronic Obstructive Lung Disease (GOLD). Update 2019. Available from: http://www.goldcopd.org Accessed 2018 Dec 12.
13. Liesl Brown. Dry and wet coughs. ResearchGate, Oct, 2020.
14. Rogers D.F. Mucoaktive agents for airway mucus hypersecretory diseases// Respir Care. — 2007 Sep. — 52 (9). — P. 1176-93.
15. Morice A, Kardos P. Comprehensive evidence-based review on European antitussives. BMJ Open Respiratory Research 2016 Aug;3(1):e000137.
Для полегшення вираженого болю у горлі при неускладнених респіраторних захворюваннях у дорослих.
Завдяки високій концентрації амброксолу та інноваційній формі випуску РЕСПИКС® СПРЕЙ:
полегшує кашель вже за 30 хвилин;
містить у 8 разів більшу концентрацію амброксолу, завдяки чому протягом 3 діб позбавляє від симптомів фарингіту (почервоніння, набряк і біль у горлі);
повністю готовий до застосування, можливість прийому «на ходу»;
не містить штучних барвників і підсолоджувачів, тому може бути препаратом вибору при схильності пацієнта до алергічних проявів і може застосовуватися у хворих на цукровий діабет або у пацієнтів з порушеннями толерантності до глюкози.
РЕСПИКС® СПРЕЙ забезпечує лікування всього респіраторного тракту, а не його окремої ділянки. Він є зручним у застосуванні, що сприяє комплайенсу пацієнтів. Завдяки місцевій анестезуючій дії полегшує виражений біль у горлі, що усуває необхідність придбання додаткових лікарських засобів і робить лікування більш економічно доступним.
16. Dicpinigaitis PV, Morice AH, Birring SS, McGarvey L, Smith JA, Canning BJ, Page CP. Antitussive drugs — past, present, and future. Pharmacological Reviews 2014 Mar;66(2):468-512.
17. Gupta PR. Ambroxol — resurgence of an old molecule as an anti-in ammatory agent in chronic obstructive airway diseases. Lung India 2010 Apr;27(2):46-8.
18. Disse BG, Ziegler HW. Pharmacodynamic mechanism and therapeutic activity of ambroxol in animal experiments. Respiration 1987;51(Suppl 1):15-22.
19. Ahmad Kantar, Ludger Klimek, Dorotheea Cazan,Annette Sperl, Ulrike Sent, Margarida Mesquita. An overview of e cacy and safety of ambroxol for the treatment of acute and chronic respiratory diseases with a special regard to children. Multidisciplinary Respiratory Medicine 2020; volume 15:511
20. Chenot J.F., Weber P., Friede T. E cacy of Ambroxol lozenges for pharyngitis: a meta-analysis// BMC Fam. Pract. — 2014. — 15. — 45.
21. Yamaya M., Nishimura H., Nadine L.K. et al. Ambroxol inhibits rhinovirus infection in primary cultures of human tracheal epithelial cells // Arch. Pharm. Res. — 2013, Jul. 16.
22. Кривопустов С.П. Комбінована мукоактивна терапія у дітей із захворюваннями дихальних шляхів, що супроводжуються утворенням в’язкого секрету // Здоров’я дитини. — 2017. — Т. 12, № 2. — С. 30-31.
23. Flemming H.C., Wingender J. e bio lm matrix // Nat. Rev. Microbiol. — 2010. — 8. — 623-33.
24. M. Cataldi, V. Sblendorio, A. Leo, O. Piazza. Bio lm-dependent airway infections: A role for ambroxol? Pulmonary Pharmacology & erapeutics, Volume 28, Issue 2, 2014.
25. Дуда О.К., Бойко В.О., Коцюбайло Л.П. Амброксол у комплексному лікуванні хворих на гострі респіраторні захворювання. Новости медицины и фармации. 13 (589) 2016.
26. Morice A, Kardos P. Comprehensive evidence-based review on European antitussives. BMJ Open Respiratory Research 2016 Aug;3(1):e000137.
27. Malerba M, Ragnoli B. Ambroxol in the 21st century: pharmacological and clinical update. Expert Opinion on Drug Metabolizm & Toxicology 2008 Aug;4(8):1119-29.
28. Baldini G, Gucci M, Tarò D, Memmini C. A controlled study on the action of a new formulation of ambroxol in asthmatiform bronchitis in children. Minerva Pediatrica 1989 Feb;41(2):91-5.
29. Cazan D, Klimek L, Sperl A, Plomer M, Kölsch S. Safety of ambroxol in the treatment of airway diseases in adult patients. Expert Opinion on Drug Safety 2018 Dec;17(12):1211-24.

30. De Mey C, Patel J, Lakha DR, Richter E, Koelsch S. E cacy and Safety of an Oral Ambroxol Spray in the Treatment of Acute Uncomplicated Sore roat. Drug Res (Stuttg). 2015 Dec;65(12):658-67. doi: 10.1055/s-0035-1547229.

РЕСПИКС® СПРЕЙ — єдиний в Україні 5 % розчин амброксолу у формі дозованного спрею! 58 Журнал «Сучасна фармація» • modern-pharmacy.com.ua • 2023 / березень • Арсенал знань • Професійний конкурс
при

Фармацевтична опіка пацієнтів

відпуску з аптеки РЕСПИКС® СПРЕЙ
РЕСПИКС® СПРЕЙ є першим і єдиним зареєстрованим лікарським засобом амброксолу у формі спрею на фармацевтичному ринку України. Відпуск РЕСПИКС® СПРЕЮ із аптеки може потребувати обговорення з пацієнтом наступних питань:
1. Спрей призначений для перорального (внутрішнього) застосування.

2. Рекомендовану дозу (три струмені спрею) розпилюють безпосередньо у ротову порожнину, після чого його проковтують.
3. РЕСПИКС® СПРЕЙ необхідно приймати разом з їжею або після їди.
4. Муколітична активність РЕСПИКС® СПРЕЙ підтримується вживанням великої кількості рідини.

5. Стандартна доза становить три струмені спрею 3 рази на добу.
6. Без консультації лікаря лікування може тривати не більше 4–5 днів.


7. У разі застосування для полегшення вираженого болю у горлі при неускладнених респіраторних захворюваннях без консультації лікаря, застосовувати не більше 3 днів.
отримані знання у реальній практичній ситуації!
ПРАКТИЧНА ЗАДАЧА:
В аптеку звернувся хворий на ГРВІ чоловік. Лікар призначив йому амброксол, але окрім кашлю, пацієнт має скарги на біль у горлі.
Який швидкодіючий муколітичний засіб з комплексною дією Ви порадите відвідувачу аптеки для полегшення відходження густого і в’язкого мокротиння, а також для зменшення болю у горлі?
ВІДПОВІДЬ:
Доцільно придбати РЕСПИКС® СПРЕЙ (амброксол у формі спрею), який сприяє відходженню мокротиння при вологому кашлі і зменшує больові відчуття у горлі. Він містить активну речовину амброксол, яка розріджує мокротиння і сприяє його виведенню з дихальних шляхів, полегшуючи відкашлювання і сприяючи найшвидшому одужанню.
Застосовуйте
РЕСПИКС® СПРЕЙ приймай — кашель та біль у горлі долай! Журнал «Сучасна фармація» • modern-pharmacy.com.ua • 2023 / березень • Арсенал знань • Професійний конкурс 59
Хвороби королів чи




прокляття
династій?
Історичні нариси

За часів, коли у світі процвітали монархії, територію держави можна було вважати володіннями королівських сімей. Щоб зберегти всі
державні блага у своїх руках, представники династій часто укладали
шлюби з особами своєї ж родини. Про таку науку, як генетика в ті
часи ще ніхто не знав, тому багато королівських родин страждали спадковими захворюваннями. Крім того, здоров’я деяких королів погіршувалося через їх специфічний спосіб життя.
Прокляття Тутанхамона
У Стародавньому

Єгипті статевий зв’язок між кровними родичами був досить поширеним явищем. Фараони укладали шлюби зі своїми сестрами, тим самим підриваючи здоров’я наступним поколінням. Жертвою такого шлюбу став фараон Тутанхамон. Примітно, що Тутанхамон завжди зображувався сидячим на троні. Виявляється, молодий фараон мав серйозні проблеми зі здоров’ям. Деякі вчені вважають, що причиною були серйозні інфекційні захворювання, які вразили кістки ніг. Однак за допомогою генетичної експертизи вдалося встановити, що Тутанхамон був сином Ехнатона фараона та його сестри. Саме тому у Тутанхамона було виявлено низку генетичних захворювань, внаслідок чого у нього з’явилися відхилення в будові опорно-рухового апарату. Прожив фараон лише 19 років.
від порушення рівноваги…»
Подагра — хвороба королів чи королева хвороб?

«Подагра» в перекладі з грецької означає «капкан на стопі». Згадки про подагру зустрічаються з часів Гіппократа, коли він вперше описав синдром гострого болю в області великого пальця на стопі, який власне й назвав «подагра». До кінця XX століття подагру стали розглядати як хворобу накопичення солей сечової кислоти у структурі суглобів, підшкірній клітковині, кістках та нирках.
Здавна подагру називали «хворобою королів чи королевою хвороб», «хворобою панів» і навіть вважали ознакою геніальності. Подагрою хворіли дуже багато відомих людей, які залишили слід у світовій історії. Це були геніальні
люди: Ісаак Ньютон, Альберт Ейнштейн, Чарльз Дарвін, Петро I, Мікеланджело, Леонардо да Вінчі, Олександр Македонський.


В даний час подагра — це одне з найпоширеніших захворювань суглобів у осіб старше 40 років, частіше у чоловіків. Чоловіки хворіють на подагру в 9–10 разів частіше за жінок. Пік захворюваності спостерігають у чоловіків віком 40-50 років, а у жінок старше 60 років.

«…Хвороба завжди походить або від надлишку, або від нестатку, тобто
ГІППОКРА�Т (близько 460 до н. е. — бл. 370 до н. е.)
60 Журнал «Сучасна фармація» • modern-pharmacy.com.ua • 2023 / березень • Арсенал знань • Хронограф
Аномалія, що отримала неофіційну назву «габсбурзьке підборіддя», добре помітна на портретах представників монаршої династії — як жінок, так і чоловіків: нижня щелепа сильно видається вперед, а верхня виглядає недорозвиненою.
Представники цієї сім’ї об’єднали під своєю владою величезні території в Західній, Південній та Центральній Європі — землі, якими вони в різний час правили, сьогодні входять до Іспанії, Нідерландів, Німеччини, Італії, Чехії, Австрії, Угорщини, Румунії та багатьох інших країн. Такої могутності Габсбургам вдалося досягти не в останню чергу завдяки численним шлюбам між представниками правлячої династії, що дозволяло уникнути подрібнення територій під час поділу між спадкоємцями. Однак, вчені вважають, що поступове збільшення близьких родинних шлюбів у цій династії призвело до більшої виразності нижньої щелепи та
появи генетичних захворювань. Так, останній представник династії Габсбургів (Карл II) в Іспанії страждав від цілого ряду хвороб, включаю-
чи епілепсію та розумову відсталість, а його сильно витягнута нижня щелепа заважала йому пережовувати їжу та розмовляти.
Іспанські вчені зібрали портрети 15 представників габсбурзької династії (загалом 66 зображень) і показали їх 10 практикуючим щелепно-лицьовим хірургам, попросивши тих оцінити ступінь деформації обличчя зображених людей.
Паралельно з цим історики склали докладне генеалогічне дерево Габсбургів, що включає понад 6000 чоловік, щоб найбільш точно оцінити ступінь спорідненості між ними і рівень інбридингу (близькоспоріднених шлюбів) того чи іншого правителя. Результат оцінки хірургів виявився передбачуваним: що більше родичів було серед предків монарха, то більш вираженими були аномальні риси обличчя — особливо випнута нижня щелепа. Аномалія нижньої щелепи була найбільш виражена у Філіпа IV (короля Іспанії та Португалії з 1621 по 1640). Верхня — у імператора Максиміліана I Габсбурга і відразу кількох його нащадків.
Хронограф
Арсенал знань
•
березень
2023
•
modern-pharmacy.com.ua
•
Вперше герпес було зафіксовано у літературі лікарями Стародавнього Риму задовго до нашої ери. Римський імператор Тіберій видав указ про заборону публічних поцілунків у Сенаті, щоб уникнути поширення незрозумілої хвороби.
Докладніше це захворювання описав Гіппократ. Знаменитий цілитель організовував перші спроби боротьби з епідемією цієї недуги. Він же вигадав йому назву: від давньогрецького слова «герпейн» або повзучий. Мабуть, маючи на увазі здатність герпесу швидко «розповзатися» серед населення.
Однак з легкої руки французьких медиків, які безуспішно намагалися лікувати дрібнопухирчасті висипи на губах та інших слизових оболонках, а іноді і в найінтимніших місцях Людовіків XIV і XV, герпес назвали «недугою французьких королів». У 1736 році опис генітального герпесу дав медик короля Людовіка XV, лікар-філософ Жан Астрюк у своїй книзі «De morbis venereis».
І лише в 1912 році А. Левенштейн і В. Грютер, ґрунтуючись на відкритті вірусів, довели вірусне походження герпесу. Таким чином розпочався новий етап розвитку медицини.

ЛЮДОВИ�К XV УЛЮ�БЛЕНИЙ

15 лютого 1710 — 10 травня 1774) — король Франції (1715-1774)





Журнал «Сучасна фармація»

Герпес — недуга французьких королів
«Габсбурзьке підборіддя»
/
• 61
Прокляття Вікторіанської доби
Найвідомішим носієм гемофілії в історії стала англійська королева Вікторія. Панує версія, що зміни відбулися саме в її генотипі, бо в сім’ї ніхто не мав раніше такого діагнозу. За іншою версією, наявність
гена гемофілії у королеви Вікторії можна пояснити
тим, що її батьком був не Едвард Август, герцог Кентський, а зовсім інший чоловік з гемофілією. Але історичних доказів на користь цієї версії немає. Англійська королева передала хворобу в «спадок» пануючим сім’ям різних
династій, адже Вікторія мала 9 дітей: 5

дочок і 4 синів. Таким чином, гемофілія наздогнала багато королівських
родин.
Гемофілія є рідкісним, але серйозним спадковим захворюванням, пов’язаним з порушенням
функції зсідання крові, що призводить до неконтрольованих і спонтанних кровотеч та крововиливів у різні органи та тканини. При гемофілії
організм людини не може природним способом зупинити кровотечу, яка виникла через ушкодження
кровоносної судини внаслідок травми, хірургічного втручання чи стресу. У системі зсідання крові розрізняють кілька типів білків, за якими розрізняють тип хвороби. Гемофілія типу А залежить від фактора зсідання крові VII, типу B — фактора IX, типу С — фактора XI. Перший тип зустрічається набагато частіше, приблизно в 85 %, тип В — в 13 % випадків, тип С — в 1-2 %. Найчастіше гемофілія типу А та В спостерігається у чоловіків. Жінки зазвичай є носіями гена гемофілії, а якщо хворіють, то частіше у жінок констатують гемофілію типу А. До того ж є кілька хвороб зсідання крові — хвороба Віллебранда та різні синдроми дефіциту факторів коагуляції, які можливі і у жінок, та їх прояви схожі на гемофілію.
«Пурпурна таємниця»


ГЕОРГ III

(4 червня 1738 — 29 січня 1820) —




король Великої Британії та Ірландії з 25 жовтня 1760 до смерті в 1820 році.
Діагноз британського короля Георга ІІІ (1738–1820), який у другій половині життя страждав на напади загадкового захворювання, довгі роки не давав спокою історикам та медикам. Психопатологічна симптоматика, що супроводжувала напади, дозволила його сучасникам записати монарха до лав божевільних і була настільки вираженою, що призвела спочатку до часткової, а потім і повної втрати Георгом здатності керувати державними справами. Довгі роки після смерті Георга ІІІ було прийнято вважати, що король страждав на маніакально-депресивний психоз, адже під час ремісій він здавався абсолютно здоровою людиною. Однак у 1966 р. британські психіатри Іда Макальпін та її син Річард Хантер звернули увагу на велику кількість соматичних симптомів, що супроводжували напади хвороби Георга: кульгавість, біль у черевній порожнині та коліки, нудоту, запори, труднощі при засинанні, гіперчутливість до світла, звуків і дотиків, висипання на шкірі і, найголовніше, нетиповий колір сечі — червоний, помаранчевий, коричневий або пурпурний. Всі ці симптоми характерні для рідкісної спадкової хвороби — порфірії, в основі якої лежить порушення порфіринового обміну, що призводить до підвищення вмісту в організмі пігментів порфіринів або їх попередників.

Захворювання носить нападоподібний характер і провокується одним або декількома порфіриногенними факторами екзогенної або ендогенної природи: алкоголем, деякими лікарськими засобами (нестероїдні протизапальні препарати, барбітурати, сульфаніламі-

62 Журнал «Сучасна фармація» • modern-pharmacy.com.ua • 2023 / березень • Арсенал знань • Хронограф
ди та ін), інсоляцією, гіпоглікемією, бактеріальними.
Приступи можуть бути спровоковані і миш’яком. Група дослідників під керівництвом професора Уоррена виявила підвищений вміст миш’яку у волоссі Георга III, що зберігається в Науковому музеї Лондона (середня концентрація була перевищена у 17 разів).
Відомо, що ще під час першого епізоду хвороби короля почали лікувати сурмою у високих дозах, яку застосовували від болю у животі. Цілком імовірно, що таке
лікування не тільки не допомогло, а й посилило його стан.
Наприкінці 90-х років ХХ ст. авторський колектив, що складається з генетиків та істориків, опублікував «медичний детектив» під назвою «Пурпурна таємниця: гени, божевілля та королівські будинки Європи», який справив сенсацію в Англії, надавши низку фактів, що підтверджують наявність гена порфірії в королівській родині.

«Королівська» операція Людовіка XIV
Лікарі були частково винні у виникненні королівського свища. Вже кілька років Людовік страждав на парапроктит. Військову кампанію 1685 року він провів у сідлі, що лише посилило перебіг хвороби.
Король Франції Людовік XIV, на той час найвпливовіший монарх у світі, приймає посольство Сіаму (нині Таїланд). Сидіти на троні, та й взагалі сидіти з таким свищем — справжнє катування. Тому вираз обличчя короля був невеселий, що помітно навіть на офіційній гравюрі. Влітку Людовік не покидав своєї кімнати, соромлячись огидного запаху, який він поширював навколо себе (посол потім сказав, що «король пахне як дикий звір»). Ходити міг з великими труднощами. Прийом не скасували тільки тому, що сіамці їхали з іншого кінця Землі, і не повертатися їм назад зовсім без результату.
Тепер Людовік не міг ні сидіти, ні ходити. З кожним днем він робився все сумнішим. Хоча його стан тримали в таємниці, похмурий вигляд короля та його рідкісна поява на публіці породжували погані чутки. Тоді перший при-
дворний медик запропонував віддатися до рук цирульника-хірурга (так називалася ця професія — на той час операції виконували перукарі). Викликаний цирульник-хірург Шарль-Франсуа Фелікс не наважився відмовити королю, але заявив, що таких операцій ще не робили і потрібно півроку на відпрацювання методики.

З усієї Франції повезли до Фелікса страждальців зі свищем. Почали із ув’язнених.
Пробні операції часто закінчувалися
летальним результатом. Щоразу операції проходили все краще. Після 75-ї за рахунком Фелікс відчув себе впевнено.
Зранку 18 листопада у Версальській королівській опочивальні
в обстановці повної секретності проводиться
операція. Фелікс створив для цієї операції спеціальний інструмент — вигнутий «по-королівськи» ніж, до якого прикріплюється щось на зразок зонда для його подальшого введення в анальний свищ (патологічний канал прямої кишки, що виник у результаті інфекції). Відтоді ця операція відома як «королівська».
Смертельні методи лікування Бувара
Хронограф

Арсенал знань •
•
ЛЮДОВИК
XIII СПРАВЕДЛИВИЙ
(27 вересня 1601 — 14 травня 1643)




Любителі історичних романів, зрозуміло, пам’ятають про протистояння мушкетерів Людовіка XIII та гвардійців кардинала Рішельє. Пам’ятають також про те, що король і кардинал часто бували роздратованими. Причина проста. І того, й іншого лікував придворний медик Бувар. Те, що він захоплювався кровопусканням — ще квіточки. Бувар був новатором. Тому, вірно визначивши хворобу короля та кардинала (катар шлунка), раптово вирішив, що причиною є глисти. Виганяв він їх оригінально — блювотними та об’ємними клізмами. У середньому королю прописувалося 215 прийомів блювотного засобу та 312 клізм на рік. Майже кожен день. Причому медик накачував своїх підопічних нікотиновим настоєм і навіть тютюновим димом, вважаючи, що новий продукт з Америки остаточно позбавить
їх від паразитів. В результаті катар, концентрований нікотин
через задній прохід призвели до смерті і кардинала, і короля.
•
modern-pharmacy.com.ua
•
Журнал «Сучасна фармація»
король Франції в 1610–1643 роках
2023 / березень 63
РОЗЛАД?
Нове дослідження в Biological Psychiatry, опубліковане




Elsevier, досліджує взаємодію між серотоніновою
системою та естрадіолом у мозку, показуючи, що ЦНС у пацієнтів із передменструальним дисфоричним розладом (ПМДР), збільшує щільність транспортера серотоніну з періовуляторної фази (коли рівень естрадіолу високий)
до фази передменструального циклу (коли і естрадіол, і прогестерон знижуються). Отримані результати можуть сприяти клінічному лікуванню ПМДР.
Передменструальний синдром (ПМС) охоплює
клінічно значущі соматичні та психологічні прояви
під час лютеїнової фази менструального циклу, що призводять до значного розладу та порушення функціональних можливостей. Ці симптоми зникають протягом декількох днів після початку менструації.
Поширеність його серед жінок репродуктивного віку у всьому світі становить 47,8%. Передменструальний
дисфоричний розлад (ПМДР) пов’язаний зі змінами настрою, депресією та тривогою. Його симптоми є більш серйозними та можуть тривати до двох тижнів.
ЦІКАВО , що попередні
дослідження, які порівнювали
коливання гормонів яєчників між
жінками з ПМДР і здоровими
жінками, не виявили суттєвих
відмінностей, що свідчить про те, що
дисрегуляція гормонів на периферії
не є основною причиною розладу. Альтернативна
ідея полягає в тому, що реакція мозку на нормальні
ендогенні гормональні зміни відрізняється
у пацієнтів з ПМДР, хоча як це відбувається, залишається незрозумілим. Лікування ПМДР
селективними інгібіторами зворотного захоплення
серотоніну (СІЗЗС) призводить до надзвичайно
швидкого полегшення симптомів.
У поточному дослідженні під керівництвом Джулії Захер, доктора медичних наук, доктора філософії з Інституту когнітивних функцій людини та мозку Макса Планка, Лейпциг, Німеччина, було обстежено 30 пацієнтів із ПМДР і 29 здорових жінок контрольної групи протягом двох менструальних циклів. Дослідники використовували позитронно-емісійну томографію (ПЕТ), щоб візуалізувати наявність білка-транспортера серотоніну в мозку протягом усього циклу, відображаючи короткочасні зміни в його експресії. Вчені виявили значне збільшення транспортера серотоніну від периовуляторної до передменструальної фази у пацієнток із ПМДР — зміни на 18% у середньому мозку, регіоні мозку з найбагатшою експресією транспортера серотоніну. Це збільшення було пов’язане з тяжкістю депресивного настрою перед менструацією. Несподівано доктор Захер і її колеги також виявили зниження щільності транспортера серотоніну в середньому мозку у здорових жінок, що могло вказувати на захисний механізм здорового жіночого мозку в умовах зміни гормонального середовища.
Отримані дані свідчать про те, що люди з ПМДР мають короткочасні зміни щільності транспортера серотоніну протягом менструального циклу, що свідчить про те, що пацієнтам може бути корисним прийом СІЗЗС у певний час протягом циклу, щоб найкраще вплинути на ці зміни.
Джерело: https://www.sciencedaily.com

ЯК ПЕРЕЖИТИ
ПЕРЕДМЕНСТРУАЛЬНИЙ ДИСФОРИЧНИЙ
64 Журнал «Сучасна фармація» • modern-pharmacy.com.ua • 2023 / березень • Арсенал знань • У світі медицини


ОЧНІ КРАПЛІ
«ХІЛО-КОМОД»
незамінний помічник
в лікуванні синдрому сухого ока
Ілля Гарбук, лікар-офтальмолог Остапець Марина, кандидат медичних наук, доцент кафедри нормальної та патологічної фізіології НФаУ

У сучасному світі робота, навчання, спілкування і розваги тісно пов’язані з гаджетами і цифровими технологіями, при цьому часто страждає зір. Синдром сухого ока можна віднести до «хвороб цивілізації», що пов’язані з науковотехнічним прогресом. За даними ВООЗ, кожного року близько 300 мільйонів людей скаржаться на погіршення зору, з них майже 30 % дорослого населення страждають саме на синдром сухого ока. Ця патологія знижує зорову працездатність людини, викликає дискомфорт, погіршує якість життя, і в разі тривалого ігнорування її проявів може призвести до тяжких захворювань ока, які спричиняють стійке зниження і навіть втрату зору.
Комп’ютерний зоровий синдром — це стан, який виникає у людей при тривалій роботі за комп’ютером на близькій відстані. Ця патологія призводить до зорової втоми, тривалого головного болю і навіть втрати зору. Почервоніння очей, відчуття сухості та чужорідного тіла після тривалої роботи на близькій відстані перед монітором — це перші прояви комп’ютерного синдрому. Однак багато людей, які довго страждають від цього синдрому, не звертаються за медичною допомогою. Тільки тоді, коли ситуація сильно погіршується, пацієнти звертаються до лікаря [1].
ЦЕ ЦІКАВО!!!
Людське око здатне розрізняти 30–250 тонів кольору
і близько 10 мільйонів змішаних відтінків;
жінки моргають у 2 рази частіше за чоловіків;
у людини, яка працює за комп’ютером, очі 20 тисяч раз перефокусовуються з комп’ютера на папір або клавіатуру;
повна адаптація ока до темряви займає 30–50 хвилин;
при швидкому читанні очі втомлюються менше, ніж при повільному;
протягом 12 годин людина у середньому моргає 25 хвилин;
чоловіки в середньому плачуть 7 разів на рік, жінки — 47 разів.
Згідно з дослідженнями, близько 70 % людей, робота яких пов’язана з комп’ютером, страждають на комп’ютерний зоровий синдром [1]. Світова статистика свідчить, що тривала щоденна робота за комп’ютером призводить до розвитку цього синдрому у 64–90 % людей. Спочатку симптоми порушення зору мають тимчасовий характер, але згодом синдром прогресує. Тривала робота за комп’ютером потребує високої зосередженості на інформації, що з’являється на моніторі. При цьому очі перенапружуються,



66 Журнал «Сучасна фармація» • modern-pharmacy.com.ua • 2023 / березень • Арсенал знань • Професійний конкурс
A
внаслідок чого зір може погіршитися. Симптоми ураження очей можуть не регресувати навіть після тривалого відпочинку від впливу комп’ютера [2].
ЦЕ ЦІКАВО!
Термін «комп’ютерний зоровий синдром» (Computer Vision Syndrome)



був вперше впроваджений у медичну
практику в 1998 р. Американською асоціацією
оптометристів і вважається професійним захворюванням.
Головною причиною виникнення комп’ютерного синдрому є тривала фіксація погляду на монітор пристрою (телефона, ноутбука, комп’ютера), внаслідок чого різко зменшується кількість моргальних рухів повік (за оцінками дослідників, моргання зменшується в 10–15 разів). Людина настільки сконцентрована на своїй роботі, що не може контролювати частоту моргання. Як результат, очна щілина довго залишається відкритою, що веде до швидкого пересихання очної поверхні внаслідок порушення слізної плівки. Через відсутність слізної рідини у першу чергу страждає рогівка, що викликає неприємні відчуття в оці і нечіткість зору. Згодом виникає почервоніння очей внаслідок розширення кон’юнктивальних судин. Отже, головною небезпекою для зору є не випромінювання від монітора комп’ютерна, а зниження необхідного зволоження ока через інтенсивну зорову роботу [1, 2].
Синдром сухого ока — це комплекс симптомів, які виникають у результаті зниження вироблення слізної рідини або занадто швидкого її випаровування з поверхні ока. Причини розвитку синдрому сухого ока можна розділити на дві групи. По-перше, це недостатнє утворення сльозової рідини, яке відбувається часто внаслідок різних захворювань, наприклад, аутоімунних. Крім того, виділення сльози може тимчасово порушуватися після офтальмологічних операцій [2].
По-друге, є чинники способу життя й навколишнього середовища, котрі впливають на те, наскільки інтенсивно випаровується сльозова плівка:
постійна робота перед комп’ютерним або іншими моніторами;
багатогодинне керування автомобілем;
перебування в приміщенні з сухим повітрям (через кондиціонування або опалення);
перебування на відкритому повітрі під впливом ультрафіолету і/або сильного вітру;
носіння контактних лінз;
використання антибактеріальних офтальмологічних препаратів [2].
Синдром сухого ока проявляється різними скаргами:
біль в очах;
відчуття піску в очах;
різь в очах;
свербіж та почервоніння очей;
погіршення зору;
відчуття постійного подразнення очей;
відчуття сухості очей при блиманні [2].
НА ЗАМІТКУ!!!
Пересихання поверхні очей при тривалій роботі за комп’ютером виникає внаслідок:
зменшення кількості моргальних рухів очей;
низької вологості приміщення;
ширшої очної щілини при погляді на монітор, який знаходиться вище за рівень голови;
надмірного освітлення монітора;
супутньої патології очей (дисфункція мейбомієвих залоз).
Лікування синдрому сухого ока на сьогодні є дуже актуальним питанням. На фармацевтичному ринку існує низка лікарських засобів, які здатні замінювати природну сльозу людини, але не всі вони показані для тривалого застосування. Приблизно 65–70 % від усіх препаратів штучних замінників слізної рідини містять у своєму складі консерванти, які допомагають збільшити строк зберігання крапель. Однак при тривалому застосуванні цих препаратів консервант відкладається на поверхні ока, індукуючи загибель бокалоподібних клітин, які виробляють муцин (внутрішній шар слізної плівки). Все це, у свою чергу, лише посилює симптоми сухості очей [3].
Професійний конкурс
Арсенал знань
•
2023 / березень
•
modern-pharmacy.com.ua


•
Журнал «Сучасна фармація»
• 67
Аби уберегти очі від хронічної сухості, штучний
замінник слізної рідини повинен відповідати наступним вимогам:
відсутність будь-яких консервантів у складі;
наявність у складі лише натуральних речовин (зокрема, гіалуроновоа кислоти);
мінімальна кількість або відсутність побічних ефектів, гіпоалергенність;
відповідна осмолярність розчину (275–316 мОсм/л);
можливе поєднання з постійним використанням контактних лінз;
наявність безпечного цитратного буфера;

зручний флакон для застосування.

Очні краплі «ХІЛО-КОМОД» виробництва фармацевтичної компанії «UPSAPHARM» (Німеччина) відповідаюсь усім зазначеним вимогам [4].



Найважливішою складовою очних крапель
«ХІЛО-КОМОД» є гіалуронова кислота (ГК) —
природний полімер, який міститься в клітинному
просторі багатьох біологічних рідин організму людини (зокрема, і в слізній рідині). ГК допомагає утримувати вологу у різних типах тканин людського організму, і навіть на поверхні очей. До того ж, натрію гіалуронат бере участь у регенерації різних тканин організму. Завдяки вираженим гідрофільними властивостями, ГК з легкістю з’єднує та утримує велику кількість води, у зв’язку з чим вона є ідеальним фізіологічним замінником слізної плівки. Ці власти-
вості ГК зумовлюють її використання в офтальмології [5].
Очні краплі «ХІЛО-КОМОД»
0,1% розчин гіалуронової кислоти Показання до застосування:
симптоматичне лікування сухості рогівки та конʼюктиви (синдром сухих очей) [9]
На відміну від інших речовин, ГК не змінює нормальну поверхню ока. Вона відтворює здорову слізну плівку з більш тривалим часом утримання на рогівці порівняно із замінниками сліз на основі целюлози. Крім цього, ГК виконує функції транспортного середовища для нутрієнтів та фільтра для запальних молекул [6]. 0,1 % розчин ГК є ідеальним рішенням для очних крапель. Саме ця концентрація ГК створює необхідну в’язкість розчину, що допомагає штучній сльозі довше залишатися на очній поверхні, не випаровуватися, покращувати стабільність слізної плівки [5, 6].
Проведені дослідження щодо застосування препарату на основі 0,1 % розчину ГК («ХІЛО-КОМОД») у пацієнтів із синдромом сухого ока після ексимер-лазерної хірургії (LASIK, LASEK) різних порушень рефракції. Було доведено, що використання 0,1 % розчину ГК після LASIK покращує якість слізної плівки, підвищує її стабільність і зменшує вираженість симптомів, що характеризують синдром сухого ока, прискорюючи цим реабілітацію пацієнтів [6, 7].
В іншому дослідженні було доведено, що використання очних крапель «ХІЛО-КОМОД» у пацієнтів із порушеннями цілісності слізної плівки є ефективним для профілактики і лікування вторинного синдрому сухого ока у пацієнтів після офтальмохірургічного втручання [7, 8].
Крім наявності у складі виключно натуральних молекул, препарати-сльозамінники повинні містити цитратний буфер. Слід зазначити, що при виробництві
«ХІЛО-КОМОД» — ДБАЙЛИВИЙ ДОГЛЯД ТА ВІДНОВЛЕННЯ
68 Журнал «Сучасна фармація» • modern-pharmacy.com.ua • 2023 / березень • Арсенал знань • Професійний конкурс
більшості очних крапель використовують фосфатний буфер. Суттєвим недоліком цього буфера є його взаємодія з кальцієм, який виділяється із пошкоджених епітеліальних клітин рогівки. Це призводить до утворення нерозчинних сполук — кальцифікатів [3].

Сучасною альтернативою фосфатним буферним системам є застосування цитратного буфера у розчинах ГК. Цитрат, на відміну від фосфату, не утворює важкорозчинних сполук (кальцію фосфат). Буферна система, що містить іони цитрату, діє як хелатний агент, здатний зберегти кальцій у розчиненому вигляді. Доведено, що очні краплі, які містять цитрат, володіють репаративними властивостями, які ґрунтуються на придушенні інфільтрації запаленої тканини рогівки поліморфноядерними лейкоцитами [4].
Отже, для кращої безпеки й переносимості сльозозамінної терапії сухості очей слід віддавати перевагу засобам із цитратним буфером без консервантів. Саме «ХІЛО-КОМОД»
не містить фосфатів та консервантів [4].
ЦЕ ВАЖЛИВО!!!
«ХІЛО-КОМОД ФОРТЕ»
рекомендується застосовувати як супутню терапію при різних травмах й опіках рогівки і кон’юнктиви, оскільки ГК, що входить до складу крапель, стимулює процеси регенерації тканин.
Суттєвою перевагою очних крапель «ХІЛОКОМОД» є покращена сучасна аплікаційна система, що забезпечує стерильність розчину без необхідності включення до складу консервантів, — система COntinuous MOno Dose — COMOD. Ця технологія дозволяє точно дозувати розчин, що суттєво знижує зайву витрату крапель. При натисканні на помпу з’являється тільки одна крапля, що забезпечує економне використання, а також запобігає контакту розчину,
що знаходиться у флаконі, з навколишнім повітрям. Це дозволяє застосовувати очні краплі з одного флакона протягом тривалого часу (до 6 місяців).
Фармацевтична опіка в аптеці передбачає консультування відвідувачів щодо способу застосування ліків. За необхідності такої консультації фармацевт повинен звернути увагу клієнта на особливості застосування очних крапель «ХІЛО-КОМОД».
1. Зніміть ковпачок з контейнера.
2. Перед першим застосуванням препарату поверніть контейнер наконечником донизу та натискайте на дно контейнера до появи перших крапель на отворі наконечника. Зараз контейнер готовий для подальшого використання.
2023 / березень • Арсенал знань • Професійний
Журнал «Сучасна фармація» •
• конкурс 69
modern-pharmacy.com.ua



Спосіб застосування очних крапель «ХІЛО-КОМОД» [9]
3. Злегка нахиліть голову назад, відтягніть нижню повіку і сильно та швидко натисніть на дно контейнера: це активує механізм для вивільнення однієї краплі. Завдяки спеціальній системі розмір кожної кра-
плі та швидкість вивільнення залишатимуться однаковими, однак це потребує більшої сили натискання, ніж для звичайних флаконів з краплями. Повільно закрийте око для того, щоб рідина рівномірно розподілилася по його поверхні. 4. Одразу ж після використання закрийте контейнер ковпачком. Після закапування очних крапель слід упевнитися, що наконечник контейнера сухий. У разі появи на ньому рідини слід уникати будь-якого контакту з оком або шкірою.
«ХІЛО-КОМОД»
рекомендовано
застосовувати по 1 краплі
тричі на добу в кожне
око. За необхідності
кількість застосувань
можна збільшити до 10
разів на добу. Важливою
особливістю препарату
є те, що він повністю
сумісний із носінням
контактних лінз.
ПЕРЕВАГИ «ХІЛО-КОМОД»:
Флакон-крапельниця запатентованої конструкції. Унікальний антисептичний флакон. Система COMOD1 — запатентована система дозаторного пристрою, яка гарантує стерильність розчину, що дозволяє використовувати вміст флакона протягом 6 місяців після відкриття. Гарантує однакову дозу ліків при кожному натисканні.
Гіалуронова кислота високої молекулярної маси. Як і в будь-якому лікарському засобі, для штучних сліз важлива якість діючої речовини. Гіалуронова кислота у складі «ХІЛО-КОМОД» — єдиний еталон якості згідно Європейської фармакопеї 2 . Високомолекулярна, в’язка гіалуронова кислота забезпечує тривалість зволоження поверхні ока понад 4 години.
Одразу після закапування не погіршується зір. ГК високого ступеня очистки не затуманює зір. Тобто краплями можна користуватися в будьякий час і в будь-якій ситуації, що вимагає зорової концентрації.
Тривалий термін зберігання у відкритому флаконі. Спеціальна герметична упаковка зі срібним покриттям усередині дозволяє зберігати препарат у відкритому вигляді до 6 місяців.
Сумісність з будь-якими контактними лінзами. ГК утворює навколо рогівки слізну плівку, яка дозволяє оку нормально взаємодіяти з лінзою. Можна закапувати, навіть не знімаючи лінзу — це дуже зручно!
1. https://www.ursapharm.de/en/systems-and-production/comod-system/
2. https://www.edqm.eu. Certi cate of suitability No. R1-CEP 2001-385-Rev 07
Список літератури:
1. John R. Hayes., James E. Sheedy, Joan A. Stelmack, Catherine A. Heaney «Computer use, symptoms, and quality of life». Optom Vis Sci. 2007; 84(8): 738–44.

2. Zemanová M. Dry eye disease. A review. Cesk Slov O almol. 2021;77(3):107–119.


3. Bernauer W, iel MA, Kurrer M, Heiligenhaus A, Rentsch KM, Schmitt A, Heinz C, Yanar A. Corneal calci cation following intensi ed treatment with sodium hyaluronate arti cial tears. Br J Ophthalmol. 2006;90(3):285-8.
4. Косуба С.І., Тутченко Л.П., Туманова О.В., Сковрон М.В. Вплив буферних систем і консервантів у складі очних крапель на безпечне й тривале лікування пацієнтів із хворобою сухого ока. Архів офтальмології України. 2019;3(7).
5. Pinheiro R, Pan l C, Schrage N, Dutescu RM. e Impact of Glaucoma Medications on Corneal Wound Healing. J Glaucoma. 2016;25(1):122-7.
6. Labiris G. Impact of 0.1 % sodium hyaluronate and 0.2 % sodium hyaluronate arti cial tears on postoperative discomfort following cataract extraction surgery: a comparative study. Eye Vis (Lond). 2019;6:6.
7. Wu Y, Xu L, Song Y, Zhang Q, Qin G, Yang L, Ma J, Palme C, Moore JE, Pazo EE, He W. Management of Post-LASIK Dry Eye with Intense Pulsed Light in Combination with 0.1 % Sodium Hyaluronate and Heated Eye Mask. Ophthalmol er. 2022 Feb;11(1):161-176.
8. Ntonti P, Panagiotopoulou EK, Karastatiras G, Breyannis N, Tsironi S, Labiris G. Impact of 0.1% sodium hyaluronate and 0.2% sodium hyaluronate arti cial tears on postoperative discomfort following cataract extraction surgery: a comparative study. Eye Vis (Lond). 2019 Feb 11;6:6.
9. Інструкція до медичного застосування лікарського засобу Хіло-Комод

Бережіть свої очі разом із
«ХІЛО-КОМОД»!
70 Журнал «Сучасна фармація» • modern-pharmacy.com.ua • 2023 / березень • Арсенал знань • Професійний конкурс
УВАГА!
Оголошується професійний конкурс на знання
важливих аспектів використання лікарського
засобу ХІЛО-КОМОД.
За результатами конкурсу буде визначено
5 переможців
1. Який фактор при тривалій роботі за телефоном, ноутбуком, комп’ютером є більш загрозливим для здоров’я очей?
A. Випромінювання від монітора
B. Погіршення зволоження очей через напружену зорову роботу (зменшення моргальних рухів повік)
2. Які чинники способу життя впливають на інтенсивність

випаровування слізної плівки та можуть викликати синдром сухого ока? (декілька відповідей)
A. Багатогодинне керування автомобілем
B. Носіння контактних лінз
C. Постійна робота перед комп’ютерним або іншими моніторами
D. Он-лайн навчання
E. Перебування у приміщенні з сухим повітрям
F. Вплив ультрафіолету або сильного вітру
3. Якими проявами може супроводжуватися синдром сухого
ока? (декілька відповідей)
А. Біль в очах
B. Відчуття піску в очах
C. Різь в очах
D. Свербіж і почервоніння очей
E. Погіршення зору
F. Відчуття постійного подразнення очей
G. Відчуття сухості очей при блиманні
4. Які показання до застосування має ХІЛО-КОМОД?
A. Симптоматичне лікування сухості рогівки та кон’юнктиви (синдром «сухих очей»
B. Після проведення оперативних втручань
C. Травми, поверхневі пошкодження рогівки
5. Відвідувач аптеки звернувся до фармацевта зі скаргами на свербіж і почервоніння очей, відчуття піску в очах, різь та сухість очей при блиманні, що виникли після багатогодинної роботи за комп’ютером. Який лікарський засіб доцільно порекомендувати?
A. Очні краплі з антибіотиком
B. ХІЛО-КОМОД
C. Очні краплі протимікробної дії
ЯК ВЗЯТИ УЧАСТЬ?
Спосiб 1. Переходьте за QR-кодом

та вiдповiдайте на запитання.
Спосiб 2. Шукайте посилання
на конкурс на сторінці «Сучасна
фармація» у Facebook
Спосiб 2. Вiдповiдi iз заповненою анкетою
учасника надсилайте на електронну адресу редакцiї publicpharmacy@gmail.com
6. До складу очних крапель «ХІЛО-КОМОД» входить 0,1% розчин гіалуронової кислоти, якій властиві такі ефекти: (декілька відповідей)
A. Сприяє відновленню різних тканин організму (поверхні очей)
B. Утримує вологу на поверхні очей
C. Є транспортним середовищем для нутрієнтів
D. Є фільтром для запальних молекул
E. Покращує стабільність слізної плівки

D. Створює необхідну в’язкість розчину
7. Які переваги очних крапель ХІЛО-КОМОД забезпечує сучасна система дозування «COMOD»? (декілька відповідей)
A. Стерильність розчину без додавання консервантів
B. Точне дозування розчину С. Економне використання розчину
D. Тривалий час придатності крапель після відкривання флакона
8. Який фактор забезпечує кращу безпеку й переносимість лікування сухості очей краплями ХІЛО-КОМОД? (дві відповіді)
A. Наявність у складі цитратного буфера
B. Наявність у складі фосфатного буфера
C. Відсутність консервантів
D. Знижений вміст консервантів
9. Яка рекомендована доза очних крапель ХІЛО-КОМОД?
A. По 1 краплі тричі на добу, у разі необхідності частоту закапувань можна збільшити
B. По 2 краплі один раз на добу
C. По 3 краплі двічі на добу
10. Чи можна використовувати очні краплі ХІЛО-КОМОД
при носінні контактних лінз?
A.Так
B. Ні
Анкета учасника
ПIБ ____________________________________________________
Населений пункт, область __________________________________
Мiсце роботи, посада ______________________________________
Телефон ________________________________________________

Чекаємо на Вашi вiдповiдi та бажаємо успiхiв!

ВДОМА КРАЩЕ:
Як впоратися
з непростими
почуттями
AЛюбов ПЛЯКА, кандидат психологічних
наук, практичний психолог
вищої категорії, Національний фармацевтичний університет




ВІЙНА ТРИВАЄ, АЛЕ МИ СПОСТЕРІГАЄМО ПОВЕРНЕННЯ УКРАЇНЦІВ ДОДОМУ. КОМУСЬ ЦЕ РІШЕННЯ ДАЄТЬСЯ ЛЕГКО, А КОМУСЬ НАВПАКИ — ВИНИКАЄ СТРАХ, ТРИВОЖНІСТЬ, СУМНІВИ, НЕРОЗУМІННЯ — ЯК ЖИТИ ДАЛІ.
З початком широкомасштабного вторгнення РФ на
територію України багато українців були вимушені
покинути рідні домівки. Хтось їхав до знайомих або
рідних, хтось подалі від загрози життю, гуманітарної
катастрофи. За даними ООН, до сусідніх країн виїхало

понад 17 млн осіб, багато хто залишився на території
України і став внутрішньо переміщеною особою, змінивши місце проживання на більш безпечне і затишне.
Люди, які покинули свої домівки, постійно вагаються, чи варто повертатися, чи достатньо безпечно буде вдома? У вашому досвіді була пряма загроза жит-
тю або ви були свідком цього. Перспектива повернення може відтворювати у вашій свідомості минулий досвід.
Дім — це відчуття безпеки та комфорту. У мирні часи повертатися додому після подорожі або відрядження означає знову опинитися серед улюблених речей, упізнати власне місто, дім, квартиру, відчути себе у звичайному просторі. Приємному та безпечному. Війна докорінно змінила це.
Важливо собі нагадувати: все змінилось, ми змінились, так, як було, вже не буде.
Чому повернення додому може бути таким хвилюючим?
ЯКІ КРОКИ МОЖУТЬ ДОПОМОГТИ В ТАКІЙ СИТУАЦІЇ?
Щоб рішення про повернення було не імпульсивним, а зваженим, запитайте себе: «Заради чого я повертаюсь?». Дайте собі час, не поспішайте. Пам‘ятайте: війна триває, а це означає, що її наслідки ви обов’язково відчуєте. Кожне місто України досі перебуває у відносній безпеці.
Краще буде, якщо ви зустрінете змінений світ із мінімальною кількістю очікувань. Протестуйте реальність: перегляньте актуальні фотографії вашого міста, поговоріть із друзями, колегами, сусідами. І прийміть виважене, обґрунтоване для себе, рішення.
72 Журнал «Сучасна фармація» • modern-pharmacy.com.ua • 2023 / березень • Арсенал знань • Поради психолога
Чи потрібно боротися зі страхом?
Страх — це наша звичайна емоція. Вона належить до негативних емоцій і її переживають всі люди. По суті, страх має лише одну мету — захистити та вберегти вас. Немає такої людини, яка колись не відчувала страх. Видів страху безліч. Страх буває біологічний, коли щось загрожує вашому життю, буває — психологічний, психічний страх, коли на вас щось тисне, і соціальний страх. Страх потрібно зрозуміти і прийняти.

Британська психологиня Люсі Бересфорд говорить, що відчуття страху, тривоги і пригнічення під час війни є невідворотними.
Тривога — це почуття на рівні фізіології, яке попереджує нас про небезпеку, дає можливість долати якість проблеми, що виникають. Тривожні думки
є відлунням негативного досвіду. Як власного, так і чужого.
Тривожність ми можемо розібрати для себе за пунктами, проаналізувавши свої відповіді на такі запитання:
Що саме в мене викликає стан тривожності?
Те, що викликає тривожність, це реальне чи уявне?
Якщо реальне, то як буду діяти, якщо це станеться?
Надавши відповіді на всі запитання, ви наблизитеся до зваженого рішення.
У тривожному стані важливо контролювати свої
емоції та думки. Тим, хто вирішив повернутися, доведеться переживати стан тривоги перед новим, невідомим. Важливо пам’ятати, що турбуватися про несподівані проблеми — нормально.
Подбайте про свій фізичний комфорт. Навіть найпростіші речі можуть повернути вам почуття комфорту та задоволення. Можна розпочати з турботи про себе та своє здоров’я, нормалізувавши режим харчування та сну.
Ізраїльські психологи розробили протоколи, які допомагають людям адаптовуватися до небезпеки без шкоди власному здоров’ю:
Пийте воду, чай або сік: бажано пити ковток води щодесять хвилин. Якщо тобі стане зле, то повільно випий склянку рідини.
Виконуйте техніки заземлення: доторкніться до чогось реального, огляньте простір та зауважте деталі, назвіть шість предметів одного кольору поряд із собою.

Притисніть руки або спину до стіни: фізичний контакт з прохолодною поверхнею дасть точку опори, а також відчуття безпеки.
Після довгої відсутності

вдома рідні люди, друзі, колеги можуть здаватися «іншими», «не такими», тому що під час вашої відсутності ви і вони дійсно змінилися. Зміни — це нормально! У нас за цей рік змінились життєві цінності, звички, погляди тощо. Життя триває і вносить свої корективи. Тому після повернення додому, дайте собі та близьким час на те, щоб звикнути до цих змін. Спілкуйтесь, розповідайте про себе: як ви жили, що бачили, відчували, що робили… Важливо прийняти близьку людину через призму розуміння, любові та поваги.
Знайдіть ресурсні активності. Вони дозволяють відпочити та відновитися. Подумайте, що приносить вам задоволення: заняття домашніми справами, прослуховування музики, перегляд фільмів, спілкування з рідними чи друзями.
Скеруйте увагу на те, що можете контролювати. Вам не підвладні перебіг чи тривалість війни, але є побутові/професійні речі, які залежать від вас. Займайтесь саморозвитком.
Введіть у своє життя довоєнні звички: заняття спортом, кава з улюбленої чашки, догляд за собою тощо.

Дотримуйтесь чотирьох правил: вірте у себе, зберігайте спокій, орієнтуйтесь у будь-якій незвичній ситуації та будьте готові звернутися по допомогу і підтримку.
Поради психолога
Пам’ятайте, що з поверненням все точно не буде так, як раніше, але у вас є сили з цим впоратися тому, що ви вже одного разу зробили крок у невідомість, рятуючись від війни. Ви вижили, ви впорались з цим, ви підтримували себе, наскільки могли. А отже — зможете зробити це ще раз.
•
2023 / березень
• •
modern-pharmacy.com.ua
Журнал «Сучасна фармація»
Арсенал знань • 73
c.75
Лікування безпліддя: з досвіту ніжинського міського пологового
будинку
c.78 Вчені, що розпочали нову еру репродуктивних технологій
c.82 Донорство крові: чому це важливо
c.87 В чому користь фіолетових овочів та фруктів?
c.88
Обмеження калорій уповільнює темпи старіння
Summum bonum medicīnae sanĭtas Найвище благо медицини – здоров’я

У
У СВІТІ МЕДИЦИНИ
СВІТІ МЕДИЦИНИ
Чоловіче та жіноче безпліддя — дуже актуальна проблема як в Україні, так й в усьому світі. За статистикою, частота неплідності складає 15 % серед
всіх сімейних пар. Але дуже часто

безпліддя — не вирок, а лише тимчасова нездатність зачати малюка. За останні
роки технології лікування безпліддя у
жінок та чоловіків настільки інтенсивно
розвиваються, що дозволяють допомогти навіть у найскладніших випадках [1].
НАШ ДОСВІД
Проблемами безпліддя ми почали займатися з 1990 року. Спочатку це було в умовах Ніжинських центральної міської та районної лікарень, а з 1994 року, коли почав працювати Ніжинський міський пологовий будинок, в умовах цього закладу.
На сьогодні в КНП «Ніжинський міський пологовий будинок» створено всі умови для обстеження і лікування безплідних пар. Ми займаємося лікуванням як жіночого, так і чоловічого безпліддя (крім екстракорпорального запліднення).
Була колись ідея створення у нас лабораторії для екстракорпорального запліднення, але близькість столиці, де таких лабораторій (клінік) на сьогодні нараховується більше десяти, а також необхідність вкладання великих коштів для організації такої лабораторії змусили від цієї ідеї відмовитися.



Валерій Якуба, генеральний директор
КНП «Ніжинський пологовий будинок»

Ніжинської міської ради Чернігівської
області, лікар акушер-гінеколог вищої
категорії, Заслужений лікар України, кандидат медичних наук.
ОСНОВНІ ПРИЧИНИ НЕПЛІДНОСТІ
Під неплідністю розуміють неспроможність пари до зачаття протягом одного року регулярного сексуального життя без використання будь-якої контрацепції.
Жінки віком понад 35 років або з відомою причиною неплідності повинні проходити обстеження і лікування раніше цього терміну.
У зв’язку з тенденцією відкладання зачаття в багатьох сімейних парах і зростанням частоти захворювань, що передаються статевим шляхом, а також ановуляції старших жінок, справжня частота неплідності зростає [2].
Найчастіші причини неплідності включають порушення сперматогенезу (40 %); розлади овуляції (30 %); порушення нормальної анатомії жіночого репродуктивного тракту (30 %). Показник чоловічого безпліддя складає 46–48 %, показник, що характеризує жіноче безпліддя, дещо вищий і становить 52–54 %. Трапляються також випадки комбінованого безпліддя, коли обоє із подружжя мають проблеми, що не дозволяють їм зачати дитину. Під час дослідження сімейної пари намагаємося виділити одну або більше причин неплідності, що є можливим в 90 % випадків [3].
Дослідження неплідності проводиться для вирішення наступних завдань:

Вивчення причини неплідності.
Призначення сімейній парі адекватного лікування. Визначення передбачуваного успіху від лікування. Інформування сімейної пари щодо специфічних захворювань подружжя і можливих альтернативних методів лікування [4].
ЛІКУВАННЯ БЕЗПЛІДДЯ: З ДОСВІТУ НІЖИНСЬКОГО МІСЬКОГО ПОЛОГОВОГО БУДИНКУ
Журнал «Сучасна фармація» • modern-pharmacy.com.ua • 2023 / березень • У світі медицини • Думка експерта 75
В цій статті хочу у першу чергу привернути увагу до трубного і маткового факторів безпліддя, які складають 30 % у структурі жіночої неплідності [4]. До нас звертається багато пацієнток саме з цією проблемою. Тазові запальні захворювання, зрощення, ендометріоз, попередні операції на органах таза можуть привести до втрати прохідності фаллопієвих труб. А запліднення, як відомо, відбувається саме в маткових трубах. Тому при госпіталізації безплідної жінки до гінекологічного відділення КНП «Ніжинський міський пологовий будинок» НМР її обстеження починається з методів, які підтверджують, чи виключають трубний чи матковий фактори безпліддя. Для цього використовуються лапароскопія й гістероскопія.
ЛІКУВАННЯ ТРУБНОГО
Лікування трубного фактора неплідності первинно є хірургічним [5]. Напередодні проведення такої
операції жінці проводиться комплексна протизапальна терапія. Паралельно необхідно провести протизапальну терапію й чоловіку з метою запобігання післяопераційних запальних захворювань у жінки й досягнення позитивного ефекту після оперативного лікування трубного безпліддя [6]. Оперативне лікування проводиться відразу після закінчення менструації. З
1990 року таких операцій жінкам спочатку в Ніжинських ЦМЛ і ЦРЛ, а з 1994 року в КНП «Ніжинський міський пологовий будинок» було зроблено понад 1500. Позитивний ефект від лікування настав більше ніж в 1000 випадків.
В 2018 року для КНП «Ніжинський міський пологовий будинок» було придбано хірургічний лапароскоп американської фірми «Straycer», що дозволило нам активно використовувати лікування трубного безпліддя методом хірургічної лапароскопії.
Таких лапароскопічних операцій щорічно проводимо близько 50. Позитивний ефект від лікування у середньому складає 80 %. Але, на жаль, можливості хірургічної лапароскопії при лікуванні перитонеальних форм безпліддя обмежені. Цьому малоінвазивному методу хірургічного лікування заважають обмежений доступ в черевну порожнину й в порожнину малого таза, а також малорухомість інструментів. Тому при значних анатомічних змінах (великих злукових процесах в черевній
порожнині та в порожнині малого таза, наявності великих сактосальпінксів, великих кіст на яєчниках і великої кількості субсерозних й інтрамуральних фіброматозних вузлів тощо) ми надаємо перевагу проведенню
операції відкритим доступом. Це зменшує кількість ускладнень і тривалості операції. Зазвичай проводиться лапаротомія по Пфанненштилю, роз’єднання злуків черевної порожнини й порожнини малого таза, двобіч-

на сальпінгостомія, видалення кіст на яєчниках (якщо вони є) та видалення фіброматозних вузлів на матці
(також, якщо вони є). Операція завершується дренуванням черевної порожнини. Через дренажну трубку в післяопераційному періоді, з метою запобігання злуків, проводиться штучний гідроперітонеум. В черевну порожнину вводяться стерильні розчини для того, щоб тканини між собою не стикалися в перші 8 годин після операції, коли частіше утворюються злуки. Після введення розчинів в черевну порожнину через дренажну трубку, трубка закривається на 10 годин.
Зменшенню утворення злук сприяє також активне ведення раннього післяопераційного періоду. Жінку підіймають на другу добу після операції й змушують активно рухатися [7].
З приводу перитонеальних форм безпліддя відкритим доступом ми оперуємо щорічно близько 60 пацієнток, що складає десь 18–20 % від загальної кількості великих гінекологічних операцій, що проводяться у Ніжинському міському пологовому будинку.


Потрібно відзначити, що зараз більшість українських лікарів акушерів-гінекологів не проводять подібні операції через їх складність. Наші колеги з інших медичних закладів з приводу перитонеальних форм безпліддя виконують в основному лапароскопічні втручання. На жаль, досить часто після таких

Лікар неонатолог

Аліна Гулинська
оглядає дитину
ТРУБНИЙ І МАТКОВИЙ ФАКТОР БЕЗПЛІДДЯ
ФАКТОРА
БЕЗПЛІДДЯ
76 Журнал «Сучасна фармація» • modern-pharmacy.com.ua • 2023 / березень • У світі медицини • Думка експерта
лапароскопічних втручань, в разі відсутності ефекту, доводиться оперувати цих жінок повторно, але вже відкритим доступом.

З появою сучасних репродуктивних технологій, а саме екстракорпорального запліднення, більшість лікарів акушерів-гінекологів (особливо в приватних клініках) взагалі не проводять вищезгаданих операцій, а рекомендують таким жінкам відразу екстракорпоральне запліднення. Але ця маніпуляція дороговартісна і не завжди дає стовідсотковий результат. Більш того, останнім часом клініки репродуктології, яких в Україні вже досить багато (як було згадано вище, в одному Києві їх вже понад десяти) перед проведенням процедури екстракорпорального запліднення чомусь
МАТКОВИЙ ФАКТОР НЕПЛІДНОСТІ
видаляють жінці маткові труби. Але коли після проведення декількох маніпуляцій екстракорпорального запліднення позитивного результату не досягають, то такій жінці в цих клініках можуть порекомендувати лише сурогатне материнство.
Ми дуже бережно ставимося до репродуктивного
здоров’я наших пацієнток та робимо все можливе, щоб надати жінці можливість завагітніти природним шляхом, виносити дитину та успішно її народити. В КНП «Ніжинський міський пологовий будинок» ніколи не видаляється маткова труба при трубній вагітності у жінок репродуктивного віку, особливо якщо жінка ще не народжувала. Ми проводимо видалення плідного яйця з подальшою пластикою маткової труби.
Матковий фактор неплідності може бути представлений внутрішньоматковими синехіями (синдром Ашермана), поліпами, субмукозними лейоміомами. Великі міоми й велика кількість фіброматозних вузлів на матці в разі необхідності збереження репродуктивного здоров’я видаляється шляхом лапаротомії [8]. Щорічно проводимо 20-25 цих операцій. За останні 30 років таких операцій було проведено 615.
Поліпи, підслизові фіброматозні вузли видаляються за допомогою гістероскопа [9]. Таких операцій проводиться на рік в середньому 15. Вроджені аномалії матки, наприклад, перетинка в матці, дворога матка чи двійна матка лікуються в нас за допомогою гістероскопії або маткової метропластики. За останні 30 років ми зробили 45 таких операцій. ЛІКУВАННЯ ЧОЛОВІЧОЇ
В КНП «Ніжинський міський пологовий будинок» також проводиться лікування чоловічої неплідності. Це лікування проводиться сумісно з лікарем-урологом. У чоловіків найчастіші причини безплідності — це гормональні або генетичні порушення, що обумовлюють зміни якості та кількості сперми, непрохідність сім’явиносної протоки внаслідок гострих та хронічних інфекцій, що передаються статевим шляхом, імунологічний фактор тощо. Зазвичай обстеження чоловіка та жінки з приводу безпліддя починають одночасно [10].
Також ми розв’язуємо проблему в разі імунологічної несумісності чоловіка та жінки. При імунологічній формі безпліддя проводимо інсемінацію, при якій
Література
1. Іванюта Л. І. Неплідність у шлюбі: діагностика та принципи лікування // Лікування та діагностика.—1999.— № 1.— С. 42–48.
2. Inhorn M, Patrizio P. Infertility aroundthe globe: new thinking on gender,reproductive technologies and global movements in the 21st century. Hum. Reprod. Update. 2015;21(4):411-26.
3. Van den Bosch, T. Intra-cavitary uterine pathology in women with abnormal uterine bleeding: a prospective study of 1220 women [Text] / T. Van den Bosch, L. Ameye, D. Van Schoubroeck, T. Bourne, D. Timmerman // Timmerman Facts Views Vis Obgyn. — 2015. — Vol. 7, Issue 1. — P. 17–24.
4. Венцківська І.Б .,Загородня О.С. Жіночі чинники неплідності у шлюбі.// HEALTH OF MAN / Здоров’я чоловіка (Online). — 2021. — №2 (77). — С.8-13.
5. Оперативна гінекологія : навч. посібник / Ю. С. Паращук, М. Г. Грищенко, В. Ю. Паращук, Р. А. Сафонов. — Харків : ХНМУ, 2017. — C. 105-107.
НЕПЛІДНОСТІ
Валерій Якуба з новонародженим
сперму чоловіка вводимо безпосередньо всередину матки, минаючи цервікальний бар’єр.
Я завжди кажу своїм пацієнтам: «Не варто зневірятися! Адже в більшості випадків лікування безпліддя проходить вдало, і ви зможете народити дитину! Якщо ви хочете скоріше розв’язувати цю проблему, то оберіть собі клініку, якій ви довіритесь, та лікаря, який буде займатись Вами від початку лікування до народження дитинки». А своїм колегам-лікарям раджу відразу встановити з пацієнтами довірливі відносини й займатися ними від початку до успішного вирішення проблеми. Інакше справа не рушиться, бо скільки лікарів, стільки й думок.
6. Туманова Л.Є. , Коломієць О.В. Терапевтичні можливості прегравідарної підготовки у жінок з поєднаною безплідністю в анамнезі//Репродуктивне здоров’я жінки .-2022.-№2.-С.53-58
7. Акушерство: підручник / [Пирогова В. І., Булавенко О. В., Вдовиченко Ю. П. та ін.; за заг. ред. Пирогової В. І.] Вінниця: Нова Книга.С.102-105
8. Congenital uterine anomalies in pregnancy / R. Valle, M. Covacevic, N. Lusic, K. Vukisk // Jugosl. Gynecol. Perinatol.— 1991.— Vol. 35, N 56.— P. 117–119.

9. Check J.H. Failure to improve a thin endometrium in the late proliferative phase with uterine infusion of granulocyte-colony stimulating factor / J.H. Check, R. Cohen, J.K. Choe // Clin Exp Obstet Gynecol. — 2014. –Vol. 41 (4). — P. 473–475.

10. Поворознюк М.В. Чоловічий фактор безплідного шлюбу у практиці акушера-гінеколога: запитання та відповіді.//Медичні аспекти здоров’я жінок. — 2020. — № 6 (135).-С. 57-61.

Журнал
фармація» •
• 2023 / березень • У світі медицини • Думка експерта 77
«Сучасна
modern-pharmacy.com.ua
ВЧЕНІ, що розпочали НОВУ ЕРУ
репродуктивних технологій
Кириченко Людмила, провізор, магістр педагогіки A
У наші дні у світі та в Україні існують біоетичні проблеми, що стосуються репродуктивних технологій. Кожна людина має право бути зачатою у подружньому єднанні двох людей, а потім народитися та зростати у своїй родини з генетичними батьками. Але у країнах світу та в нашій країні кожного року зростає число подружніх пар, що мають проблему безпліддя. Тому постійно збільшується попит на використання сучасних репродуктивних технологій.
ЦІКАВO!
Першою жінкою-вченою, що успішно запліднила людську яйцеклітину в пробірці, при цьому зробивши вагомий вклад у репродуктивну медицину світу, була Міріам Менкін. Але у наші часи її ім’я мало відоме, сучасне суспільство знає про неї не так багато. Важливе відкриття відбулося у лютому 1944 року.
Міріам Менкін на той час пропрацювала вже шість років лаборанткою
гарвардського вченого-репродуктолога Джона Рока. Професор Джон Рок проводив дослідження у своїй медичній практиці та виявив, що частіше жінки зі здоровими яєчниками не могли завагітніти через проблеми з матковими трубами.

Штучне запліднення могло б вирішити проблему багатьох сімей. Кожної середи у лабораторії лаборантка Міріам Менкін
вводила яйцеклітину в розчин сперми
у пробірці десь на 30 хвилин для того, щоб дві клітини об’єдналися в одне ціле.
Метою спроб було запліднення яйцеклітини за межами людського організму.


Але цього разу Менкін була втомлена, не така уважна і занурення тривало набагато
більше ніж раніше. Відбулося щось дивовижне: клітини об’єдналися та почали швидко ділитися. У пробірці можна було
побачити перший у світі запліднений
людський ембріон за межами організму.
Перше успішне запліднення яйцеклітини відбулося у безкоштовній жіночій лікарні в Брукліні, штат Массачусетс.
Відкриття та досягнення Міріам Менкін відкрило новий етап в репродуктивній медицині світу. Після того жінки, що мали проблеми із заплідненням, тепер мали змогу завагітніти, а лікарі-вчені постійно спостерігати за розвитком ембріонів навіть на ранніх етапах.
ЦІКАВІ ФАКТИ!
Перша дитина, що була зачата за допомогою


екстракорпорального запліднення, народилася
у 1978 році. Це була Луїза Браун. У 2018 році їй виповнилося вже 40 років. Все її життя проходило під пильним наглядом медиків та увагою журналістів.
Лікарі та батьки не зберігали таємницю її зачаття та й сама Луїза теж.
78 Журнал «Сучасна фармація» • modern-pharmacy.com.ua • 2023 / березень • У світі медицини • Хронограф
Мати Луїзи зверталася до лікарів зі скаргою на глибоку депресію, тому через цей психічний розлад, було неможливим завагітніти від свого чоловіка. Молоде подружжя дуже хотіло мати дитини і було готове на все. Лікарям одразу вдалося умовити їх на такий революційний крок, на ті часи на науковий експеримент — штучного запліднення.
Сам метод екстракорпорального запліднення був розроблений в Великобританії такими вченими, як Роберт Едвардс, Жан Перді, Патрік Стептоу. За допомогою цього методу передбачалося лікувати безпліддя жінок, що мали непрохідність маткових труб. Крім того, ще необхідно було розробити спосіб вилучення яйцеклітини з організму для подальшого запліднення в пробірці та занурення утвореного ембріона в порожнину матки. Вчені працювали над цим більше 10 років і все зберігалося в таємниці.


Згодом штучне запліднення стало дуже прибутковим бізнесом. У 2017 року екстракорпоральне запліднення використовувалося як основний метод репродуктивної медицини приблизно біля 300 тисяч спроб зачати дитину у США. В результаті народилися близько 80 тисяч дітей, таких як і Луїза Браун.

Не дивлячись на те, що розповідала Міріам Менкін при свій винахід, її успіх зовсім не був випадковим. Усі
важливі та видатні відкриття завжди бувають результатом років досліджень, значних зусиль та терпіння виконувати один і той же експеримент багато разів.
Дослідниця Міріам Менкін написала сама або була співавтором 18 наукових статей, 2 доповідей у журналі «Science», які описували перше вдале зачаття в пробірці.
На відміну від лікаря Джона Рока, ім’я Міріам Менкін не стало таким відомим. Але вона була не тільки лаборанткою, а й науковою співробітницею, професіоналом, що виконував складну роботу.
Роберт Едвардс — один із засновників сучасного ЕКЗ
ТАК ХТО Ж ТАКА БУЛА МІРІАМ МІНКІН, ЦІКАВО, ЩО ПРО НЕЇ МОЖНА ДІЗНАТИСЯ?
Народилася Міріам 8 серпня 1901 року в столиці Латвії Ризі у родині Фрідман. Невдовзі родина емігрувала до США. Батько Міріам працював лікарем, добре заробляв, завдяки чому дівчинка
мала гарне дитинство.У дитинстві

Міріам слухала багато розповідей батька про науку, про медицину, про ліки. Тому Міріам Фрідман вступила до Корнелльського університету на спеціальність «Гістологія та порівняльна анатомія», який закінчила у 1922 році.
У 1923 році Міріам здобула ступінь магістра генетики в Колумбійському університеті. Потім якийсь час викладала фізіологію та біологію в Нью-Йорку.
Коли Міріам хотіла вступити до медичної школи, їй відмовили. Відомо, що у той час більшість престижних медичних шкіл майже не приймали жінок або мали обмежену кількість місць для жінок.

Міріам Фрідман вийшла заміж за студента медичного факультету Гарвардського університету Велі Менкіна.
Для того, щоб допомогти чоловікові, поки він вчився, Міріам працювала секретаркою, отримала ступінь бакалавра за секретарською спеціальністю.
Потім Міріам Менкін пройшла курси з бактеріології та ембріології.
Після чого вона змогла допомагати чоловікові з різними експериментами в умовах лабораторії.
Саме тоді Міріам познайомилася
з Грегорі Пінкусом, біологом Гарвардського університету. Згодом Грегорі Пінкус разом із Роком працюватимуть та розроблять протизаплідні пігулки.
Вчений Грегорі Пінкус успішно здійснив штучне запліднення кролиці, після чого народилося здорове потомство. Пінкус доручив Міріам Менкін виділити з гіпофіза кролиці
два гормони та ввести їх у матку, щоб вплинути на овуляцію додаткових яйцеклітин. Міріам успішно виконала завдання. У 1937 року Грегорі Пінкусу не продовжили термін роботи в університеті і він поїхав до Англії. Міріам Менкін втратила тоді роботу.
ЦІКАВО!
Після створення протизаплідних таблеток почалися випробування, які в 1952 — 1953 роках Пінкус проводив на добровольцях, пацієнтках лікаря Джона Рока (на фото вижче), що мали проблеми із заплідненням. А вже в 1956 році почалися випробування на жінках, які були здатні до народження дітей. Але усі дослідження довелося перенести в Пуерто-Ріко, так як майже по всій території США було заборонено продаж контрацептивів на законодавчому рівні.

ЦІКАВO! Журнал «Сучасна фармація» • modern-pharmacy.com.ua • 2023 / березень • У світі медицини • Хронограф 79
Згодом продаж протизаплідних таблеток розпочали
в Мексиці, в США (в Каліфорнії) та на острові Гаїті.
Усі дослідження та експерименти, що проводив Грегорі Пінкус з репродуктивних технологій у тварин, потім продовжив Джон Рок. Він розпочав клінічні дослідження методу.
Міріам Менкін подала заявку на роботу до лабораторії Джона Рока та отримала позитивну відповідь, її прийняли. Міріам була наполегливою, розумною та уважною до роботи, до дрібних деталей та фактів, що було ідеальним для Джона Рока. Він був талановитим вченим, але мав небагато терпіння до кропіткої роботи в лабораторії. А от спокійна, цікава та кропітка робота у лабораторії дуже подобалося Міріам.
Відомо, що кожного вівторка о восьмій ранку Міріам
Менкін приходила до операційної кімнати благодійної
жіночої лікарні в Брукліні. Досить часто професор
Джон Рок передавав їй невеликий фрагмент яєчника,
який він видалив у однієї із пацієнток. Міріам одразу
несла його до лабораторії та виділяла яйцеклітину, хоча
це було складним завданням. Взагалі, яйцеклітина —
це одна з найбільших клітин в організмі людини, вона
все одно має дуже малий розмір.
Для Міріам Менкін було дуже важливим те, що
вона змогла зробити. Вона побачила яйцеклітину
неозброєним оком і чітко визначили ще й те, має деформацію яйцеклітина чи ні. Міріам сама себе жартома називала «мисливицею за яйцеклітинами».
Менкін постійно виконувала одну й ту саму процедуру кожного вівторка.
Виділяла яйцеклітину, а вже у середу змішувала її зі зразком сперми. Потім у четвер ще чекала якийсь час,
ВАЖЛИВО!
Ембріон утворюється на початку
запліднення та розвивається
далі ще 8 тижнів. За цей час відбуваються основні стадії ембріонального розвитку, а саме, утворюється тіло, яке вже має основні морфологічні ознаки
людини. Коли закінчується
8-й тиждень, довжина
зародка становить 40 мм, а
його маса близько 5 грамів.
Ембріон завжди оточений
зародковими оболонками, що
виявляють захисну функцію
та забезпечують обмін речовин
між ембріонам
та навколишнім
середовищем.
Під мікроскопом яйцеклітину першим побачив Карл Бер у 1827 році. Він був нагороджений
золотою медаллю за наукові заслуги, на якій був надпис латинською мовою
«Orsus ab ovo hominem homini




ostendit» (Почавши з яйця він
показав людині людину).
а у п’ятницю зазвичай дивилася в мікроскоп. Та кожної п’ятниці Міріам поки що бачила одне й те ж — досі незапліднене яйце та багато мертвих сперматозоїдів навколо нього. Все це вона повторила 138 разів протягом шести років. Міріам Менкін, як виявилося, була дуже наполегливою та прискіпливою.
І от, тієї незвичайної п’ятниці в лютому 1944 року, коли Міріам відчинила дверцята інкубатора, вона від радощів скрикнула та

одразу подзвонила Джону Року. У той
час він був десь на іншому кінці міста в лікарні.
До лабораторії прийшов Рок та швидко збіглися інші люди, так як всі хотіли побачити людський ембріон у перші години після зачаття. Усім було дуже цікаво. Вони були просто у захваті.
Міріам Менкін схвильована та боялася навіть відвести погляд від заплідненої яйцеклітини, що усі шість років залишалося майже нездійсненою мрією.
Для того, щоб зберегти її, Міріам по краплинці додавала в пробірку рідину. Цілі дні Міріам Менкін проводила у лабораторії, майже не відходячи від пробірки. Однією рукою тримала та їла бутерброд, а іншою — додавала необхідну кількість рідини. Проте, все ж таки та перша яйцеклітина таки «втекла». Стався так «перший викидень у пробірці». А Міріам Менкін так просто не здавалася, й ще тричі вдалося повторити той успіх, створивши ще одну двоклітинну зиготу та дві триклітинні. Вона помістила їх та зафіксувала на склі, потім пофарбувала червоним та синім кольором. Такий зразок відправила до Інституту Карнегі у Вашингтоні, в Балтиморі. Ці зразки були дуже цінними, так як це було доказом того, що було отримано ембріон.
Після того, як зразки дісталися інституту у Вашингтона, Джон Рок та Міріам Менкін почали отримувати сотнями листи від жінок, що були безплідними, із запитаннями та проханням допомогти їм.
ЦІКАВO!
80 Журнал «Сучасна фармація» •
• 2023 / березень • У світі медицини • Хронограф
modern-pharmacy.com.ua
Відомо, що Міріам Менкін хотіла стати вченим-репродуктологом, вона сподівалася розширити ще далі кордони репродуктивної медицини. Міріам поставила собі за мету виростити запліднене яйце до чотирьох клітин, потім ще до восьми, а може ще більше.
Але цьому стало на заваді тоді те, що чоловік Міріам втратив роботу.
І вона, як дружина і мати, поїхала разом із ним до університету Дюка, що знаходився у штаті Північна Кароліна. На той час вчені та лікарі університету Дюка вважали екстракорпоральне запліднення (ЕКЗ) неприйнятним.
Після того, як Міріам Менкін поїхала з чоловіком, у Бостоні припинилися усі дослідження по екстракорпоральному заплідненню. Не вистачало навичок, якими володіла
Міріам. Ні одна з помічниць Джона Рока так і не мала змогу запліднити яйцеклітину в пробірці.
Пройшов деякий час і наполегливість та вдача допомогли Міріам Менкін знову повернутися до своїх досліджень. Скільки б разів і куди б не переїздила Міріам, вона завжди шукала можливостей продовжити експерименти та дослідження. Міріам Менкін просила Джона Рока написати рекомендаційні
листи та з ними зверталася до видатних вчених-репродуктологів. Коли не вдавалося потрапити до наукової лабораторії, вона все одно продовжувала працювати з Джоном Роком віддалено.
Разом вони у 1948 році опублікували повний звіт про перше успішне екстракорпоральне запліднення в журналі «Sciencе». Прізвище та ім’я Міріам Менкін стояло на першому місці опублікованих наукових матеріалів.

Але невдовзі дослідниця Менкін стикнулася з проблемами в шлюбі і вона вирішила піти від чоловіка. Тоді Міріам
Менкін знайшла адвоката та одразу подала на розлучення.
Міріам отримала повну опіку над донькою. Матері-одиначці було досить важко у матеріальному плані. Крім того, донька Міріам (на фото) хворіла на епілепсію і їй були
потрібні гарні лікарі.
Міріам Менкін досить часто пропонували безоплатно працювати в лабораторії вночі або на вихідних, але вона часто не могла цього зробити через проблеми зі здоров’ям дитини.
Коли на початку 50-х років Міріам Менкін переїхала до Бостона, вона знову повернулася в лабораторію
до Джона Рока. За ті роки, що пройшли, багато усього змінилося і основним завданням репродуктивної медицини було вже не збільшення народжуваності дітей, а навпаки, запобігання цьому.



Джон Рок на той час мав власну лабораторію, де проводив дослідження та займався розробкою методів контрацепції. У 1960 році результатом тих досліджень було отримання дозволу на використання протизаплідних пігулок.
Міріам Менкін була помічницею Джона Рока, яка вивчала багато теорії з питань та тем дослідження. Міріам завжди дуже співчувала жінкам, що мали проблеми із заплідненням, тому дійсно пишалася тим, що працює над репродуктивними технологіями, що зможуть допомогти їм народити здорових дітей.
Досить цікавим та незвичним було те, що особисте ставлення Міріам Менкін до екстракорпорального запліднення було негативним. Вона казала, що сама ніколи не хотіла б скористатися цим методом. При цьому її справжнім захопленням була можливість відчути себе частиною великого наукового проекту.
Проблеми у особистому житті дуже обмежили її подальший науковий розвиток.
ВАЖЛИВО!
За останніми
даними
вчених та
лікарів, майже
800 тисяч
пар в Україні
не можуть зачати
дитину. При детальному

обстеженні пари в 30-50
% випадках виявляється, що є причини і в чоловіка, і в жінки. Причин
зазвичай буває декілька, це все враховують
під час лікування. На сьогоднішній день
проблема безпліддя
досить серйозна як в Україні, так і в світі.
У багатьох історичних записах здобуток Міріам Менкін у штучному заплідненні списують на випадковість та на збіг обставин у певний час у певному місці. Але варто згадати скільки теоретичних данних опрацювала ця жінка, скільки провела експериментів, скільки ретельних записів вона зробила. Завдяки цьому можна зробити висновок про гарний розум, а також наполегливість та допитливість справжнього науковця. МІРІАМ МЕНКІН, ДЖОН
РОК ТА БАГАТО ІНШИХ ВЧЕНИХ ЗРОБИЛИ ЗНАЧНИЙ ВКЛАД У РОЗВИТОК РЕПРОДУКТИВНОЇ МЕДИЦИНИ, МЕТОДИ ТА ТЕХНОЛОГІЇ ЯКОЇ У СУЧАСНОМУ СВІТІ ДОПОМАГАЮТЬ
ЛЮДЯМ У ПРОДОВЖЕННІ СВОГО РОДУ.
БАГАТЬОМ
Журнал «Сучасна фармація» • modern-pharmacy.com.ua • 2023 / березень • У світі медицини • Хронограф 81
ДОНОРСТВО КРОВІ:
ЧОМУ ЦЕ ВАЖЛИВО
AЛитвинова Ольга Миколаївна , доктор медичних наук, професор кафедри клінічної лабораторної діагностики НФаУ


На сьогоднішній день важко уявити медицину без гемотрансфузії. Саме тому проблема донорства є однією із найважливіших у всьому світі. Практично кожна країна потребує збільшення числа донорів. Без достатнього запасу крові та її компонентів в лікарнях стає неможливим надання якісної медичної допомоги. Кожен третій житель Землі хоча б раз у житті мав потребу у донорської крові [1].
Щорічно в нашій країні близько 1,5 млн людей потребує переливання крові. Особливості глобалізації сучасного світу незворотньо веде до зростання числа виробничих та транспортних аварій з катастрофічними наслідками, які супроводжуються масовим травматизмом і загибеллю людей [2].



Повномасштабна війна, спричинена вторгненням російської армії в Україну, докорінно змінила все наше життя. Незважаючи на всі жахіття, народ України демонструє справжні дива — дива єдності, хоробрості, незламності. Наші захисники дивують увесь світ своїм завзяттям та бойовою майстерністю, а люди — гідно віддячують їм своєю підтримкою. В умовах воєнного стану стале забезпечення донорською кров’ю та її компонентами є однією з умов забезпечення обороноздатності країни та запорукою її національної безпеки. Війна створює нові виклики: кров потрібна щодня як для порятунку українських воїнів, так і для мирних громадян, які страждають від агресії, розв’язаної російською федерацією. В реаліях
сьогоднішньої війни українці в тилу повинні робити все залежне, аби зберегти життя кожному бійцю. Донорської крові потребують також і цивільні, що постраждали від воєнних дій.
Щодня до лікарень прибувають нові поранені бійці
і їм можливо допомогти, здавши кров, яка рятує життя військових. Потреба в донорській крові лишатиметься стабільно високою аж до перемоги, а донорство крові та її компонентів вносить свій вклад у цю перемогу.
Не скасувала війна і планових ургентних операцій, онкологічних захворювань, ускладнених пологів. В Україні завжди існував дефіцит донорської крові, й наразі ця проблема стала особливо гострою. Виникненням дефіциту продуктів донорської крові, яка є необхідною при надзвичайних ситуаціях у великій кількості, в клінічній практиці створює великі труднощі в лікуванні найбільш небезпечних захворювань і їх ускладнень. Тому донорство крові та її компонентів є одним із базових факторів розвитку високотехнологічної медичної допомоги [3].
Зараз посилені вимоги якості заготовлення крові та її компонентів у зв’язку з розповсюдженням соціальних захворювань (сифілісу, туберкульозу, гепатиту В, С, ВІЛ-інфекції, алкоголізму, наркоманії та ін.), що активізує пошуки нових підходів для забезпечення нормативних потреб в компонентах і препаратах крові та взаємодії служби крові з донорами [4].
СЛУЖБА КРОВІ — важлива складова охорони здоров’я, яка забезпечує можливість надання спеціалізованої медичної допомоги у мирний час та у надзвичайних ситуаціях, використовуючи унікальний ресурс — кров донорів [4].
82 Журнал «Сучасна фармація» • modern-pharmacy.com.ua • 2023 / березень • У світі медицини • Це цікаво
Основні принципи донорства крови та
компонентів:
безпека донорської крови та її компонентів;
(або) її
добровільність здачі крові та (або) її компонентів;
збереження здоров’я донора при виконанні його
донорської функції;
забезпечення соціальної підтримки та забезпечення прав донорів;
заохочення та підтримка безоплатного донорства
крові (або) її компонентів.
ДОНОРСТВО — добровільний акт
волевиявлення людини, що полягає у даванні

крові або її компонентів для подальшого
безпосереднього використання їх для лікування, виготовлення відповідних лікарських препаратів або використання у наукових дослідженнях [5].


Обстеження донорів проводять на станції переливання крові чи у відділенні переливання крові в лікарні. Його краще зробити з 9 до 11 ранку. Перед цим не можна вживати їжу. Результати аналізу будуть відомі наступного дня. Якщо протипоказань до донорства не виявлено, можна домовитися про дату донації крові. Результат аналізу дійсний упродовж 5 діб. Процедура тромбоцитоферезу займає приблизно півтори години.
Донора підключають до сепаратора крові. Усі фільтри та обладнання підготовані для разового використання. Із вени апарат забирає кров, відфільтровує, залишає тільки тромбоцити та невелику кількість плазми крові, яка необхідна для підтримання тромбоцитів у життєздатному стані. Інші компоненти крові відразу повертають людині. Тромбоцитарну масу забирають в об’ємі приблизно 200 мл. Для адекватного проходження процедури донорові вводять невеликий об’єм розчину антикоагулянту для запобігання згортання крові в голці системи для забору.
Процедура безпечна й автоматизована. Її проводять після аналізу крові на рівень тромбоцитів, який виключає негативний вплив на процес згортання крові в донора. Системи для центрифугування крові
і відділення компонентів дороговартісні й одноразові — під час процедури донор не може нічим заразитися.


Донорство плазми крові працює за аналогічним методом до здавання тромбоцитів. Займає до 2 год. упродовж одного дня.
За ручного плазмаферезу кров забирають у стерильну систему (як за звичайної донації), центрифугують, розділяють на еритроцитарну масу та плазму з використанням плазмоекстрактора, після чого еритроцитарну масу повертають донору. Об’єм крові, що циркулює, заповнюють уведенням адекватної кількості фізіологічного розчину. В наш час ручний метод майже не використовується.
За автоматичного плазмаферезу донора підключають через спеціальну систему до сепаратора та забирають безпосередньо плазму крові. Як і у випадку з донацією тромбоцитів, сепараторні системи є одноразовими, що виключає ймовірність інфікування донора.
Перед донацією потрібно пройти стандартні обстеження крові. Також проводять біохімічний аналіз крові на рівень загального білка та білірубіну для визначення наявності протипоказань. Процедура триває близько 40 хв., а з урахуванням усіх формальностей — приблизно 2 год. Для здавання плазми
Журнал «Сучасна фармація» • modern-pharmacy.com.ua • 2023 / березень • У світі медицини • Це цікаво 83
необхідно дотримуватися адекватного питного
режиму — випивати 1,5-2,0 л води на день.
Об’єм узятої плазми не повинен перевищу-
вати 600 мл за один сеанс. Людям, маса тіла
яких менша за 50 кг, не дозволяють здава-

ти понад 12 % від усього об’єму крові, що
циркулює. Він складає 6,5–7 % від маси
тіла. Мінімальна перерва між двома
донорськими сеансами має становити
не менш як два тижні. За рік можна
здавати не більше 12 л плазми.
Плазму в Україні можна зберігати протягом 3-х років. Перш ніж вона
потрапить в банк крові, її заморожують.
В
Україні донори можуть здавати кров, як безкоштовно, так і за оплату. При цьому донори класифікуються не по типу винагороди, а по типу частоти здачі крові
За час зберігання і плазма, і клітини крові
проходять перевірку на наявність вірусів. Тільки після цього компоненти крові можна використовувати
для переливання. Карантин для плазми закінчується
через шість місяців, адже деякі інфекції можуть проявити себе тільки через певний час.
Донорство одного з різновидів лейкоцитів — гранулоцитів — тривала та складна процедура. За 8-12
годин до донації слід отримати ін’єкцію препарату, який стимулює активне вироблення
лейкоцитів. Препарат вважають безпечним

для донора, проте лікарі не виключають
індивідуальні реакції: слабкість, нудоту чи підвищення температури. Донація триває
від години до двох і проводиться методом аферезу. Зібрані гранулоцити переливають упродовж 24 годин. Гранулоцити

застосовують для пацієнтів, що проходять курс хімієтерапії або трансплантацію кісткового мозку, а також для тих, у кого розвивається бактеріальна або грибкова інфекція, яку не можуть подолати антимікробні засоби.
Замість цільної крові сьогодні використовують її окремі компоненти, оскіль-
ки насправді зберігати цільну кров неможливо. З першої ж мілісекунди, як вона виходить із вени, в ній відбуваються незворотні зміни. Тромбоцити починають злипатись між собою, лейкоцити — виділяти активні речовини, оскільки вони реагують на нове середовище. Лікарські препарати, що отримують з донорської плазми крові людини, потрібні практично в усіх областях медицини. В даний час найбільше застосовують найновіші гіперімунні внутрішньовенні імуноглобуліни, розчин альбуміну та концентрати факторів згортання крові. Вони широко використовуються для терапії екстрених станів, загрозливих життю, для заміщення терапії при важких хронічних захворюваннях, при лікуванні спадкових захворювань та при здійсненні високотехнологічної медичної допомоги [6].
В Україні рівень донорської активності не високий. Критична кількість в банку крові України — O(I) та AB(IV) резус-негативних груп крові. Також в багатьох областях центри крові можуть забезпечити поточні потреби, але не мають запасу крові таких груп: A(II) +, B(III)+ та AB(IV)+. Щоб забезпечити достатню кількість донорської крові, кожна країна потребує щонайменше 20–25 регулярних донорів на 1 000 жителів [7]. За даними ВООЗ, в 62 країнах донорство повністю безоплатне, засноване на гуманному бажанні допомогти пацієнтам і відповідальному відношенню донора до свого власного здоров’я. Як показує світова та державна практика, розвиток безоплатного та регулярного донорства крові є головною умовою забезпечення максимальної безпеки компонентів для реципієнтів та ефективного функціонування служби крови [9].
В Україні донори можуть здавати кров як безкоштовно, так і за оплату. При цьому донори класифікуються не по типу винагороди, а по типу частоти здачі крові: донори, які здають кров в одному місці більше трьох разів на рік, можуть бути закріплені до цього закладу як активні (кадрові, регулярні), інших донорів називають донорами резерву (первинні).
Вимоги до донорської крові та її компонентів надзвичайно високі, тому що повинна бути максимально збережена біологічна повноцінність і функціональна активність. Щоб захистити виробництво від негативних впливів персоналу, необхідно чітко регламентувати його дії, а також здійснювати строгий виробничий контроль. За кордоном для здійснення цієї цілі були розроблені діючі міжнародні і національні стандарти (стандарти ВООЗ,
84 Журнал «Сучасна фармація» • modern-pharmacy.com.ua • 2023 / березень • У світі медицини • Це цікаво
Британські та Американські і т.п.). Ці документи призначені для покращення якості та гарантії ефективності, безпечності трансфузійної крові та її компонентів [10, 11].
Відносини у сфері донорства крові та її компонентів в Україні регулюються Законом України № 931-IX від 25.02.2021 р. «Про безпеку та якість донорської крові та компонентів крові». Також іншими законами, а саме:
1) «Основи законодавства України про охорону здоров’я»;
2) «Про ратифікацію Угоди про асоціацію між Україною, з однієї сторони, та Європейським Союзом, Європейським співтовариством з атомної енергії та їх державами-членами, з іншої сторони»;
3) «Про забезпечення санітарного та епідемічного благополуччя населення»;
4) «Про захист населення від інфекційних хвороб»;
5) «Про протидію поширенню хвороб, зумовлених вірусом імунодефіциту людини (ВІЛ), та правовий і соціальний захист людей, які живуть з ВІЛ» [13].
Вся правова база, що визначає стандарти якості крові та її компонентів, викладена в Директиві 2002/98/ЄС, яка також називається Європейською директивою, щодо крові. Вона охоплює всі етапи переливання: від здавання, збирання, випробування, обробки та зберігання до розповсюдження. Для покращення виконання головного акту Європейська комісія запропонувала та ухвалила у тісній співпраці з національними органами ЄС такі додаткові виконавчі акти:
Директива Комісії 2004/33/ЄС про технічні вимоги
до крові та здавання крові;
Директива 2005/61/ЄС Комісії про відстеження ви-
мог та обов’язків щодо повідомлення у разі серйозних побічних реакцій та подій;
Директива Комісії 2005/62/ЄС, яка запроваджує
стандарти ЄС та характеристики, що стосуються
системи якості банку крові;
Директиви Комісії 2009/135/ЄС, 2011/38/ЄС, 2014/110/ЄС, 2016/1214 стосуються деяких інших
конкретних технічних вимог [13].
Відбір донорів крові проводиться по профілактичному принципу: донору мінімум шкоди, реципієнту — максимум користі. В донорській крові не повинно бути вірусів, паразитів, алкоголю та інших факторів, які можуть нашкодити здоров’ю хворого. Інфекції, що передаються через кров, змушують банки крові і орга-
ни охорони здоров’я проявляти надмірну обережність [12]. Очікування громадськості посилюють цю політику і вводять все більш суворі критерії прийнятності донорів. Міжнародна практика засвідчує, що для гарантування максимальної
інфекційної безпеки продуктів крові необхідно дотримання таких умов:
Забезпечити донорською кров’ю госпіталі тільки від громадян своєї країни.
Суворий відбір донорів.
Якісне обстеження кожної дози донорської крові.
Використання технологій, які знищують віруси в процесі виготовлення препаратів з крові [14, 15]. Для відбору донорів використовують 3 основних етапи:
1. Реєстрація донорів — здійснюється на основі оригіналу документів, що засвідчує особу. Донором крові та її компонентів може бути будь-який дієздатний громадянин України, іноземець чи особа без громадянства, яка має посвідку на постійне проживання на території України. Донор, в обов’язковому порядку, заповнює відповідну документацію, яка відповідає вимогам МОЗ України .
•
У світі медицини
•
2023 / березень
•
За даними ВООЗ в 62 країнах донорства повністю безоплатне, засноване на гуманному бажанні допомогти пацієнтам і відповідальному відношенню донора до свого власного здоров’я. •
Це цікаво 85
modern-pharmacy.com.ua




2. Медичне обстеження донорів. Згідно Закону України № 931-IX від 30.09.2020 р. «Про безпеку та якість донорської крові та компонентів крові», усі донори повинні пройти медичне обстеження згідно порядку «Про медичне обстеження донорів крові та її компонентів» від 08.02.2021р. Донором може бути тільки особа, яка досягла 18 років та має масу тіла більше 50 кг. Перед медичним обстеженням донор повинен заповнити анкету про свій стан здоров’я. Медичний працівник повинен її проаналізувати, після чого огляЖурнал «Сучасна фармація»
нути шкірні покриви, видимі слизові, склеру, лімфатичні вузли донора. Медичний працівник керується критеріями відсторонення донорів, які прописані у порядку «Про медичне обстеження донорів крові та її компонентів» [13].
3. Клінічна лабораторна діагностика. Загалом, в структуру лабораторії донорських центрів входять
такі підрозділи:
імуногематологічної (ізосерологічної) сертифікації крові донорів та хворих — визначення імуногенетичних маркерів клітин та плазми периферичної крові, виявлення імунних антитіл до них у донорів та хворих, індивідуальний підбір компонентів крові;
гематологічної та біохімічної сертифікації донорів крові — визначення основних гематологічних (Hb, Ht, кількість еритроцитів, тромбоцитів) та біохімічних показників ( АЛТ, білірубін, білок та білкові фракції) у донорів крові, плазмота цитоферез; інфекційної сертифікації крові донорів та хворих — виявлення серологічних маркерів гемотран-
смісивних інфекцій, у донорів крові, хворих та медперсоналу; генодіагностики — ПЛР-діагностика гемотрансмісивних інфекцій ПЛР-типування антигенів груп крові [13, 14, 15].
Донором може стати практично будь-яка здорова людина у віці від 18 до 60 років, якщо вона не має протипоказань. Люди з масою тіла менше 50 кг або зрості менше 150 см допускаються до донорства в індивідуальному порядку лікарем-трансфузіологом. При цьому об’єм однієї донації не повинен перевищувати 12 % об’єму циркулюючої крові. Стандартний об’єм заготівлі крові (донації) 450 ± 50 мл без урахування кількості крові, що взяли для аналізів (до 40 мл). Для будь-якої здорової дорослої людини процес донації крові є безпечним і не завдає шкоди організму. Повторні донації крові сприятливо впливають на центральну нервову систему, а через неї на обмінні процеси в усьому організмі. За даними останніх досліджень, чоловіки, що здають кров, на 30 % менше страждають захворюваннями серцево-судинної системи; в десятки разів менше схильні до інфаркту міокарду, крім того регулярна донація крові підтримує на належному рівні вміст холестерину, що, в свою чергу, попереджає розвиток атеросклерозу.
КРОВ — це найцінніше з того, що людина може дати іншій людині. Це дар життя. Рішення здати кров може врятувати життя або навіть кілька життів.
Таким чином, зараз вкрай важливо збільшувати запаси безпечної і якісної донорської крові, яка допомагає лікарям рятувати життя як військових, так і цивільних громадян; проводити планові операції в тилу, приймати пологи, здійснювати трансплантації.
ЛІТЕРАТУРА
1. Гайдукова С.М. Трансфузіологія : навч. посіб. / С.М. Гайдукова, С.В. Видиборець. — Київ. — 2004.
2. Хірургія / За ред. Я.С. Березницького, М.П. Захараша, В.Г. Мішалова, В.О. Шідловського. — Дніпропетровськ: РВА «Дніпро-VAL», 2006. — Т. 1. — 443 с.
3. Національне керівництво з виробничої трансфузіології для закладів, підрозділів та лабораторій служби крові / А.С. Тимченко, В.В. Яворський, О.І. Малигон та ін. — Харків: Золоті сторінки, 2015. — 336 с.
4. Перехрестенко П.М. Плазма крові донорів: виробництво та використання в Україні / П.М. Перехрестенко, Л.В. Назарчук, Т.О. Терещук // Укр. мед. часопис. — 2010. — № 3. — С. 41–43.
5. Закон України «Про донорство крові та її компонентів» від 23 червня 1995 р.
6. Коваленко А.Б. Качественный подход в получении компонентов крови / А.Б. Коваленко, Ю.Б. Корж // Укр. журн. экстрем. медицины.— 2010. — № 2. — С. 51–62.
7. Правила назначения компонентов крови / Е.Б. Жибурт, Е.Л. Шеагюков, Е.Л. Клюева, А.Т. Коденев, М.Н. Губанова, Л.В.
Караваев // Укр. журн. экстрем. медицины. — 2010.— № 2 — С. 17–19.
8. https://donor.ua/centers/monitor — Моніторинг запасів донорської крові України.

9. Наказ МОЗ України від 19.09.2005 р. № 504 «Про інфекційну безпеку донорської крові та її компонентів».
10. Інструкція з переливання крові та її компонентів. Затв. наказом МОЗ України 05.07.1999. №164.
11. Farrugia, A. Plasma-derived medicines: access and usage issues [Text] / A. Farrugia, J Cassar // Blood Transfus. — 2012. 10. — P. 273-278.

12. https://zakon.rada.gov.ua/laws/show/931-20#Text — Про безпеку та якість донорської крові та компонентів крові.
13. https://phc.rg.ua/promociya-zdorovya/donorstvo-krovi-ta-iikomponentiv/kerivni-dokumenti — Керівні документи.


14. https://xema.in.ua/wp-content/uploads/2020/02/K009IUv2019.06. pdf — Інструкція з використання набору ІФА для виявлення поверхневого антигену HBsAg.
15. https://xema.in.ua/wp-content/uploads/2020/02/K110IU-v-2019.05. pdf — Інструкція з використання набору ІФА визначення антитіл до ВГС.
86 Журнал «Сучасна фармація» • modern-pharmacy.com.ua • 2023 / березень • У світі медицини • Це цікаво
В
ФІОЛЕТОВИХ ОВОЧІВ ТА ФРУКТІВ?

При цукровому діабеті 2 типу споживання
висококалорійної іжі може спровокувати дісбактеріоз
та пошкодження кишкового бар’єру, а згодом спровокувати ендотоксемію, що ще більше посилює резистентність до інсуліну. Окрім генетичної
схильності, нездоровий спосіб життя також сприяє розвитку
цукрового діабету, а здорове харчування є запорукою профілактики та одним із складників комплексного лікування.
Фінські вчені встановили, що червоні, фіолетові та сині пігменти, що містяться у фруктах, овочах та
коренеплодах, і які ще називаються

антоціанами, можуть знизити ризик
виникнення діабету, впливаючи на енергетичний обмін, мікробіоту
кишківника та запалення.
Нова оглядова стаття, у якій порівнюються результати досліджень з
цієї теми, показує, що сприятливий
вплив антоціанів на цукровий діабет 2 типу посилюється, якщо антоціан ацильований, тобто ацильна
група додається до цукрових частин антоціану.
Велику кількість ацильованих
антоціанів можна знайти в фіолетовій картоплі, пурпурній солодкій картоплі (фіолетовому бататі), редисці, фіолетовій моркві та червонокачанній капусті, тоді як чорниця та шовковиця містять переважно неацильовані антоціани. Ацильовані антоціани погано засвоюються при травленні, але вони мають пробіотичні властивості та знижують ризик діабету ефективніше, ніж неацильовані антоціани.
За словами докторанта Канга Чена з відділу харчових наук Університету Турку, дослідження показало, що, окрім зміни фізичних і хімічних властивостей, ацилювання впливає на те, як антоціани поглинаються та метаболізуються.
Ацильовані антоціани є більш ефективними антиоксидантами, ніж неацильовані антоціани, і вони також можуть покращити кишковий бар’єр, що забезпечує засвоєння
необхідних поживних речовин. Крім того, ацильовані антоціани підтримують гомеостаз кишкової мікробіоти, пригнічують прозапальні шляхи та модулюють метаболізм глюкози та ліпідів.
Загалом, фіолетові овочі містять багато ацильованих антоціанів. Крім того, фіолетова картопля, особливо фінський сорт під назвою «Synkeä Sakari», містить велику кількість ацильованих антоціанів та володіє неймовірними корисними властивостями, а також низьким глікемічним індексом в порівнянні зі звичайною картоплею. Ацильовані антоціани подорожують нашим тілом починаючи із верхніх відділів шлунково-кишкового тракту закінчуючи товстою кишкою, де вони метаболізуються мікробіотою. Транспортери глюкози беруть участь у всмоктуванні антоціанів, але різні переносники глюкози відповідають за всмоктування ацильованих і неацильованих антоціанів. Ацильовані та неацильовані
антоціани також мають різний вплив на ферменти, що беруть участь у метаболізмі.
Джерело: https://www.sciencedaily.com



ЦЕ ЦІКАВО
Кілька століть тому почалася одна з найбільш цікавих і гарних історій в біологічній науці – історія вивчення кольору у рослин. Рослинні пігменти антоціани зіграли важливу роль у відкритті законів Менделя, мобільних генетичних елементів, РНК-інтерференції – всі ці відкриття були зроблені завдяки спостереженням за забарвленням рослин.
Перші досліди з вивчення антоціанових сполук і їх хімічної природи провів відомий англійський хімік Роберт Бойль. Ще в 1664 році він вперше виявив, що під дією кислот синій колір пелюсток волошки змінюється на червоний, під дією ж лугу пелюстки зеленіють. У 1913-1915 роках німецький біохімік Ріхард Вільштеттер і його швейцарський колега Артур Штоль опублікували серію робіт, присвячених антоціанам, за дослідження фарбувальних речовин рослинного світу в 1915 році Ріхард Вільштеттер був удостоєний Нобелівської премії з хімії.
ЧОМУ КОРИСТЬ
Журнал «Сучасна фармація» • modern-pharmacy.com.ua • 2023 / березень • У світі медицини • Новини 87
Американські вчені опублікували
результати 2 фази клінічного
дослідження CALERIE і визначили, що
допоможе довше зберігати молодість, здоров’я та красу.
Протягом двох років учасниики дослідження обмежували споживання калорій на 25 %, після чого автори на основі метилювання ДНК оцінювали їхнє біологічне старіння. Алгоритми PhenoAge та GrimAge не виявили змін, але показник DunedinPACE (який розраховує швидкість старіння за сукупністю даних про гени — епігеномом) і відображає швидкість старіння, знизився на 2–3 %. Теоретично це може зменшити ризик смерті на цілих 10–15 %; такого ж ефекту можна
досягти, кинувши палити. Рандомізоване контрольоване дослідження вияви-
ло прямі докази, які суперечать переконанню, що дієтичне втручання не може змінити швидкість старін-
ня людини.
Досліження проводилося під керівництвом Центру старіння Батлера Колумбійського університету
Mailman School of Public Здоров’я. Це перша у своєму роді програма, яка досліджує вплив тривалого обмеження споживання калорій на людей.
У дослідженні взяли участь 220 здорових чоловіків і жінок без ожиріння. Під час набору дослідницька група проаналізувала зразки крові учасників на наявність біомаркерів, які вимірюють, як швидко людина старіє.
Зокрема, вони розглянули
показники PhenoAge і GrimAge, які вимірюють дані метилювання ДНК, також відомі як «епігенетичні годинники». Ці
показники оцінюють біологічний вік і можуть свідчити про те, наскільки старіло тіло. Крім того, команда також
виміряла DunedinPACE — показник того, наскільки швидко відбувається біологічне старіння.
Потім учасники були рандомізовані на 2 групи: частина з них мала звичайну дієту, решта була переведена на дієту зі споживанням калорій на 25 % нижче базового рівня людини (з урахуванням її віку, ваги тощо). Команда вчених брала аналізи крові учасників до дослідження, через 12 та 24 місяці відповідно. Дослідники проаналізували мітки метилювання на ДНК, виділеній з білих кров’яних клітин (лейкоцитів). Мітки метилювання ДНК — це хімічні мітки на послідовності ДНК, які регулюють експресію генів і, як відомо, змінюються з роками.
Проаналізувавши дані, вчені виявили, що обмеження калорій уповільнює швидкість, з якою учасники дослідження старіють. Найкраще це підтвердив показник DunedinPace. Однак, згідно з показником GrimAge, обмеження калорій лише помірно відстрочило старіння.
Спостереження за учасниками експерименту продовжується, щоб зрозуміти, чи транслюються короткострокові ефекти, що спостерігаються, в довгострокову зміну ризиків розвитку «вікових» хронічних захворювань. Але загалом отримані результати поки що підтверджують той факт, що уповільнити старіння людини можливо, у тому числі за допомогою змін характеру чи режиму харчування. Поруч із обмеженням калорій, вчені планують дослідити в майбутньому також вплив інтервального голодування.

Джерело: https://www.sciencedaily.com




ОБМЕЖЕННЯ КАЛОРІЙ
УПОВІЛЬНЮЄ
ТЕМПИ СТАРІННЯ
88 Журнал «Сучасна фармація» • modern-pharmacy.com.ua • 2023 / березень • У світі медицини • Цікаво